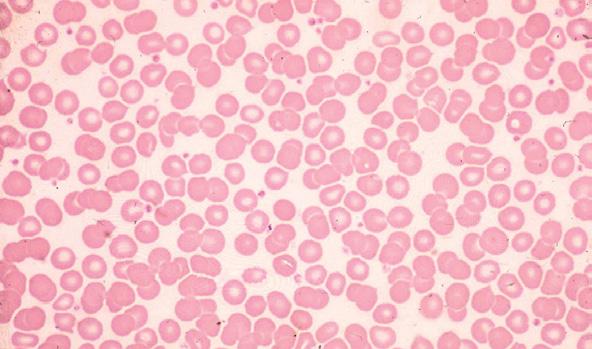

24-Hour BOWEL Detox
BOWEL Detox
LIVER Detox
KIDNEY Detox
Doctor/Patient
5-Day
5-Day
5-Day
Detoxification A Clinical
Manual
Richard Schulze
by Dr.
VOLUME TWO
Published by Natural Healing Publications
P.O. Box 9459, Marina del Rey, CA 90292 1-877-TEACH-ME (832-2463)
© Copyright 2011 Natural Healing Publications
1st Edition. All Rights Reserved.
When people misrepresent, misquote and dilute Dr. Schulze’s message, programs and herbal formulae, the programs do not work and people do not get well. Therefore, to protect the public, Natural Healing Publications is serious about prosecuting copyright violators.
At no time may any person or entity copy any portion of this book or incorporate any portion of this work into any other work to the public, without the written permission of Natural Healing Publications. These prohibitions apply equally to electronic and hard copies of this protected work. These prohibitions also apply to the Internet.
Library of Congress Catalog
Card Number: Pending
Detoxification: A Clinical Doctor/Patient Manual Volume Two
ISBN: 978-0-9835087-1-7
PRINTED IN THE USA ON 100% CHLORINE AND BLEACH-FREE
RECYCLED PAPER, WITH MINIMUM 30% POSTCONSUMER WASTE (REALLY RECYCLED WASTE), USING SOY-BASED INK.
Detoxification:
A Clinical Doctor/Patient Manual Volume Two
by Dr. Richard Schulze

“Tomorrow is what you BELIEVE and DO Today!”
— Dr. Richard Schulze


CONTENTS CHAPTER 1 24-Hour Bowel Detox 1 Food Poisoning 1 Other Poisoning 2 Consumption of Toxic Food 3 Food-Related Illness and Death in the United States 4 24-Hour BOWEL Detox 7 Bowel Flush “SHOT” 8 Dr. Schulze’s Bowel Flush “SHOT” To The Rescue! 8 Digestive “SHOT” 9 Digestive Tonic 11 HerbalMucil Plus 13 INTRODUCTION TO Bowel Cleansing 17 Modern Medicine 17 Disease Cover-up And Healing Illusion 17 Natural Healing 19 True Healing That Creates Powerful And Lasting Health 19 My Natural Healing Masters, Teachers And Patients 22 Colon Cleansing 22 Training And Experience 22 Colon Cleansing Is Just Not “Cool” Anymore 24
I Did Things A Little Differently 26 The Bottom Line… Pun Intended. 28 Your Colon: A Basic Understanding Of How It Works Could Save Your Life! 30 CHAPTER 2 Bowel Anatomy and Physiology 101 31 The 30-Foot Long Journey 31 The Digestive And Elimination Tract 32 The Esophagus 32 The Stomach 32 The Small Intestine 33 The Large Intestine 34 The Average American Colon, The Perfect Colon 36 CHAPTER 3 Colon Disease And Colon Cancer: 37 What Causes 100% Of Americans To End Up With Colon Disease? 38 Look What They Put In Their Bodies! 38 The Latest Medical Statistics 38 Let’s Check What The Top Medical Doctors Say 40 Every American Eventually Has Diverticulosis Or Has Many Diverticula! 40 Up To 50% Of Americans Have Polyps In Their Colon! 40 CHAPTER 4 Dr. Schulze’s Clinic: The Early Years 43 CHAPTER 5 Constipation: The Shocking Truth 49 How Bad Can It Get? Constipation Record Breakers 49 What The Heck Is A Normal Poop, Anyway? 50 Normal Frequency 50 Normal Consistency 51 Signs of Constipation 51
A 5-Foot Long Fecal Impaction 52 Parasites 53 CHAPTER 6 Healing Colon Disease Naturally 55 Bowel Cleansing Can Be The Cure For Any Digestive Disease 56 How Could So Many Seemingly Unrelated Health Problems Be Caused By Constipation? 60 Clinical Depression Healed 63 Never, Never, Never Underestimate The Power Of Colon Cleansing 63 Natural Healing Is Not About Dr. Schulze Healing People. It’s About… People Healing Themselves 64 My Patients Thought I Was Father Schulze, Not Dr. Schulze 64 First Things First! 65 CHAPTER 7 The Solution: Dr. Schulze’s 5-Day BOWEL Detox 67 A Powerful, Effective And Complete Cleansing Program For The Colon 67 How To Begin: 67 Important! 69 Important Helpful Tips 70 Tip #1: Educate Yourself 70 Tip #2: Don’t Be In A Hurry 70 Tip #3: Special Advice For People With A “HOT” Metabolism 70 Final Note 70 The 5-Day Detox Food And Juice Program 72 Intestinal Formula #1 74 Intestinal Formula #2 75 CHAPTER 8 Additional Products 79 Intestinal Formula #3 79 Children’s Dosage: 81 About The Herbs In This Formula: 82
CHAPTER 9 Six Natural Ways to Get Your Colon Working Again 85 CHAPTER 10 All About Diarrhea 89 What Causes Diarrhea? 89 What Is Going On In Your Body? 91 Natural Cures for Diarrhea 94 CHAPTER 11 Is Your Appendix Necessary? 97 What Is Appendicitis? 98 Dr. Schulze’s Appendicitis Remedy: 99 Step 1: Stop Eating Now! 99 Step 2: Get the Garbage Out... Fast! 99 Step 3: Take Intestinal Formula #1 100 Step 4: Do Some Body Work! 100 Final Thoughts 101 CHAPTER 12 Frequently Asked Questions 103 What is the food program while doing your 5-Day BOWEL Detox? 103 What if I am afraid of doing the program? 104 What if I experience cramping while on the cleanse? 105 I’ve tried other colon cleanses and they didn’t work. How do I know yours is going to work? 106 How many times should I do your 5-Day BOWEL Detox? 107 Should I do the 5-Day BOWEL Detox while doing either the 5-Day LIVER Detox or 5-Day KIDNEY Detox? 107 Can I still do the 5-Day BOWEL Detox if I’m pregnant or nursing? And if I’m nursing, is it harmful to the baby? 108 Can I take Intestinal Formula #1 indefinitely? 109 What is the dosage for Intestinal Formula #1? 110 I’ve already worked up to a high number of the Intestinal Formula #1 and I’m afraid to take more. What do I do? 111

I’m having two to three bowel movements a day, but not thirty minutes after each meal like you suggest. Is this OK? 111 If I’m having a bowel movement thirty minutes after a meal, isn’t that too fast for all this food to be moving in and out of me? 112 I’m experiencing a lot more gas when I use your Intestinal Formula #1. Is that OK, or am I allergic? 112 Why can’t I continue having regular bowel movements when I stop taking the Intestinal Formula #1? 113 Can I start taking the Intestinal Formula #2 right away? 114 Why does Intestinal Formula #2 constipate me? 115 Do I have to consume the whole bottle OR BOX OF PACKETS of Intestinal Formula #2? 115 I’m taking your Intestinal Formula #2, but isn’t this black drink a bit radical? 115 If I have Crohn’s disease or Colitis or Irritable Bowel Syndrome, how do I approach the cleanse? 117 Is it constipation that causes a fecal encasement? 117 Do I need to be taking acidophilus? 118 Are there things you eat that actually stay in your colon for years and years? 119 How can an herb stimulate a sluggish bowel that’s been a chronic problem? 119 INTRODUCTION TO Liver Cleansing 123 Feel More Alive With A Healthy Liver 123 Your Ultimate ENERGY Organ 123 Your Ultimate DETOXIFICATION Organ 124 Create an Energized, Healthy and Long Life 124 Why Do We Need To Clean And Flush Our Livers? 125
CHAPTER 13 Why Cleansing Your Liver Is Vital 127 Prevent Disease And Protect Your Liver NOW! 129 The #1 and #2 Causes Of Death In America Are Directly Linked To The Liver. 129 #1: Heart Attacks And Strokes Are Caused by High Cholesterol 130 #2: Cancer Is Caused By Environmental Toxins And Poisons 131 CHAPTER 14 A Daily Dose of Poison: Modern Life in America 135 There Is No Escape. 135 What Can You Do? 135 You Say You DON’T EAT Or DRINK POISON? 136 The Shocking Truth 139 The Average American’s Home Is Really A Toxic Gas Chamber. 141 Poison Medicine 143 Are Over-The-Counter Drugs Safe? 146 Your Liver And Gallbladder 148 CHAPTER 15 Anatomy and Physiology of the Liver and Gallbladder 149 The Liver 149 Energy And Nutrition: 150 Detoxification: 151 Diseases Of The Liver And Gallbladder 152 Jaundice: When Your Liver Gets Sick. 153 Diseases Of The Liver 154 Intra Hepatic Jaundice 155 Viral Hepatitis 155 Extra Hepatic Jaundice 156 Hepatitis-C And Other Viral Ailments 157
Dr. Schulze’s Healing Program For Hepatitis 160 Diseases Of The Gallbladder 161 The Gallbladder 161 CHAPTER 16 Keeping Your Liver Clean And Healthy 163 What I Learned In My Clinic… 164 You Are A Very Busy Person! 164 Why Do A Seasonal Cleansing? 165 What If You Could Add 10 Years To Your Life…B y Just Doing A Simple Cleanse A Few Days A Year? 165 And I Know That You’ve Heard, “This Guy’s Tough” And That My Programs Are Even Tougher. 166 But…The Program In This Book Is Not Tough! In Fact, It’s Very Simple, Easy And Fast! 167 CHAPTER 17 The Solution: Dr. Schulze’s 5-Day LIVER Detox 171 5-Day Detox Daily Routine: 173 How To Make Dr. Schulze’s 2-Minute Liver/Gallbladder Flush Drink 174 Shopping List For Dr. Schulze’s Liver/Gallbladder F lush Drink 176 Real People. Real Results. 177 How To Make Dr. Schulze’s Detox Tea 178 Emergency: Gallbladder Attack Treatment 179 A Letter From A More “Enlightened” Doctor About Dr. Schulze’s 5-Day DETOX Program. 182 CHAPTER 18 Dr. Schulze Describes his Herbal Formulae 185 L-GB Formula 185 Detox Tea 187 Detox Formula 190

CHAPTER 19 Final Thoughts On Liver Detoxing 193 CHAPTER 20 Frequently Asked Questions 197 How many times a year should I do the cleanse, and how long should I stay on the formulas when I’m cleansing? 197 Do I need to reserve special days for doing my cleanse? 197 Is Juice Flushing mandatory? 198 Can you modify the 5-Day LIVER Detox? 199 Do you suggest doing the Detox Formula along with the 5-Day LIVER Detox? 199 What are the benefits of taking Intestinal Formula #1 and #2, while doing the 5-day LIVER Detox? 200 How do I improve my digestion after I’ve done your 5-Day LIVER Detox? 200 Can I really flush the stones out of my gallbladder and avoid having it removed? 201 Which 5-Day detox should I do first, the Liver/Gallbladder CLEANSE or the Kidney/Bladder? 201 Will I get better results doing a liver purge, like the ones that use epsom salts and olive oil? 202 Have you heard the studies linking Tylenol with liver cancer? 202 What do you think about chelation treatments? 203 What if I’m diabetic, or if I don’t have a gallbladder, or if I have Hepatitis B? Can I still do the cleanse? 203 INTRODUCTION TO KIDNEY Cleansing 205 Assimilate and Eliminate 205
CHAPTER 21 Kidney And Bladder Disease: 209 The Preventable Epidemic 209 The Urinary System Simplified 214 CHAPTER 22 Anatomy And Physiology Of The Kidneys and Bladder 215 Normal Kidney 216 Normal Kidney 216 Kidney Nephron 217 Normal Blood 218 How It All Works 219 Diagnosis Of Urinary System Disease 221 The “Amount” Of Urine 221 The “Look and Smell” Of The Urine 221 CHAPTER 23 The Problem: Kidney And Bladder Disease 223 Diseases That Cause Urinary System Breakdown And Illness 223 Toxemia 223 Hyper-Cholesterolemia & Hypertension 224 Death Row Dialysis 225 Diabetes 225 Normal Kidney, Diseased Kidneys 226 The Bottom Line On Any Kidney, Bladder Or Urinary System Disease 227 Diseases Of The Kidney 228 Different Kidney Stones 229 Kidney Stones 229 Diseased Kidney 231 If You Don’t Want Rocks And Gravel In Your Kidneys, Stop Eating Rocks And Gravel 232
Apples: The Dissolver Of Calcium And Uric Acid Stones A Dr. Schulze Demonstration 233 Diseases Of The Bladder 234 Bladder Infections: The Statistics 235 Ancient Healing Wisdom Blows Away Modern Technology 236 CHAPTER 24 The Solution: Dr. Schulze’s 5-Day Kidney Detox 239 How To Do Dr. Schulze’s 5-Day KIDNEY Detox 240 5-Day Detox Daily Routine 241 How To Make Dr. Schulze’s 2-Minute Kidney/Bladder Flush Drink 242 Kidney Stone Dissolving Routine 243 Dr. Schulze’s Kidney Stone Dissolving Formula Ingredients 244 Patient Case History 245 The 5-Day Detox Food And Juice Program 246 CHAPTER 25 Dr. Schulze Describes His Herbal Formulae 249 K-B Formula 249 Metabolic Action And Botanical Chemistry 250 K-B Tea 251 Metabolic Action and Botanical Chemistry 252 How To Make K-B Tea 252 Detox Formula 253 Metabolic Action And Botanical Chemistry 254 CHAPTER 26 Final Thoughts On Kidney Detoxing 257 CHAPTER 27 Frequently Asked Questions 259 The color of my urine used to be bright yellow. Now it’s sort of a yellowish-orange. Is that normal, or does it mean something’s wrong? 259 What is the normal amount of urine one should eliminate every day? 260
I suffer from chronic bladder infections. A friend told me that bladder infections can be caused by holding your bladder for too long and can also lead to more serious problems. Is this true?
I have had chronic kidney infections my whole life.
your program really help?
Recently I have been having a terrible time holding my bladder. I understand this happens with old age but I refuse to start wearing diapers. Is there anything I can do about it, or is it too late?
way down in my
261
Can
263
264
have a kidney
lodged
Will your kidney flush dissolve it? 265 What do hyper-cholestemia (high cholesterol) and hypertension (high blood pressure) have to do with kidney disease? 265 What is diabetes, and HOW does it affect the kidneys? 266 Can I really get off dialysis, even though my second kidney has given out? Is there any way I can recover? 267 What should I do to prepare for my program? 268 Can you modify the Kidney/Bladder cleanse? 269 Which should I do first, the Liver/Gallbladder or the Kidney/Bladder flush? 270 What kind of supplies do I need to get for the cleansing? 271 Is Juice Flushing mandatory? 272 Dr. Schulze’s “Detoxification: A Clinical Doctor/Patient Manual” is a three volume series… 275
I
stone
urethra.


CHAPTER 1
24-HOUR
BOWEL DETOX
(USING INTESTINAL FORMULAS #1 AND #2)
Also including the Bowel Flush “SHOT”, Digestive “SHOT”, Digestive Tonic and HerbalMucil Plus…
Anyone who has done my 5-Day BOWEL Detox knows the 24-Hour BOWEL Detox is a one-day version of my 5-Day BOWEL Detox. It originated out of emergency needs in my clinic.
Almost daily, I would get a “distress call” from a patient that had what most refer to as a “stomach virus” or “stomach flu” or a “24-hour stomach bug” or simply “food poisoning”. The name doesn’t sound so bad, but the illness is extremely painful and TOTALLY debilitating. Most everyone can remember having had food poisoning. It is usually one of the worst experiences they have ever had, from projectile vomiting to excruciating stomach cramps or sharp pains like being stabbed with a knife to explosive diarrhea. It’s not fun at all and just about everyone gets this infection or poisoning from time to time.
If you follow my advice, and have some of these herbal formulas on hand in your medicine cabinet, you can turn this horrible illness into a very minor problem, or maybe no problem at all, especially if you treat it early enough.
Food Poisoning
For the most part the cause of my patients “stomach illness” was food poisoning. ANY food can be contaminated with a number of disease causing pathogens like virus, parasites, but more often than not it is simply the food having too high of a bacteria count, or being exposed to bacteria by employees not following the “Wash
1
Your Hands” signs in the bathroom, or even being contaminated by farm workers. In many countries, the vast majority of food poisoning comes from flies that have been eating human and animal waste. They then carry this e.coli bacteria to your food, land on it (infecting the food), and then you consume the food. Although this is mostly thought of happening only in Mexico, India or third world countries, unfortunately this happens all the time in America, too.
Although food poisoning is most often caused by eating contaminated animal food—like meat, fish, seafood, eggs and dairy products—you vegans are not immune, as this bacteria has even been found on lettuce, sprouts and a hundred different vegetables. This underscores the importance of washing any produce before consuming it, even if it is organic.
Another source of food poisoning is actually from water, which can be contaminated in exactly the same way with everything from bacteria and virus to parasites, and contaminated water causes more illness worldwide than does food.
For more information on food poisoning and diarrhea, go to Chapter 10: All About Diarrhea.
Other Poisoning
There are many other ways to be poisoned besides bacteria and pathogens, like simple chemical poisoning ”All About Diarrhea” on page 89.
One way can be from your dentist, by having old amalgam or mercury fillings removed. While most dentists today are extremely careful while removing this highly toxic material, and even put latex “dams” over your mouth to keep you from swallowing any of this heavy metal, it is almost impossible not to ingest some of it, hence I would always advise my patients to do at least a 24-Hour BOWEL Detox after having most dental procedures, simply to remove any contaminants that you have swallowed. This Detox
2 24-Hour BOWEL
Detox
will encapsulate the contaminants and flush them out of your body so that they can do you no harm.
And since more than half of all fish and seafood today has toxic levels of mercury in it, along with many other heavy metals, and the vast majority of antibiotics used today are used on food animals and not on humans, and since massive amounts of steroids and growth hormones are used in the manufacturing of everything from beef to dairy products… do I really have to continue? You might consider using my 24-Hour BOWEL Detox as a standard decontamination process after ingesting this type of food.
You can also ingest toxic chemicals and contaminants just by breathing them into your mouth. So, if you have been in ANY toxic or dirty environment, the 24-Hour BOWEL Detox is a great way to get any poisons out of your digestive tract, bowel and body.
Consumption of Toxic Food
Many of my patients simply thought that I was Father Schulze, and they used this detox to cleanse themselves of their food sins. Look friends, the only thing worse than eating toxic food or junk food, is then absorbing and assimilating it into your body and bloodstream. So, if you did eat that carcinogenic steak or had three pieces of the birthday or wedding cake, get rid of it!
If you fell actually leaped off of your healthy food program, at the least, render what you consumed as harmless as possible by minimizing your absorption of it and also minimizing the time this junk stays in your body. And the best way to do this is by not only doing my 24-Hour BOWEL Detox, but also using my Bowel Flush “SHOT” before you go to bed, to make absolutely sure that by the very next day, EVERYTHING you ate will be out of your body.
So whatever the reason may be… a trip to the dentist, that “uh oh” feeling in your stomach after a meal at a strange restaurant or
3
24-Hour BOWEL Detox
Taken from the Center for Disease Control’s website...
Food-Related Illness and Death in the United States
Foodborne diseases in America cause up to:
� 81 million illnesses annually
� 325,000 hospitalizations
� 9,000 deaths
There are more than 200 known diseases that are transmitted through food. The causes of foodborne illness include viruses, bacteria, parasites, toxins, metals, and prions (like bovine spongiform encephalopathy, BSE, also known as “mad cow disease”).
The symptoms of foodborne illness range from mild gastroenteritis to life-threatening neurologic, hepatic, and renal syndromes.
after eating strange food, a vacation to a foreign country, a family reunion picnic, eating greasy and fatty, hard to digest animal food or Aunt Betty’s two day old shrimp macaroni salad, whatever—it is better to be safe than sorry and encapsulate the toxins, absorb the bacteria or the heavy metals, draw out toxic chemicals, neutralize and render anything harmless that can hurt you and get it out of you.
For this reason, I told all of my patients to do my 24-Hour BOWEL Detox whenever they suspected contamination or poisoning, and to have it on hand at home so when they need it, they have it, and to throw it in their suitcase, whenever they went on a trip, whether home for the holidays or to the other side of the world. Don’t leave home without this detox!
4 24-Hour BOWEL Detox
Another herbal formula that can really eliminate the suffering and assist in the rapid recovery from food poisoning is the Digestive “SHOT” and also the Digestive Tonic.
The Digestive “SHOT” is my clinical professional strength dose of my Digestive Tonic with the addition of the powerful natural fruit digestive concentrates of papaya (which contains papain enzyme) and pineapple (which contains bromelain enzyme).
This formula will stop the Nausea, relieve the Acid Reflux, Acid Indigestion, Heartburn, Cramps, and Move and Eliminate painful Trapped Gas. It will also supercharge your ability to break down foods to be eliminated.
The Digestive Tonic does all of these same things except it does not contain the fruit concentrate enzymes to break down the food, but still has the same action and ability for Nausea, relieving the Acid Reflux, Acid Indigestion, Heartburn, Cramps, and to Move and Eliminate painful Trapped Gas.
These two formulas, used in addition to the 24-Hour BOWEL
Detox, not only promote rapid healing, but also greatly help to eliminate most of the discomfort of being poisoned.
HerbalMucil Plus is the antidote for diarrhea, soothing the entire gastro-intestinal tract. When you have any food poisoning, from any cause, or whenever your body detects you have any poison or infection in your digestive tract, it causes you to have numerous bowel movements, if not diarrhea. This is your body’s natural protective action to get this poison out of you as quickly as possible. Normally, one of the jobs of your colon is to extract liquid from your fecal mater, so your feces goes from a semi-liquid state, to a semi-solid state to be eliminated in your bowel movements.
But also, in your colon or bowel, you have numerous immune system receptor sites, which are part of your immune system’s surveillance ability, watching over your digestive system. They are
5 24-Hour BOWEL Detox
called lymphoid aggregations or aggregated lymphoid nodules, which are very similar to your tonsils and adenoids. They are located in your small intestine (called the Peyer’s Patches) as well as in your appendix, which is also a lymphoid aggregation. When these immune surveillance receptor sites detect that you have been infected with poison, they immediately put your bowel into overdrive, so any poison is eliminated IMMEDIATELY! We call this diarrhea. It is your body’s natural protective response to get any poison out of you ASAP, because if it was to remain in you any longer, it could kill you.
Modern medicines response to this is typical; STOP the body from doing what it wants to do to PROTECT YOU! So medical doctors will give you opiates or similar substances or chemicals, that slow down your bowel, actually paralyze it, and STOP the diarrhea—again, to STOP what your body is trying to do to PROTECT YOU! This is not only very wrong, but it is very dangerous and will cause the bacteria or infection to grow out of control. You will feel a lot more comfortable for a few hours as your diarrhea subsides, but as the bacteria grows back, you will eventually have a relapse and the disease and diarrhea will come back with a vengeance.
A much more enlightened response to diarrhea, that assists your body in what it is trying to do, would be to use my HerbalMucil Plus, in addition to the Intestinal Formula #2 you are already taking in the 24-Hour BOWEL Detox. Both of these herbal formulas will mix with your liquid feces so when you have a bowel movement it will make it more gelatinous and more formed. This will be a lot more comfortable for you, but at the same time, IT WILL NOT SLOW YOUR BOWEL DOWN! SO YOU GET THE POISON OUT. Your bowel keeps working as fast as it needs to, to get the poisons out of you fast, but at the same time your feces is not liquid, which is much more comfortable for you.
In addition, the herbs in Intestinal Formula #2 will absorb the bacteria, virus, poisons, toxins or whatever is that is causing the diarrhea and render it harmless. Also the herbs in the
6 24-Hour BOWEL Detox
HerbalMucil Plus are soothing and anti-inflammatory to the mucous membrane lining of your entire digestive tract, which gets very beat up, torn up, irritated and even raw and bleeding, by the bacteria or the poison. So, this formula starts the healing immediately. Together these two formulas are the best medicine for diarrhea, regardless of what it has been caused by.
24-Hour BOWEL Detox

� Quickly and easily removes dangerous micro-organisms and keeps them out of your body, stomach and bloodstream
� A powerful one-day detox that captures, neutralizes and eliminates toxins in your bowel
PROGRAM INCLUDES:
6 Intestinal Formula #1 & 50 Intestinal Formula #2 capsules
DOSAGE:
Take 10 capsules of Intestinal Formula #2, five times daily. You must drink a minimum of 16 ounces of liquid with or immediately after each dose. In the evening, take 1–2 capsules of Intestinal Formula #1 with dinner. Note: If you are skipping days without having a bowel movement, take 2–6 capsules of Intestinal Formula #1 with dinner.
7 24-Hour BOWEL Detox
Bowel Flush “SHOT”

� PROMOTES regular, healthy and complete bowel movements
� ENSURES a complete emptying of your bowel and digestive system by the following morning
HERBAL INGREDIENTS:
Dr. Schulze’s Proprietary Cathartic Formulae: Senna Leaf & Pod, Cascara Sagrada Aged Bark, Dr. Schulze’s Proprietary Carminative Formulae: Hawaiian Yellow Ginger Root, Peppermint Leaf & Oil, Anise Seed, Dr. Schulze’s Proprietary WormEx Formulae: Agrimony Herb, Black Walnut Hulls, Cinchona Bark, Clove Bud, Goldenseal Root Thyme Leaf in a base of Organic Prune & Fig Concentrate, Tangerine Oil
After three decades in my clinic and tens of thousands of patients, I learned a few things. The first is, we are not perfect. Maybe your day started with a bad breakfast, doughnuts, pancakes, or bacon and eggs, all of which you know you shouldn’t eat. You grab a junk food lunch on the run or a candy bar and a cup of coffee. For dinner, you were out of control and ate a half of loaf of bread, before your dinner even arrived. Then, you ate the surf and turf and the Crème Brulee. All you ate today was grease, fat, sugar, calories, cholesterol, free radicals, heavy metals, toxic chemicals and toxic food and now, you’re exhausted, bloated, guilty, sick to your stomach and literally full of crap.
8 24-Hour BOWEL Detox
Dr. Schulze’s Bowel Flush “SHOT” To The Rescue!
Now, you can eliminate your digestive nightmare and relax and get a good night’s sleep. And first thing in the morning, all of this garbage will be out of you. This new herbal “SHOT” is for those times when we overindulge, eat food we know we shouldn’t or just eat too much. Whether it was Mom’s famous meatballs, Dad’s backyard barbeque, Aunt Betty’s cookies, a friend’s “potluck” or simply a night out of fast food, junk food, greasy food or mystery food. Look, its bad enough what you ate and how much you ate, but let’s not suffer anymore. STOP beating yourself up and let’s just get it out of you and START over.
DOSAGE:
Drink entire contents straight. Chase with apple or grape juice, if necessary. We suggest to take after dinner. Shake well before using.
Digestive “SHOT”

� STOPS indigestion, heartburn, gas, nausea and stomach upsets immediately
� PREVENTS digestive disturbances
� PROMOTES better digestion
� ELIMINATES the discomfort that sometimes comes with traveling and motion
9 24-Hour BOWEL Detox
HERBAL INGREDIENTS:
Dr. Schulze’s Proprietary Digestive Formulae: Hawaiian Yellow Ginger Root, Peppermint Leaf & Oil, Fennel Seed. Dr. Schulze’s Proprietary Digestive Enzyme Formulae: Papaya Purée With Enhanced Papain Enzyme, Pineapple Purée & Bromelain Enzyme
My new Digestive “SHOT” contains 10 droppersful of my Digestive Tonic—and this is the amount I would have given you if you came to my clinic with a digestive disturbance, like gas, bloating, indigestion…anything. You’ll notice it when you take it that it’s POWERFUL and it WORKS. It’s a “WOW!”
This “SHOT” is to be used on an as needed basis, taken before a meal to assist, aid and promote better digestion and after a meal or before bed to prevent any digestive disturbances.
This herbal complex contains the three most powerful “digestive aid” herbs known: Peppermint Spirits, Ginger Rhizome and Sweet Fennel Seeds. PLUS, I added my enhanced Papain Papaya puree, and also enhanced Bromelain Pineapple puree. Both Papain and Bromelain are powerful digestive enzymes. Together, they help break down food, while your body is trying to also break down the food in your digestive tract. They almost pre-digest the food for you.
This is a good tonic to have on your nightstand for those times when you go out and have a lunch or a dinner that didn’t agree with you. It would be a great idea to take the entire “SHOT” before you go to bed. If you didn’t and you wake up in the middle of night with that horrible burning in your throat, well, take the “SHOT” now. You can take it either before bed or if you wake up in trouble. Shake it up, and take the entire “SHOT”, and what you’re going to notice is you’re going to be able to go right back to sleep.
DOSAGE:
Drink entire contents straight. We suggest to take after any meal, especially after dinner or if waking up at night. Shake well before using.
10 24-Hour BOWEL Detox
Digestive Tonic

� STOPS indigestion, heartburn, gas, nausea and stomach upsets immediately
� PREVENTS digestive disturbances
� PROMOTES better digestion
� ELIMINATES the discomfort that sometimes comes with traveling and motion
� Freshens breath
� Great for kids with sensitive digestion
BOTANICAL INGREDIENTS:
Ginger Rhizome, Sweet Fennel Seed, Peppermint Leaf & Peppermint Essential Oil
In this formula, I combined three of the most effective and powerful carminative herbs, Jamaican Ginger Rhizome, Sweet Fennel Seed and Peppermint Leaf and Essential Oil. These three herbs make a powerful tonic that relieves gas, cramps, colic, bloating, heartburn, indigestion, nausea and pain in the digestive tract, especially the stomach. This is the greatest formula for anyone who has any digestive problem.
11 24-Hour BOWEL Detox
1 ounce
Ginger Rhizome, Sweet Fennel Seed and Peppermint Leaf all contain essential oils that, according to medical texts and even the Merck Index, are therapeutically carminative, which means they stimulate the digestive system, as well as relax the stomach, thereby supporting the digestion and helping relieve gas in the digestive tract. Ginger is a powerful anti-emetic (reduces nausea and relieves or prevents vomiting), while Peppermint is an effective gastric sedative and antispasmodic.
This is a great formula for when you wake up in the middle of the night with acid reflux, indigestion or heartburn. A few droppersful of this formula in a little water and in five minutes your indigestion will be gone, and then it’s back to dreamland.
When you are out and you eat that meal that feels like a rock in your stomach, this formula will be a Godsend. You can even add a few droppersful to a cup of hot water and make a tasty digestive tea.
Also, when traveling, this is the greatest formula for motion sickness. I know, because I have traveled all over the world on all types of transportation. From jumbo jets through storms over the North Atlantic and hovercraft across the turbulent English Channel and North Sea to rickshaws in India and swaying camels in North Africa, I have been on some very bumpy, swaying, and shaky rides. I always bring along my Digestive Tonic and ride it out with a smile.
DOSAGE:
15 drops in 2 ounces of water 2 to 4 times daily.
12 24-Hour BOWEL Detox

� PROMOTES Easy Bowel Movements
� RELIEVES Constipation and Maintains Regularity
� DETOXIFIES and CLEANSES the Entire Gastro-Intestinal Tract
HERBAL INGREDIENTS:
Organic Psyllium husk, Organic Psyllium seed, Organic Marshmallow root, Organic Slippery Elm bark, Organic Aloe Vera leaf
After our food is digested in the stomach, and then nutrients are assimilated in the small intestine, it then moves on to the large intestine (also called the colon or the bowel). One of the functions of the bowel is to remove water from this semi-liquid digested food waste that is entering it. This semi-liquid waste is like thick soup or applesauce, but it is not fecal matter yet. The bowel or large intestine then removes much of the water and liquid from this food waste and forms it into fecal matter to be eliminated.
If the person did not consume enough liquid during the day (as most people don’t), or even if they did, as they age, the bowel slows down and draws so much water out of this waste that it becomes too dried out and too hard. When the fecal matter is too dry and hard, it makes it very difficult, if not impossible, for it to be
13 24-Hour BOWEL Detox
HerbalMucil Plus
eliminated. This is often one of the major causes of constipation, and eventually colon and rectal disease.
DOSAGE:
First, pour two ounces of pure water into an 18-oz (or larger) sports bottle. Next, add 1 rounded teaspoon of HerbalMucil Plus powder, eight ounces of fruit juice and six ounces of pure water. Shake vigorously for 10 seconds until well mixed and drink immediately. Afterward drink an additional four to six ounces of liquid.
14 24-Hour
BOWEL Detox



INTRODUCTION TO BOWEL CLEANSING
Any sick and diseased person who seeks out cures from medical doctors, drugs and hospitals is attempting to buy the appearance of health, not earn true health.
Modern Medicine
Disease Cover-up And Healing Illusion
So-called “Medical” cures are actually illusions that may give the false appearance of health, but they are actually cover-ups, bandaids, crutches and make-up. Neither the patient nor their doctor are correcting the real cause of their disease.
Instead, the doctor and patient come up with a treatment plan, usually the swallowing of very powerful chemical pills, that will relieve symptoms, chemically alter your metabolism and maybe even kill the disease. Although this often appears to be a cure, the underlying cause of the illness (or what made them sick in the first place) was not addressed. The patient was not asked to change the faults in their lifestyle that created the disease initially. Since the cause of the disease was not dealt with or eliminated, the sickness continues to grow and flourish within them, often unnoticed at first, underneath this medically induced illusion of health. But eventually, sooner or later, it resurfaces with a vengeance.
A perfect example of this is the way medical doctors currently treat cancer… attempting to cut, burn and poison the cancer out of your body, but never addressing or correcting why you got
17
Introduction To Bowel Cleansing
it in the first place. This is why the horrifying medical statistics state that, after cancer treatment, the chances are your cancer will return in less than five years.
One of a thousand other examples of this medical illusion is that no one who takes insulin for diabetes is curing and healing their pancreas. In fact, just the opposite. As they become addicted to that drug their pancreas gets sicker, rots and eventually dies. The same is true for EVERY pharmaceutical drug made. Drugs chemically alter organs, cells and the normal function of your body to make it appear to run normally when it is actually still very sick. Often, drugs are used to allow you to continue to hurt yourself and make yourself sick. This is obviously apparent from the ads: eat anything you want and still enjoy mamma’s cooking without indigestion, just swallow a few pills. While this deception is going on, you appear to be healthy, while all the time your sickness grows, gets worse and eventually kills you.
Why do people do this to themselves? Why has this system of medicine flourished? It is quite simple. Most people that walked into my clinic were just like numb, dazed drug addicts when it came to how they lived their lives. They were addicted chemically, physically, emotionally and spiritually to everything from sugar, fast food, coffee and alcohol to sitting on their ass watching television that reinforced their unbalanced, insecure, mundane, dysfunctional, angry, fearful and diseased existence. The average American is following a feverishly paced destruction of their body, mind and spirit, numbing and killing themselves at every opportunity. The average American is the perfect stooge to Corporate America’s gigantic junk food industry. The Average American is the perfect junkie to America’s multi-trillion dollar drug and medicine business. The Average American is drugged, stoned, hypnotized, mesmerized, paralyzed and addicted to the American way of life, more precisely, to the American way of disease, drugs and death.
So, the average patients who walked into my clinic didn’t want to change; they resisted it, hated it, were afraid of it... and only when
18
numerous attempts at medical treatment eventually failed them, only when they were in such pain that the drugs could no longer squelch it, only when they were told that death was imminent, and only when their fear of disease, pain and death would become so strong that it would override their fear of change, would they drag themselves begrudgingly into my clinic door. After all, who would voluntarily inflict on themselves the horrifying depravation and torture that most people think is necessary to heal disease naturally and build lasting health.
For the elite of my patients, the professional disease masters who burnt the candle at both ends, lived life in the fast lane, partied hearty and had committed a continuous barrage of self-inflicted lifestyle beatings and assaults on themselves for 20, 30 or 40 years, at first it seemed sure that my frightening suggestions of fruit juices, raw vegetable salads and whole grains instead of cheeseburgers, french fries and milkshakes would certainly kill them. But very soon, they started feeling the power of health, energy and vitality which far exceeded the short-lived rush of sugar, caffeine, alcohol, cocaine and fast food. Soon, they started feeling the rush of nutrient-rich and clean blood circulating to their brain, which far surpassed any chemical-induced rush. Soon, even the most debauched of my patients became as addicted to health as they were to disease, and a whole new wonderful world began to open up for them.
Natural Healing
True Healing That Creates Powerful And Lasting Health
By far most of my patients’ biggest shock was the fact that the horrors that they expected from me and my programs really didn’t exist. In fact, the product that I sold most in my clinic was simply COMMON SENSE!
Most of my patients were so shocked at how truly easy it was to change and live a new healthy life. Even the few who had a tougher time giving up the “good life” soon became so addicted to
19 Introduction To Bowel Cleansing
Introduction To Bowel Cleansing
feeling good and having so much energy, that they immediately recognized their old ways as the true poisons that they were.
After a few visits, my patients began to see that the real torture was not inside my clinic, but outside my clinic. Because when your body is sick, it is simply because of what you are doing to yourself. You are sick because how you live is killing you. It’s that simple. To cover up disease medically and just create the illusion of health takes very concentrated chemical drugs that have debilitating side effects. Often, this isn’t enough, so people undergo mutilating surgical cutting and burning and all sorts of painful, horrifying, ghastly and expensive medical torture.
But inside my clinic, there was no cutting and burning, and no ghastly, horrifying and horrendous side effects. There was only health and healing.
Inside my clinic, my patients’ pain was relieved and their diseases were cured, but not with drugs. Instead, I used my two basic fundamentals of healing disease and building health with Natural Healing.
STOP what you are doing that is making you sick.
START what cleans, nourishes, strengthens and heals your body.
I am smart enough to know that this divine, incredible and complex body that we are blessed with is far beyond my comprehension and understanding. I wouldn’t ever try and bullshit anyone that I understand even 10% of what is going on inside all of us. And I certainly wouldn’t expect you to believe that I knew enough to go inside you, surgically or chemically, and heal disease.
On the other hand...
20
Our bodies have many organs, numerous systems, thousands of chemicals and billions of cells that are designed to heal us of anything, and they will do this immediately, if we just give them the chance, the opportunity. And the way we give our body a fighting chance to heal itself is simply to create a healthy lifestyle, a healing environment, and our body will take over and do everything else that is needed.
How do I know this? Because for the last 30 years, I have instructed my patients, students and other doctors, all over the world, on how to create this healing lifestyle. How to live life in such a way that your body will heal itself and disease and sickness will literally leap out of your body.
What I know is how to live our lives in such a way that our bodies will heal themselves of ANY and ALL diseases known to mankind.
THE RESULTS: Over a hundred thousand patients have healed their diseases without medical doctors, drugs and hospitals, using only Natural Healing, Herbal Medicine and Good Common Sense.
“He [the patient] is looking to get something for nothing, not knowing that the highest price we ever pay for anything is to have it given to us. Instead of accepting salvation, it is better to deserve it. Instead of buying, begging or stealing a cure, it is better to stop building disease. Disease is of man’s own building and one worse thing than the stupidity of buying a cure is to remain so ignorant as to believe in cures.”
— Dr. John Tilden
21
To Bowel Cleansing
Introduction
Introduction To Bowel Cleansing
My Natural Healing Masters, Teachers And Patients
This book is dedicated first to the teachers of my great teachers: Henry Lindlahr, John Tilden, John Harvey Kellogg, Benedict Lust, Edward Shook, Jethro Kloss, Father Sebastian Kneipp, Randolph Stone and many others… many who followed the old German Nature Cure school of thought.
To my great teachers, especially Paavo Airolla, Dr. Bernard Jensen and Dr. John Ray Christopher, who all taught me the miraculous healing power of good thorough colon cleansing that healed thousands of patients in their clinics.
And finally, to my thousands and thousands of patients, who walked, crawled and were carried into my clinic over a span of three decades and put their trust in me. To the few who died and the many who survived and thrived, you were the ones who taught me what doesn’t work, and more importantly, what does. And most importantly, what it takes to heal killer and life-threatening diseases and create powerful and lasting energy, vitality and health.
You are the ones who really taught me the miraculous healing power of colon cleansing.
Colon Cleansing Training And Experience
As you can see from my dedication, I have the best training. If you want to heal yourself of disease and illness, and do it naturally, I am your man. But more importantly, I have experience.
While my friends were rocking and rolling to the sounds of the 60s, I spent the second half of my teenage years just trying not to die. Because I inherited a heart deformity from my parents, the top medical doctors said I would be dead by 20. Well, today I am happy to say that those medical doctors are all dead and that I am very much alive.
22
Introduction To Bowel Cleansing
In my own personal healing journey, I experimented with bowel cleansing far beyond what I have ever seen published by anyone. I knew that in order for my body not to die, but instead to heal itself and build me a new heart, that I needed to be clean down to a cellular level.
Once I healed myself and went to school to study Natural Healing and Herbal Medicine, and worked in the clinics of my great teachers, I immediately saw the power of colon cleansing on a much bigger scale. At Dr. Bernard Jensen’s clinic, I witnessed some of the most unbelievable sizes and shapes of fecal impactions that you could imagine streaming out of the patients. As Dr. Jensen himself would remind me on a daily basis, a dirty bowel was literally the root of all evil, the major cause of almost every disease.
Training under Dr. John Ray Christopher, an hour didn’t go by when he wasn’t exclaiming that to get a patient well I needed to get to the cause, behind the cause, behind the cause, behind the cause. In other words, he too knew that autointoxication from an impacted and malfunctioning intestinal tract was again the cause behind most diseases.
Years later in my own clinic, I soon discovered that even my teachers’ programs were not effective enough because, in the heyday of their clinics, medical statistics say that only 10% to 30% of Americans had bowel disease and fast food was hardly even heard of. But in the prime of my clinical practice, there was now a fast food joint on every one of the four corners of every major city intersection and the medical books were now saying (in the 1980s) that about 50% of Americans have bowel disease and by the 1990s that 100% of Americans will have bowel disease as they grow old. Also the incidence of colon-rectal disease and colon-rectal cancer was skyrocketing, killing and infecting hundreds of thousands of Americans. So I had to take my great teachers’ Natural Healing Routines and Herbal Formulae and crank the intensity, WAY UP!
23
Introduction To Bowel Cleansing
As you’ll see in this book, what my great teachers saw as their worst cases of constipation and colon disease were now the commonplace in my clinic. My great teachers would not have been able to imagine the far worse constipation and bowel disease that I would encounter just in the first few years of my clinical practice.
Colon Cleansing Is Just Not “Cool” Anymore
Today, we live in a much more politically correct time when most Natural Healing and herbal books are written by university professors and supposedly hip medical doctors. Even the few remaining true herbal authors are pathetically scrambling to be recognized, legitimized and licensed, so they can become real doctors of some sort. They have all shed and buried their natural roots, traded in their mortar and pestle for a stethoscope and a white jacket, ignored their sense of smell, taste and common sense for a data printout from a HPLC (High Performance Liquid Chromatograph) and denied their roots of the great herbalists of the past and would spit on their graves if it meant they could get recognized.
Consequently, they have thrown out many of the basic fundamentals of healthy living, especially colon cleansing, and just talk about the marker chemicals or standardization of herbal products and attend their bullshit association meetings and political gatherings. In the meantime, while they are sweeping colon cleansing neatly under the carpet for cleaner and more scientific things to talk about.
Americans are being diagnosed by the hundreds of thousands with more colon-rectal disease and colon-rectal cancer than EVER before in history!
Most herbalists and supposed herbal authorities today never ran a clinic, nor ever had any patients. If they had, they would know that colon cleansing should be at the top of their list of health programs, not being eliminated as old fashioned, dirty and uncomfortable to talk about.
24
Sure, I too wanted to be a cool, recognized herbalist when I first opened my clinic. I, too, wanted to heal the diseases of mankind, especially the life-threatening ones and the ones that medical doctors say are incurable or at best manageable, but can never be healed, and I too wanted to heal these people and their diseases with my secret formulae made from rare and exotic herbs from deep in the rainforest or high on the top of the Himalayas. BUT, I also knew that I first had to correct the FUNDAMENTAL things in life that my patients had screwed up, like their food program, their circulation and exercise and, of course, their constipation.
Well, my patients screwed me out of that dream. I always say that my patients had the nerve, the gall, to get better before I was ready for that to happen. They cheated me out of my fantasy about healing killer diseases with exotic herbs.
I thank God that what my great teachers knew, what they taught me and what I soon discovered, is that the fundamentals of good living HEAL ALL BY THEMSELVES. I didn’t need all the fancy, schmancy stuff. I could see all my fantasies of joining my colleagues at their prestigious herbal associations quickly fading away.
In fact, 80% of my patients were healed after JUST doing my 5-Day BOWEL Detox.
What turned out to be my greatest clinical discovery is that my patients, suffering with EVERY KNOWN DISEASE, got well, healed, totally healed, almost EVERY SINGLE ONE OF THEM, and more importantly stayed disease-free and healthy for years, by just following the fundamentals of good healthy living and doing a thorough, complete colon cleanse.
25 Introduction To Bowel Cleansing
Introduction To Bowel Cleansing
Find this hard to believe? So did I. But my healed patients were sitting in my office with all of their medical tests, blood workups, ultrasound pictures, x-rays, biopsy reports and their poor prognosis, that said they were sick and dying... and now they had new medical tests, reports and pictures and very shocked medical doctors that couldn’t exactly explain what happened. But sure enough, their disease was gone, vanished, and they were healed. Many of my patients were told by top medical doctors and oncologists that they would be dead in a few days, and they are still alive today, 20 years later. And their diseases, cancers, tumors, whatever, just went away. The proof was sitting in my office right in front of me. It was undeniable. Healing miracles do actually happen, and happened every single day in my clinic.
I Did Things A Little Differently
Now, I have to admit that my programs weren’t exactly run of the mill. I am famous for being a hardass with tough programs. See, I figured early on that I had nothing to lose. My patients had already tried medical treatment and it failed them. Many were sent home to die, so big deal if I screwed up, they were dead anyway. For many of these patients Natural Healing and Herbal Medicine had failed them, also. Many told me that herbs and natural stuff just doesn’t work. At first, I was very angry at their remarks and then I realized, THEY WERE RIGHT! Because when I looked around me at the current state of Natural Healing and Herbal Therapy, it was pathetic, real wimpy at best.
At least, the medical doctors knew how to deal with your disease with INTENSITY. My God, if you go to a medical doctor with a malignant cancer they are going to cut, carve, gouge, rip and burn this cancer right out of your body. They will carve half of your face off or scoop a big chunk of your brain out, if necessary. If you die, heck, the disease was going to kill you anyway. They will burn your ass off with radiation, implant radium seeds into your lungs or ovaries and inject highly concentrated, extremely toxic, cell-killing chemicals directly into your bloodstream, while my colleagues
26
were lighting candles, singing positive affirmations, and doing biofeedback.
What utter wimpy bullshit. The doctors knew that to heal raging killer diseases you had to sharpen your drills and saws, crank up and concentrate that radiation beam and boil down that chemo a little stronger, again while the Natural Healers were pussyfooting around with aromatherapy.
So in my clinic, I pulled out all of the stops and cranked up Natural Healing and Herbal Medicine all the way. I tried to kill my patients with hot and cold showers, drown them with water and juices and develop intensive programs that would either kill them or cure them. But I couldn’t kill any of them—they just got better.
The same was true for the colon cleansing routines and herbal formulae of the era. They were weak. Many were antiques, hundreds of years old, when people got way more exercise and ate lots more unprocessed food. When I used these colon cleansing formulae in my clinic, my patients wouldn’t even get a good fart, let alone a good bowel movement. So, I was forced to turn up the intensity. I created stronger and more powerful bowel cleansing programs and herbal formulae, far beyond anything that was available, until I started to get the job done, until my patients were getting their bowels cleansed and working again, until my patients were getting well. For some of my patients, I had to move out of human strength bowel cleansing herbs and research old veterinary books to find herbs that were stronger, that were actually used to clean the bowels of animals 10 times heavier than humans, like horses. It wasn’t until I developed formulae with this kind of strength that my patients started getting healed.
As news spread of my aggressive and powerful Colon Cleansing, my colleagues and even some of my closest friends told me that I was going too far, that I would hurt people. Because the majority of them didn’t have clinics and never worked with patients, I guess they didn’t realize what a bunch of tough, seasoned, hardass and
27
Introduction To Bowel Cleansing
Introduction To Bowel Cleansing
constipated people Americans are, who are hell-bent on killing themselves living the “good life.”
“Did you ever notice that when we are partying that it’s full steam ahead? We have our foot on the gas pedal and we floor it. I have never heard of anyone, ever, that when drinking beer said, ‘You know, Bob, we have each had a six pack of beer. Why do you think it is packed in sixes? Do you think we should call the beer manufacturer and see if having a seventh beer is an overdose?’ Or did you ever hear of anyone that stopped eating after one bag of potato chips, one candy bar, a packet of cookies or two cupcakes, because they had already eaten the suggested adult serving? Hell no, we just pop open the seventh beer and the second bag of chips with absolutely no hesitation.
But... when healing ourselves and doing the best healthy thing that we have ever done for ourselves in years, we immediately take our foot off of the gas pedal and slam on the brakes. WHY? I have heard every silly and ridiculous question from ‘can too much organic food hurt you’ to ‘can I overdose on Echinacea’, but no one ever called me up and asked me if too much whiskey or pot was an overdose. I would tell my patients that if they would use half the energy and passion that they had used partying and killing themselves in their new health program, the disease would leap out of their body and they would be well tomorrow.”
The Bottom Line… Pun Intended.
So with my 5-Day BOWEL Detox, which frightened and scared my colleagues, I saw 80% of my patients have the majority of their symptoms disappear AND their sickness and disease retreat and disappear. Just by cleansing their colon as I suggested. What terrified other herbalists and natural doctors didn’t scare my patients a bit. It just healed them.
Today, most people think that the extremely fast pace of modern life makes it inconvenient for them to take an extra two minutes out of their busy lives, a few times a day, to empty their body’s waste from the largest organ in their body.
28
Today, the average person’s high animal food diet containing ZERO fiber, combined with overprocessed and refined food that becomes an impacted, immovable toxic disease-causing sludge in their colon, makes it impossible for them to have normal bowel movements, even if they make the time.
Well, do I have the answer, and it is in this book with more straight medical facts and personal clinical experiences than you will see in print today.
In this book, you will clearly see that the real cause behind the majority of sickness and disease in America is the retention and storage of toxic, poisonous waste in our colon and the infrequency of its being emptied. In this book, I will show you how cleansing your colon will make the biggest healing difference in your life, help you to heal any disease and sickness and create powerful lasting health and vitality. Most importantly, I’ll show you how to do it!
29
To Bowel Cleansing
Introduction
A Basic Understanding Of How It Works Could Save Your Life!
Esophagus
Gallbladder
Duodenum
Pancreas
Ascending Colon
Cecum

Appendix
Liver (Left Lobe)
Stomach
Portal Vein
Descending Colon Ileocecal Valve Rectum
Sigmoid Colon
Small Intestine
30 Digestive, Assimilation & Elimination Tract
COLON
Liver (Right Lobe) YOUR
BOWEL ANATOMY AND PHYSIOLOGY 101
From your mouth to your anus, this intestinal tube is as long as two cars parked end-to-end.

Knowing what goes on in the last 5 feet of it can Save YOUR LIFE!
Thousands of patients walked into my clinic with stomach aches, but when I would ask them where their stomach hurt, they would almost always point to their colon instead, about 12 inches below their stomach! We walk around in our body for a 100 years, but have little or no idea where our particular organs are. Well, not anymore. In this chapter, I will show you where your digestive system and colon are and put an end to the mystery.
Your colon is the last stage of your digestive tract and has many jobs. Having a basic understanding of your colon’s functions can keep you healthy and prevent disease.
The 30-Foot Long Journey
I will take the liberty here of actually describing the entire digestive and elimination tract. The main reason for this is I don’t know the next time I will get close to this subject and it may be helpful to many of you to understand the upper gastrointestinal anatomy and physiology. And as always, if this section is more than you can comprehend, drop it. There will be no test, and you can heal yourself of anything without knowing the following information. Saying that...
31
CHAPTER 2
30 feet
The Digestive And Elimination Tract
The digestive and elimination tract is one long tube from your mouth to your anus, just shy of 30 feet long. There is only one way in and one way out. This tube is often referred to as the alimentary canal or tract, which includes the mouth, esophagus, stomach, duodenum, small intestine, large intestine, rectum and anus.
The Esophagus
In your mouth, when you chew, saliva is produced from the salivary glands and mixed with food. This is often referred to as the first stage of digestion, because saliva enzymes initiate the digestion of starches. Saliva also lubricates the food for its initial travel down the esophagus. The esophagus is about 9 inches long and takes swallowed food down to your stomach. Where the ESOPHAGUS meets the stomach, there is an esophageal sphincter muscle, which relaxes to let food enter the stomach and then contracts to prevent the backup of stomach contents.
The Stomach
The STOMACH is a muscular sac with a mucosa lining. This lining secretes gastric juices, like hydrochloric acid and pepsin, that help to further digest your food. These juices begin the digestion of proteins. Just the sight and smell of food triggers the excretion of gastric juices. Bad habits like chewing gum continually stimulate and fool the stomach into thinking food is on the way and can lead to digestive and stomach trouble. Also, animal foods, especially beef and pork, are almost impossible to digest and require the constant secretion of acid, which can lead to stomach and duodenal ulcers, burnt tissue and eventually holes in your stomach and intestinal lining. (OK, I know I strayed to Natural Healing and not anatomy and physiology.)
At the end of the stomach is the pyloric valve, which keeps the stomach’s contents in the stomach until they are sufficiently processed and digested to move on. This valve and the emptying of the stomach’s contents is triggered by hormones, nerves and other factors.
32 Bowel Anatomy and Physiology 101
The Small Intestine
As food is released from the stomach through the pyloric valve it enters the duodenum, which is technically considered the first part of the small intestine. The duodenum is almost a foot long. When partially digested food, sometimes referred to as chyme, enters the duodenum, it triggers the release of hormones. These digestive hormones are released from the walls of the duodenum and stimulate the liver and gallbladder to release bile, which enters the duodenum through the common bile duct. These hormones also stimulate the pancreas to release pancreatic juices into the duodenum through the same common bile duct, sometimes referred to as the pancreatic duct. These liver and pancreatic juices continue the process from the stomach, breaking down carbohydrates and proteins. But now, these juices also start to break down fats. The walls of the duodenum secrete digestive juices, too.
The second part of the small intestine, which is about 9 feet long, is called the jejunum. The third and last part of the small intestine is called the ileum. It is 13 feet long and terminates at the ileocecal valve at the beginning of the colon or large intestine. The wall of the entire small intestine, all three parts, are folded and look like accordion pleats. These folds have even smaller folds on their surface small projections called villi, about 3/8ths of an inch long. There are even micro-villi that are smaller. Obviously, all of these folds increase the surface area of the small intestine. Since this is where the majority of food absorption takes place, the more surface area to absorb, the better. Each villus (the singular of villi) contains a capillary network which introduces the digested food nutrients into your bloodstream. The portal vein transports this digested food first to your liver and then, if deemed acceptable, onward into your entire circulatory system to feed every cell in your body.
33 Bowel Anatomy and Physiology 101
The Large Intestine
At the end of the small intestine is the ileocecal valve, which allows food to pass into the large intestine, colon or bowel, whatever you want to call it. The large intestine (see illustration on page 30) is about 5 feet long and 7 inches in circumference. It has no villi, but still can absorb water, vitamins and minerals from the intestinal contents. This process dries the intestinal contents and turns them into waste (fecal matter) for release or defecation.
The first part of the large intestine is called the cecum. The vermiform appendix, about 3 to 4 inches long, is right below the illeocecal valve. It is an immune system aggregation similar to the tonsils, adenoids and the Peyer’s Patches in the small intestine. Here is the perfect placement to detect any pathogen or micro-organism that may be harmful to you as the digested food enters the final stage of digestion ready for elimination. This is also the biggest anti-gravity and uphill trek for the food. The vermiform appendix also excretes fluids that lubricate the food and stimulate peristalsis, the muscular contractions of the colon that move the food and eventually fecal matter along. The parts of the large intestine are referred to in order: cecum, ascending colon, hepatic flexure (the first turn near the liver), transverse colon, spleenic flexure (downward bend near the spleen), descending colon, sigmoid colon, rectum and anus. Parasites are often found in the cecum and in the appendix. It is their favorite breeding ground and hiding place. Constipation, on the other hand, is most often found in the descending and sigmoid colon. The rectum is about 5 inches long and is considered the end of the colon. The anus is the sphincter muscle at the end of the rectum that opens to release the undigested and unassimilated food residue called feces, fecal matter, stool or excrement. I don’t know who was the first person to take a good look at and examine feces—probably a guy like me—but in any case, examination of the stool is a diagnostic art in itself. Color, form, consistency, odor and the presence of blood, mucous and parasites can all tell a story about a patient’s health and have been used by doctors for centuries to diagnose disease. Medical doctors today still use a stool sample to detect colon cancer and many other diseases.
34 Bowel Anatomy and Physiology 101
“My FIRST RULE with all of my patients was to get their bowel cleaned out. Then, the healing begins.”
— Dr. Richard Schulze

Bowel Anatomy and Physiology 101
Polyp
The Average American Colon

Cancerous Tumor
Diverticulitis
Bleeding Fissures
Many Diverticuli
The “Perfect” Colon

36
Colon
The Latest Medical Statistics
Colon Disease and
Cancer:
CHAPTER 3
COLON DISEASE AND COLON CANCER:
THE LATEST MEDICAL STATISTICS
In Their Lifetime, The Average American Eats:
� 12 three thousand pound cows
� 6 whole pigs
� 3,000 chickens, turkeys and other flying birds
� 3,000 fish, sea creatures and sea scavengers
� 30,000 quarts of cow’s milk
� 30,000 aspirin and pain killers
� 20,000 over-the-counter and prescription drugs
� 2,000 gallons of alcohol
Per year...
� 500 doughnuts
� 400 candy bars
� 300 soft drinks
� 170 pounds of white, refined sugar

37
What Causes 100% Of Americans To End Up With Colon Disease?
� In the U.S., we eat more than 1,000,000 animals an hour.
� Every day, 49% of ALL Americans take one or more pharmaceutical drugs.
� In 1972, we spent 3 billion a year on fast food. Today, we spend more than 110 billion.
Look What They Put In Their Bodies!
Just imagine all of that dead decaying flesh, junk food and drugs going into your mouth, all of it passing through your digestive tract into your bloodstream, your brain, your heart and then out through your liver, bowel and kidneys. This fiberless feast causes the average American to be 70,000 BOWEL MOVEMENTS SHORT in their lifetime.
The Latest Medical Statistics
What makes hot news isn’t necessarily an accurate reflection of what is really going on in the world. This is especially true when it comes to what people are dying from.
Breast Cancer: Black tie galas are being held all over America to raise money for breast cancer research. October has been declared National Breast Cancer Awareness Month. The word “mammogram” is on every woman’s lips, and if all that isn’t enough I received an invitation to a black tie gala in New York, “Penthouse Pets Bare Their Breasts For Breast Cancer.” I am NOT kidding.
Prostate Cancer: Every man is dreading his next prostate exam, while every magazine you pick up has an article on prostate cancer.
AIDS: Every day there is another article or something on the radio or television about AIDS. It has totally changed our lives, from how we have sex to police officers wearing rubber gloves.
38 Colon Disease and Colon Cancer: The Latest Medical Statistics
And while all our attention is on breasts, the prostate, AIDS and sex... colon cancer kills 400% more people than AIDS! It actually KILLS more men and women in America than breast cancer or prostate cancer.
Yes, according to the Center for Disease Control (CDC), death from AIDS has declined significantly in the past 5 years. It’s down a whopping 70%, but the AIDS media blitz still continues.
SEX SELLS. Many reporters have told me that no one wants to hear about poop and that breasts, prostates and sexual diseases are more sexy and sex-related and, therefore, more newsworthy. But sexy or not, AIDS only kills about 15,000 Americans a year. Prostate cancer will kill about 39,000. Breast cancer will kill about 40,000. But, colon-rectal cancer will kill about 60,000 Americans this year with over 150,000 new cases diagnosed. I know, I’ve heard all the excuses: “It’s dirty, it’s embarrassing, and I don’t want to talk about poop.” Or my favorite: “I’m too busy to be going to the bathroom all the time.” Like ostriches with our heads buried in the sand, we don’t want to discuss colon disease or health.
Although colon-rectal cancer and disease is reported in most modernized countries, American’s high levels of constipation and our unwillingness to talk about it has helped us win the international contest hands down. We have now awarded ourselves the highest incidence of colon cancer and disease of any country in the world. And according to medical statistics…
EVERY American will develop some type of colon disease, polyp, tumor or colon cancer in their lifetime. So it’s high time we started talking about what’s causing it, how to heal it, and more importantly, how to prevent it.
39 Colon Disease and Colon Cancer: The Latest Medical Statistics
Let’s Check What The Top Medical Doctors Say
FECAL MATTER REMOVED FROM AN IMPACTED COLON

The Merck Manual is written by the most distinguished and respected group of top medical doctors and pharmaceutical manufacturers in the world. It is the medical industry’s standard text for the diagnosis and treatment of disease. This book tells us that colon degeneration is on the rise.
Every American Eventually Has Diverticulosis Or Has Many Diverticula!
The incidence of diverticulosis (herniated bowel pockets caused by constipation) has increased dramatically over the past 50 years. It states that in 1950 only 10% of adults over the age of 45 had this disease; in 1955, 15%; in 1972, 30%; and in 1987, 45%. The most recent edition states that the incidence increases rapidly over age 40 and that every person will have diverticulosis if they live long enough. Diverticula are sac-like herniations through the muscular wall of the colon that are caused by increased pressure in the bowel from constipation. By old age, every American has many. They are filled with trapped fecal sludge, they become infected and the rotting feces erodes the surrounding mucousa. Blood vessels rupture, then infection begins.
Up To 50% Of Americans Have Polyps In Their Colon!
A polyp is a tumor that arises from the bowel surface and protrudes into the inside of the colon. Most polyps eventually transform into malignant cancer tumors.
40 Colon Disease and Colon Cancer: The Latest Medical Statistics
Alternative Healers, Natural Healers and the new breed of “HIP” medical doctor authors have all ignored the latest disease statistics and… swept colon cleansing under the carpet.
So while the top medical doctors are saying that bowel disease is more prevalent than ever, and killing more Americans than ever before, why don’t I see more Bowel Detoxification Programs in all the new Natural Healing books being published?
It appears that Natural Healers and these modern day hip medical doctor authors have politely swept it under the carpet and consider it dirty or not high tech. It’s like they forget we even have a bowel. They would rather discuss the latest enzyme fad to lose weight or debate how melatonin helps jet lag. The most popular diets today like The Zone (eat the hamburger, but throw the grain bread out) and Atkins (heavy animal protein blood feast) are almost fiberless regimes that left most of my patients constipated to the gills with severely increased cholesterol levels. There is no shortage of hype on St. John’s Wort, Cat’s Claw, Kava Kava, Colloidal Silver, the latest weight loss amino acid craze or SAM-e. But what about the foundation of health, having a clean colon? Has it become politically incorrect to discuss the bowel?
While these so-called health authors ignore colon cleansing and won’t discuss it, millions of Americans are literally rotting from the inside out.
41 Colon Disease and Colon Cancer: The Latest Medical Statistics

“Your FOCUS determines your FUTURE.”
— Dr. Richard Schulze

DR. SCHULZE’S CLINIC: THE EARLY YEARS
Armed with my teachers’ herbal formulae, I unleashed myself on the world and set up my first real practice in Hollywood, California. But I am afraid nothing could have prepared me for my patients.
I will never forget my first year in practice. I had already healed myself and I had spent 10 years traveling around the country following, studying and interning with the best Natural Healers and Herbal Doctors of the past century. I attended their schools, graduated most of them, received two doctorates (17 different diplomas in all) and went on to teach at most of these same schools. To earn money to eat and pay tuition, I worked in most of their clinics and saw patients on the side in massage studios, book stores and the back rooms of health food stores. By now the year was 1975, and I thought I knew everything. I was definitely over trained and under-experienced.
In the first few weeks of official practice, God sent me a lovely, but very depressed, woman patient about 50 years old. She was partially depressed because of anxiety about the onset of menopause, but mostly because of her daughter. I had heard from another patient that her daughter had a chronic bowel problem, so I asked her to tell me about it and she told me this story.
Her daughter always had trouble going to the bathroom since she was an infant. But when puberty arrived, her bowel just about stopped working altogether. For two years, she hardly went to the bathroom at all. At 15, after suffering very long bouts of
43
CHAPTER 4
Dr. Schulze’s Clinic: The Early Years
constipation and almost constant pain in her lower abdomen she finally developed diverticulitis (an infected, herniated, irritated, inflamed, painful bowel) with colon and rectal bleeding. Since medical doctors know nothing about herbs and their healing ability (not even Aloe Vera) they resorted to going up inside this little girl’s rear end a few times (an extremely uncomfortable and painful procedure) and cauterized (burned) the inside of her colon in a last ditch effort to try to stop the bleeding. Finally, after six months of torture, they suggested the removal of her bowel, an ileostomy, and said it would save her years of future suffering.
The doctors convinced the family that this was a fairly simple procedure and that many people live a normal comfortable life after having an ileostomy. When the daughter woke up after the surgery in the hospital bed with no bowel, a big red sutured scar from one side of her belly to the other and a hole the size of a silver dollar in her gut with a plastic bag glued on it filled with poop, she was quite freaked out, as you can imagine. The doctors said she would get used to it in no time, but she didn’t. After months of depression and not wanting to go to school, her mom decided to throw her a sweet sixteen party to lift her spirits.
Mom invited all of her friends, including a new boyfriend she met at the mall. Mom even sprung for a new party dress. The night of the party came and everything was going great. Towards the end of the party, her daughter was slow dancing with her new boyfriend. They kissed; it was perfect. Then all of a sudden, he shrieked and pushed her away in terror. He was covered with hot, wet, stinking fecal sludge and so was she. Her bag had become unglued and fell off spurting its contents everywhere, covering her, her new party dress and her new boyfriend.
Needless to say, the party was over and the daughter ran to her room in an hysterical, sobbing, crying fit. Mom cleaned her up and tried to console her, but finally decided to let her sleep it off, thinking that tomorrow would be a new day. When mom went up to her daughter’s room in the morning, her daughter had hung herself in her closet. She was dead. So much for what the
44
Dr. Schulze’s Clinic: The Early Years
doctors call a simple surgery. What they meant was that it was simple to perform, not simple for the patient to live with. Some people think that I am acting too much like a hardass when I call the AMA the American Murderers Association. Well, if they would have spent a few weeks in my clinic, seeing all the children tortured and killed by modern medicine, they’d call them a lot worse.
As God works, the very next day I got a call from another frantic mom, except this time it wasn’t too late. It was Tuesday and the mom told me that her little 11 year-old boy was scheduled for a colostomy surgery (colon removal) on Friday. He had been constipated for years and had not gone in months. She begged me to help, but I only had two days in which to work a miracle. I put together a very strong experimental herbal bowel cleanser, because none of the ones my teachers taught me had ever worked for any of my seriously constipated patients. So I got out my old veterinary herbals from the 1800s, and looked up what they would use for large animals like horses. I picked out a few herbs, mixed them up and I gave it to this boy and the very next day he had a bowel movement. Mom called me and told me it was over 2-feet long and up to 2 to 3 inches wide. It was so hard that after numerous failed attempts at flushing it down the toilet, her husband had to go out to the garage and get a shovel and chop it up to get it to flush. This kid is now a grown man, married, with two kids of his own.
How much do you think his life would have been changed, if not ruined, had he undergone that horrifying, disfiguring surgery?
What I used on this little boy was the first crude version of my Intestinal Formula #1. Until I refined it, some patients referred to it as TNT Herbal Explosive and Depth Charges. I am strongly against animal torture and experimentation, but I needed to refine my formula. This is when I discovered that relatives are often a great inexpensive replacement for laboratory rats. I gave one of the earliest versions of this formula to my brother, who had a long history of constipation… well, not
45
Dr. Schulze’s Clinic: The Early Years
anymore. I made a mistake with my calculations and gave him a serious overdose. He not only experienced the laws of jet propulsion, but claims that he has never been constipated again and has had perfect bowel movements for the past 25 years. I eventually got the formula perfected. See, up until this point most herbal-bowel formulae available were actually antique herbal medicines. One popular formula used in the 1970s and still sold today in health food stores is Arnold Ehret’s Innerclean. This man was born during the civil war and cleansed the bowels of who knows, Buffalo Bill, Wyatt Earp? This formula was designed over 100 years ago when people were riding horses and all food was whole food. One of the other most popular formulas of the 1970s came from one of my great teachers, Dr. John R. Christopher. Naturalax #2 (sometimes referred to as Fennel-B) is a great MILD herbal formula, but he designed this formula during his years of clinical practice, and he died in 1983. So this mild laxative formula is what, 30? 40? 50 years old? My patients in the 1990s were not getting results from this formula either.
From this day on, I vowed to never let another child, or ANYONE, suffer from constipation or have a mutilating colon surgery. This was just one of the reasons I developed my Intestinal Formula #1.
46

“There are NO incurable diseases, NONE. Take RESPONSIBILITY, and be willing to CHANGE, and you can heal yourself of anything.”
— Dr. Richard Schulze


CONSTIPATION: THE SHOCKING TRUTH
How Much Fecal Matter Can One Person Hold?
Back in the 1960s, there weren’t fiberless fast food restaurants on every street corner and life and work wasn’t so sedate. Back then a hard drive was a bumpy ride in a car and not something most of us are typing data into as we sit on our ass all day long. My patients in the 1990s had reached a level of constipation that far exceeded anything Dr. Christopher ever saw in his clinic and way beyond Arnold Ehret’s wildest imagination. The average American stores from six to ten pounds of fecal waste in their colon, which is not healthy. As far as the record-breaking accumulation of fecal matter, I had one man in Hawaii who got his dosage up to 46 capsules of my Intestinal Formula #1, which is a record in itself, before his bowels moved. Then that night, sitting on the toilet, HE EVACUATED 56 POUNDS OF FECAL MATTER. I met his wife and she said to me that she always knew her husband was full of shit (her words, not mine), but was she right. I had one lady, after doing my 5-Day BOWEL Detox for a YEAR, lose over 200 pounds. She went from 410 pounds down to 180.
How Bad Can It Get? Constipation Record Breakers
Thirty years ago when I first heard the great Dr. Christopher speak about extreme constipation, I thought he was lying. I wanted to believe him, but when he told me that he had patients that hadn’t had a bowel movement in a month, well, I thought that he was telling me a Natural Healing fish story. But, in the first year of running my Hollywood clinic, I had a fashion model come to see me, a very beautiful girl, slim, 5’8” and 115 pounds,
49
CHAPTER 5
Constipation: The Shocking Truth
and she only had 1 bowel movement a month for the past year and a half. I was shocked! Where did it go? I was ready to call David Copperfield or Siegfried and Roy. This was real magic.
That year, I had many patients that only had 1 bowel movement a month and for a few years in the clinic that was the record, until a woman came to see me, a 38 year old attorney, that only went every other month. She had only 6 bowel movements in a year! She held the record for a while, but then there was a young women from Santa Rosa, California. She only had 3 bowel movements during her last pregnancy. That’s one bowel movement per trimester and only two others that year. Now the record holder was only 5 bowel movements in a year. That held the record for some time, but three years ago I got a letter from a lady in Southern California thanking me for my Intestinal Formula #1. In the letter, she stated that before using my herbal formula she was only having one bowel movement every 6 months. That is only 2 bowel movements a year, the current record holder!
Sure, the above were extreme cases, but most of my patients suffered from some sort of constipation. I had well over a thousand patients that were lucky if they went once a week. People who are constipated live in discomfort, fear and shame. They usually don’t go around talking about it and don’t know where to turn. Everything has failed them: the empty promises of their medical doctors, their toxic mineral oil, the wimpy herbal laxatives that couldn’t even make you fart and the Natural Healers with their bran. Give me a break! They pay the money, and could fill a bus with the bottles of drugs and herbs that they took, but they still couldn’t poop until they met me.
What The Heck Is A Normal Poop, Anyway? Normal Frequency
I have literally traveled around the world in search of what a normal bowel movement and bowel habit should be like. Now, how many people can say that? I have traveled from the remote jungles of Central America to India, China, almost everywhere
50
to discover what is normal, because I knew I wasn’t going to find normal in New York, California nor even in Iowa. I wanted to see primitive people living in rural, non-industrialized areas, living simple rural lives under very little stress, getting moderate amounts of exercise and eating simple natural diets of locally foraged food. These relaxed primitive people all seemed to have one bowel movement within 20 to 30 minutes after each major meal that they ate. They just squat, it rapidly comes out within a minute and they are done. No library of magazines, no squeezing, straining, grunting, meditation or prayer. It just came out effortlessly. They seem to average between 2 and 4 bowel movements a day or 14 to 28 bowel movements a week, compared to the average American’s bowel habit of 1 bowel movement every 3 to 5 days or 2 to 3 bowel movements a week. I figured this puts the Average American about 70,000 bowel movements short in their lifetime!
Normal Consistency
The consistency of your bowel movements should be soft and unformed, like peanut butter or soft serve frozen ice cream. Occasionally, they can be a bit chunky depending on what you ate and how well you chewed it, but in any case they should NOT be formed and they should be light in color. I remember as a kid my dad only went once a week on Sundays. He would take the entire Sunday paper in the bathroom and be in there for hours. When he came out, the room smelled like someone died. I would then take my place at the throne after him and squeeze hard for my once-a-week bowel movement. Eventually, I would blast out some small black balls as hard as granite. My dad would come into the bathroom to wipe me, but my fecal matter was so dry and hard there was nothing on the toilet paper. I remember my dad remarking, “Now that’s a good poop, no wiping, like it’s wrapped in cellophane,” and I would leave for a week, thinking I did a good job.
Signs of Constipation
If you need a library in your bathroom, you know, like a stack of magazines on the hamper, then you are constipated. If you drink
51
The Shocking Truth
Constipation:
Constipation: The Shocking Truth
coffee, well, if you stop, you will also probably stop having bowel movements, too.
A 5-Foot Long Fecal Impaction

Removed with Dr. Schulze’s 5-Day BOWEL Detox
This impaction had been in the patient for many years. Fiberless food sludge that is mostly animal food and refined flour enters your colon. Because of constipation and infrequent bowel movements, it is not completely eliminated. The remainder of it plasters onto the inside wall of your colon. That is why in this picture the fecal casing took on the shape of the inside of this patient’s bowel, including the colon’s folds and herniated diverticula.
This process can literally go on for decades just like an old steel water pipe that gathers corrosion over years and its inside diameter shrinks. Constipation is a progressively degenerating
52
5-foot fecal impaction in a bathtub
disease where eventually you have total blockage of the colon or colon disease, often causing cancer and death. I have seen this type of fecal mucoid casing come out of many of the chronically constipated patients in my clinic, but usually not after their first Bowel Detoxification Program. Often, like with this man, it took 4 or 5 times. This man is fine and healthy now, and his lower abdomen that was distended for years is now flat.
I estimate that this was 10 to 15 years of backed up fecal sludge.
Parasites
Looking under a microscope, anyone can see parasites in animal food. One cubic inch of Grade-A Beef often has over 1,000 parasite larva in it. Fish is the worst. Some of their parasites are as big as earth worms. There are even many parasites that live on fruits and vegetables, but if a person has 2 or 3 bowel movements a day, these parasite larva don’t hatch, and you’re fine. And if you’re like me and eat lots of garlic, well, no self-respecting parasite is going to take up house in your colon anyway.
But if you don’t have regular bowel movements and only go a few times a week, these parasite larvae hatch, hook onto your colon and start feeding on your backed up waste, and even feed on your tissue. In my clinic, I had every patient do my 5-Day BOWEL Detox, which is a real parasite flush. After doing it, they would bring in bottles, jugs and pails full of worms, some of them quarts of little worms, many the size of snakes. One of my patients actually went to the hospital after doing my bowel detoxification program because of colon pain. Later, the hospital called me to report that she had evacuated a 35 foot tape worm. WOW!
I could tell a thousand clinical colon parasite war stories, from spaghetti and fettuccini heaps to cobras and rattlesnakes to the things that looked like scorpions and crabs. Maybe I’ll just do a parasite issue one day, but for now let’s move on.
When you die, the worms actually crawl OUT, not in.
53 Constipation: The Shocking Truth
“ BLOCKAGE— Physical, Emotional and Spiritual—is the cause of ALL DIS-EASE.”
Healing Colon Disease Naturally 54
HEALING COLON DISEASE NATURALLY
Bowel Cleansing can be the cure for any digestive disease.
Like any great egomaniac student in herbal college, I wanted to develop very intricate and detailed herbal formulae. These formulae would be very difficult to make and could only be made from very exotic and rare herbs found only in the Rainforest or in the Himalayas. And of course, these formulae would be extremely effective for treating very specific diseases. I was going to find the herbal cure for cancer...
Thank God my great teachers deeply ingrained in me that before I could embark on any of my disease specific smart bomb herbal fantasies, I must get my patients on a good health program. First things first. First, I needed to get them following the basics for a month or two, what I now refer to as my Foundational Programs, the foundations of health: a good clean and wholesome food program, thorough bowel cleansing and detoxification, immune boosting, exercise and positive emotional work. I knew that there was no replacement for these basics.
By doing so, I unknowingly destroyed my fancy, disease-specific, herbal formulae dream, because approximately 80% of my patients, regardless of what was wrong with them, regardless of how long they had been sick, got more than relief. THEY GOT WELL! Just from bowel cleansing!
When I added all my other foundational programs, over 95% got well with no specific treatment at all. So much for my trips to Tibet.
55
CHAPTER 6
You heard right. The vast majority of my patients got well and recovered from their diseases without ANY specific treatment. All they did was make some common sense lifestyle changes, including cleansing the bowel, and they were healed. My patients, having the nerve to get well before I was ready, ended all my dreams of discovering herbal cures for the afflictions of mankind and turned me into the common sense herbal country doctor that I am today.
Bowel Cleansing Can Be The Cure For Any Digestive Disease
Bowel cleansing can be very effective for any disease, but especially diseases of the digestive tract. I had many patients heal their upper gastro-intestinal problems like ulcers, hyperacidity, gastric reflux, hiatal hernia and indigestion, plus colon problems such as chronic constipation, spastic colons, colitis and Crohn’s disease—and yes, even hemorrhoids. Even liver and gallbladder problems are often relieved, because the same herbs that cleanse and detoxify the bowel also stimulate, cleanse and detoxify the liver and gallbladder.
Many people write me to ask about polyps and bowel cancer, which often go hand in hand. Although I am banned from telling you about my many specific patients healing their serious bowel diseases, like cancers, here is a story I got from an American Botanical Pharmacy customer in San Diego, California a few years ago. He was in his 60s and because of a family history of degenerative bowel disease and colon cancer, his son asked him to go to the doctor and get a sigmoidoscope check – a look into the bowel. This is getting to be a routine check now for older folks, to look for bowel cancer or other bowel disease.
Well, sure enough, they saw it, a big cancer they said looked like a big mushroom growing in his sigmoid colon. It had metastasized and invaded into the muscle, maybe even farther. He also had around 35 polyps. The doctors wanted to admit him to the hospital immediately for a colon resection. They wanted to gut him and carve out at least 12 inches of his colon, probably more. He was very scared.
Healing Colon Disease Naturally 56
Healing Colon Disease Naturally
His son suggested that his dad do my Bowel Cleansing Program. The dad asked the doctor if he could delay the colon surgery for a few months, while he did an herbal bowel cleanse. The doctor said he was nuts, the herbs could be dangerous and even if they weren’t they were useless and that a delay of a few days, let alone months, could be suicidal. The cancer would just grow worse, spread, metastasize and kill him.
The dad told me that he was more afraid of the doctors and their surgery. So, he decided to go on my 5-Day BOWEL Detox. After eight weeks of bowel cleansing using 8 entire jars of Intestinal Formula #2, three bottles of Intestinal Formula #1, double doses of SuperFood Plus and lots of Echinacea Plus, he went back for another look by the doctor. The doctor was furious, and said that surgery may not even save him now, because he delayed getting proper professional treatment by playing around with some hocuspocus herbs. But when the doctor looked in the colonoscope, he literally shrieked, “Oh my God, I don’t believe it!”
Not only were all 35 polyps gone, disappeared, not a trace of even one, but the cancer looked like a dried up skeleton of a cancer. (This is exactly what cancer looks like after your body and especially your white blood cells eat up a tumor.) He said the doctor then touched the cancer skeleton with a tool through the scope and that it just fell off the walls of the bowel. The CANCER JUST FELL RIGHT OFF!
I had hundreds of patients with bowel polyps that got rid of them. I had many other patients with bowel cancers that disappeared. I had other patients with supposedly unrelated problems like clinical depression, dementia, arthritis, neurological diseases—the list is endless—who all got relief from doing a thorough bowel cleanse.
To actually GET WELL, you have to correct the cause of the disease, and more often than not, it’s your bowel.
57
I had a patient come to me with chronic migraines. They were so severe, that she would even go blind during some of the attacks. Her daughter told me that sometimes she would fall to her knees in public, scream she couldn’t take it anymore or even black out and faint. She went to her medical doctor, who gave her some painkillers, and the migraines went away, but eventually they came back. She asked the doctor for something stronger, and he eventually prescribed narcotics. The pain went totally away, but eventually it came back.
She then went to see an Oriental medical doctor who did acupuncture on her, stuck hundreds of needles in her. She said she felt like a human pin cushion. The pain disappeared, but returned.
Out of frustration, she went to a friend’s chiropractic doctor who noticed that her cervical vertebrae were subluxated. After a series of adjustments her pain went away, but eventually it came back. Out of desperation she went to a Rolfer, a great system of deep tissue body work, and he did some real restructuring of her neck muscles and tissue, in fact her whole body. The pain was totally gone, but eventually it came back.
Finally, she ended up at an herbalist. He prescribed a classic old herbal formula for pain, actually a great effective formula and one that I used often in my clinic. It was a miracle. Her pain completely disappeared, GONE!
...But eventually it came back.
After 3 years of blinding pain, seeing 16 different doctors and spending thousands of dollars on everything from electrode stimulators and biofeedback devices to drugs, herbs, vitamins, enzymes, colloidal silver and Noni fruit drinks, she finally crawled up to the doorstep of my clinic and told me her story.
Within the first 2 minutes of her very first visit, I asked her one of my favorite questions. How often do you have a bowel movement? It turned out she only went once or twice a week. I suggested that
Healing Colon
Naturally 58
Disease
before we do anything, we do a thorough bowel cleansing routine for a couple of weeks. She was furious. She screamed at me and demanded I give her my migraine formula. She was literally sobbing, in tears, begging, pleading for relief. I gave her my 5-Day BOWEL Detox and sent her home.
After a few days, she called me and told me that her migraines were gone, right after an amazing pooping experience on the toilet, but she was afraid they would return like they had done with ALL the other doctors and practitioners. Over the next few months, I put her through all of my programs and cleaned her colon out a few more times and the migraines have never returned. That was thirteen years ago. The problem with all of the doctors that she saw before me was that they were all focused on the pain in her head, about 3 feet above the real problem.
I had another lady come to see me. She had been out of work, literally flat on her back in pain for 2-1/2 years. She had pain in the lumbar vertebrae, sacrum and sciatic nerve, EVERY DAY, ALL DAY. No work, not even housework, not even going shopping for a few groceries. She was 100% crippled—a total wreck. The medical doctors wanted to fuse her spine, maybe even cut the sciatic nerves to relieve the pain. This is a total dead end. She had many visits to her chiropractor along with Hatha Yoga, which are two of the best therapies for any spinal problem, and especially lower back problems, but she got little results. The osteopaths and orthopedic treatments didn’t help either, and she was at her wits end. She even told me she was contemplating killing herself.
Guess what? She was constipated! I put her on the 5-Day BOWEL Detox and in less than a week all of her pain was gone, and never returned. She was shocked, in disbelief, and she was really, really mad at all the doctors for overlooking something so simple: constipation. Her blocked, engorged, swollen colon had been pressing on all the nerves in her lower back the whole time.
So even if a person thinks that their particular problem is unrelated to the colon, they might be wrong. A swollen,
59
Colon
Healing
Disease Naturally
constipated, irritated bowel puts pressure on and infects everything around it. The nerves from the spine run right next to the bowel before they go down the legs. I have had hundreds of patients with chronic back pain, sciatica and leg pain, and it all disappeared after a good bowel cleansing program.
No matter how far removed the problem seems from the colon, no matter how ridiculous it may seem to do a bowel cleansing program instead of brain surgery, cleanse the bowel first and see what happens.
How Could So Many Seemingly Unrelated Health Problems Be Caused By Constipation?
I remember when my older brother got his first car. It was a 1950 Ford station wagon. Of course, it didn’t run. What kid’s first car did? So it sat in our driveway, and we would sit in it dreaming of the day when we would be burning rubber down the highway. Being more mechanically inclined, I did most of the work on it to get it running.

I used to be able to open up the hood, sit on a front fender with my feet and legs actually dangling inside the engine compartment and work on the engine, change spark plugs, whatever. Get the picture? Big car, big hood, little engine, lots of room. Nowadays, I open up the hood of my current Ford and I just shut it right back
Healing Colon Disease Naturally 60
up. Every square inch under the hood is jammed, packed with engine parts, power pumps, wires, hoses, pipes and filters. It is too complex, and even if I understood it, there is NO ROOM to work on it. NO SPACE!
What’s my point? I used to think our anatomy was like my brother’s 1950 Ford. You know, a lung up here, a kidney way down there, a bowel in the middle, with lots of room. Then one day in school, I examined my first cadaver and WOW, what an enlightening experience. The human anatomy is not like my brother’s 1950 Ford at all—it is like my modern Ford. Every square inch is packed with something and everything is touching something else. This body of ours must have had some incredible engineer. Everything has its place and THERE IS NO EXTRA ROOM! If one organ swells or gets bigger, then another organ (usually the one next to the swollen one) gets squeezed, compressed or crushed. Organs don’t work so well when they are crushed and the blood, lymphatic, nerve and general circulation gets interrupted. Every organ needs good circulation to get nutrition in and get waste out in order to be healthy. Squeezed and compressed organs get sick.
Now the entire colon is so big that it is connected to, touches, sits next to or is in the vicinity of every major organ in the human body except the brain. It also touches most of your major blood vessels and nerves. Constipation causes the colon to literally swell, expand and even herniate. Remember that the leading medical books told us that all of us store too much fecal matter and have this happening inside of us. So when an area of the colon gets constipated and swells, it compresses and crushes the organ next to it. This could be the lungs, the heart, the liver and gallbladder, the pancreas, the kidneys and adrenals, the uterus, the prostate–again, almost every major organ in the body.
This is simply why a constipated, swollen colon can cause an almost endless amount of seemingly unrelated diseases and problems, and I haven’t even discussed toxic build-up in the colon that literally infects and poisons nearby organs.
61 Healing Colon Disease Naturally
The majority of patients in my clinic were female. Many women could never understand the relationship between their painful periods, PMS, menstrual irregularity, vaginal infections, infertility, menopausal problems, problems during pregnancy, whatever, and their constipation, until I explained that their sigmoid colon wraps around the uterus and that their ovaries are literally attached to the colon. The cure for almost every female problem in my clinic, besides my Female Formulae, was a good bowel cleansing.
Men, don’t try to wriggle out of this one. It’s the same for you and your prostate, which is attached to your intestines, and the part of your colon that swells and gets constipated most often, crushing and infecting the prostate.
The point is there is NO EXTRA SPACE in your body. If your bowel swells due to constipation and bowel pockets, another organ gets pinched, if not crushed.
What’s the bottom line? A sluggish, constipated, swollen bowel, retaining pounds of old fecal matter, can either compress a nearby area and causing disease, or emit infection and toxins which can affect and infect any area of the body.
This explains why many of my patients healed their heart problems, blood pressure problems, breathing problems, blood sugar problems, hormone imbalance problems, fertility problems, liver problems, cholesterol problems, immune problems, urinary problems, adrenal and lack of energy problems, prostate problems, digestive problems, lower back problems, leg circulation and nerve problems by cleaning out their colons, before I ever did any specialized treatment for their problem. This explains why so many of my patients healed their almost infinite list of various diseases by doing my 5-Day BOWEL Detox. My patients healed their brain diseases with colon cleansing proving that you can’t have sweet thoughts on a sour stomach.
I had many patients with Alzheimer’s disease and many different types of dementia that turned around and healed themselves after a complete bowel cleanse. And I don’t mean people who were just
Healing Colon
Naturally 62
Disease
a little foggy and forgetful. I had patients who howled like wolves on the full moon. They were totally insane, but with the aid of their friends, relatives and my herbal programs, they were able to heal themselves and live normal lives.
Clinical Depression Healed
I had a patient come to me with clinical depression, one of the worse cases I ever saw. He used to be a brilliant man and now he couldn’t even speak or get himself dressed.
His family brought him into my clinic, where he sat on the couch in the waiting room with his head sunken and glued into his hands. This poor man was frozen stiff and a tow truck couldn’t get him into my examination room. So, I just sent him home. I asked the family to start him on the basics, but all they did was my 5-Day BOWEL Detox.
Over the next few months, this man evacuated some ungodly stuff. The family said it stunk up the entire house, and even the next door neighbors complained. But to everyone’s surprise, this man started coming back to life and within a few months was back to normal and a month or so later back to work. JUST BY CLEANING OUT HIS COLON!
Everyone wants a quick cleanse. Sure, party for a decade and then try to clean up the whole mess in a few minutes. It’s not going to happen.
Any cleansing or detoxification program is a TOTAL JOKE, unless you do a thorough bowel cleansing for a few weeks FIRST!
Never, Never, Never Underestimate The Power Of Colon Cleansing
When I ran my clinic, new patients were often upset when I told them we had to start with a thorough colon cleansing. What they wanted was my secret energy pill, youth pill or something to make their insomnia, infertility, back spasms, headaches, diabetes, arthritis, whatever, miraculously go away.
63 Healing Colon Disease Naturally
Natural Healing is NOT about temporary quick fixes or pills to mask symptoms. It is NOT about cutting, poisoning and burning out disease. That’s what medical doctors do. When you take that approach, often out of nowhere, your disease returns with a vengeance, much worse the second time around.
Natural Healing is about getting to the root cause of disease and illness, correcting it, and then building a healthy lifestyle so your body can do its best healing possible. Then, you can enjoy a long, healthy and energetic life.
Natural Healing Is Not About Dr. Schulze Healing People. It’s About… People Healing Themselves
So, I had to kick some butt and do some convincing to get my patients to understand why a belly full of old poisonous, toxic fecal waste and sluggish elimination was probably the cause of their problem. If it wasn’t the direct cause, it was surely an indirect one.
You should have seen the surprised looks on all of their faces when after completing my 5-Day BOWEL Detox, their aches and pains were gone. About 80% had total relief from their health problems without addressing them directly.
My Patients Thought I Was
Father Schulze, Not Dr. Schulze
Most of my patients came into my clinic with a very guilty conscience regarding their lifestyle. They wanted to repent their sins of junk food and debauched living. They thought I could just wave my hands over them and have them say a few “Hail Tofus” and everything would be OK. Well, it’s not quite that simple. Most had already tried some kind of detox on their own, with either no results or bad results. Everyone nowadays is selling some quick detox. There are a few problems here.
First, don’t fool yourself. It takes most of us 20 or 30 years of rough and tough living, before we develop a disease. So, you’re not going to heal yourself in 24 hours.
Healing Colon Disease Naturally 64
Secondly, I made my patients EARN the right to do a detox program. The reason for this is simple. When you start any detoxification program, what happens is that you dislodge and dissolve poisons and toxins that have built up in your fat and muscle cells and in various organs. During an effective detox, when these wastes are dissolved they are deposited into your colon for rapid elimination from your body. If you are constipated or not having regular frequent bowel movements, these poisons sit there, and can reabsorb and make you really sick. This is why many people who undertake a detox program without first making sure their colon is working, feel weak, shaky, nauseous, headachy or HORRIBLE. I had patients that literally almost died doing intensive detoxification programs with hot saunas, gallons of juices, herbs, whatever, but hadn’t had a bowel movement in weeks and the detoxification almost killed them.
This is why BEFORE you even think about any intensive detoxification program, THE COLON MUST BE ACTIVELY WORKING AND CLEAN!
First Things First!
This is worth repeating. The first step in any health program, especially BEFORE any blood and lymphatic cleansing or detoxification program, is to cleanse and detoxify the bowel. You must make sure it is working frequently and effectively and also make sure all of the old, toxic fecal material is out of the colon. Then, you will enjoy an effective detoxification program, feel great while you’re doing it and get the most out of it.
So the first step is my 5-Day BOWEL Detox discussed in the next chapter...
65 Healing Colon Disease Naturally
The Solution: Dr. Schulze’s 5-Day BOWEL Detox
DR. SCHULZE’S 5-DAY BOWEL DETOX




� ELIMINATE constipation and promote regular, healthy and complete bowel movements!
� A POWERFUL intestinal vacuum that draws out old toxic fecal matter!
� Have more ENERGY, feel lighter and have a flatter stomach!
66
THE SOLUTION: DR. SCHULZE’S 5-DAY BOWEL DETOX
Remember... Cleansing your colon is THE most important first step to better health.
Today, more than 100,000 people worldwide have used this very simple and effective program to eliminate constipation, cleanse their colon, detoxify their body and heal and prevent colon disease.
No matter how far removed your current health problem seems from your colon, cleanse the bowel FIRST and see what happens. If you’re like my patients, you will be thrilled with the results.
A Powerful, Effective And Complete Cleansing Program For The Colon
The first step to powerful health and the best way to prevent disease is to clean out and detoxify your colon on a regular basis. Of further importance is to train your bowel to empty itself on a regular basis, 30–60 minutes after every main meal, two to three times a day. My 5-Day BOWEL Detox will help you achieve both of these goals.
How To Begin:
The first thing you must determine before you begin this program is how often you have a bowel movement. That will decide how you start.
67
CHAPTER 7
START HERE – If you are currently skipping days without having a bowel movement...


...start using the Intestinal Formula #1 only. It is best not to rush and not to use the Intestinal Formula #2 right away. Let’s get your bowel working better first. The reason for this is simple. You are already a bit constipated and sluggish. Your bowel is not active enough to use the Intestinal Formula #2, which could constipate you even further. Don’t worry, there are more than enough Intestinal Formula #1 capsules in your bottle to do this and complete the entire 5-Day BOWEL Detox.
So start by taking one capsule of Intestinal Formula #1 with or just after dinner. It is best to take this formula with food. If the next morning you do not have a good, complete bowel movement, or none at all, this evening take two capsules with or just after dinner. Continue to increase the dosage of Intestinal Formula #1 by one capsule each evening until the next morning, when you sit on the toilet, you have a complete bowel movement. A complete bowel movement may consist of a larger volume than you would normally see in the toilet bowl, or you may experience two or three intestinal waves of fecal matter elimination. So don’t be too quick to get off the toilet. Your bowel movement may also be loose, even a bit like liquid at first. You may also experience a bit of gas or cramping. All of this is normal.
When you are having one or more bowel movements a day for an entire week, without skipping, you may now begin taking the Intestinal Formula #2 (follow the directions on the next page). You must continue using the Intestinal Formula #1 at your current dosage and even increase your dosage by one or two capsules when you begin the Intestinal Formula #2.
68
The Solution: Dr. Schulze’s 5-Day BOWEL Detox
90-ct
250-ct
The Solution: Dr. Schulze’s 5-Day BOWEL
START HERE—If you are currently having one or more bowel movements a day...


...then you are ready to start using Intestinal Formula #2, along with Intestinal Formula #1.
If you are taking Intestinal Formula #2 capsules, then take ten capsules, five times a day, for the next five days. If you are taking Intestinal Formula #2 packets, then take one packet, five times a day, for the next five days. During this program, on average, you will be taking the Intestinal Formula #2 (capsules or powder) every two to three hours.
Follow dosage directions on product. Remember, when taking Intestinal Formula #2 capsules or powder, you must drink a minimum of 16 ounces of liquid with each dose. You may drink pure water, herbal tea or fresh fruit or vegetable juice.
Important!
While taking Intestinal Formula #2, continue taking one or more capsules of the Intestinal Formula #1 every evening, with dinner or just after dinner. Most people under 150 lbs. need only one capsule, while those over 150 lbs. usually need two capsules. Intestinal Formula #1 does many things for your bowel, but most importantly it removes all the accumulated Intestinal Formula #2 from your bowel the next morning.
NOTE: If on the morning after taking your Intestinal Formula #2 you do not have a bowel movement, increase your liquid intake today and also increase your dosage of Intestinal Formula #1 this evening by one additional capsule.
69
Detox
Capsules
Packets
Important Helpful Tips
Tip #1: Educate Yourself
If you are unfamiliar with what is normal bowel frequency or normal fecal consistency, you may think that something is wrong at first. You may also experience abdominal feelings that you have not experienced before. What you are used to is not normal or healthy.
Tip #2: Don’t Be In A Hurry
It took you years to become constipated, so take a few weeks or a month using my Intestinal Formula #1 to get your bowel regulated, before you begin doing my complete 5-Day BOWEL Detox using Intestinal Formula #2.
There is no maximum dosage of Intestinal Formula #1. The record so far is 48 capsules in one day, so I am sure you haven’t reached that dosage yet. Many people need six, eight or even 12 capsules a day to get their bowel working normally. But, remember to increase by only one capsule daily. This way you won’t accidentally discover the “laws of jet propulsion.”
Tip #3: Special Advice For People With A “HOT” Metabolism
If you are prone to having a “hot” bowel, diarrhea, colitis, bowel inflammation, Crohn’s disease, etc., then you are better off with “cool” detoxifiers, such as my Intestinal Formula #2. You may never need, or be able to tolerate, my Intestinal Formula #1. Stay with Intestinal Formula #2 and use it periodically for a week or a month at a time.
Final Note
As a child, I had only one bowel movement a week. That was normal for everyone in my family. Also normal for my family was severe bouts of constipation, hemorrhoids, kidney stones, heart attacks and cancer.
70
Detox
The Solution: Dr. Schulze’s 5-Day BOWEL
The Solution: Dr. Schulze’s 5-Day BOWEL Detox
It took me 12 years of using my Intestinal Formula #1 and consistent bowel cleansing to get my bowel working normally. Then for the last 20 years, I have done my 5-Day BOWEL Detox about every season, 3 or 4 times a year. I currently have 2 to 3 bowel movements a day of perfect consistency, 20 to 30 minutes after every main meal.
My point is that just because I inherited a dysfunctional, constipated bowel didn’t mean I had to live with the suffering and illness that it caused me. With this exact program, I was able to clean out and train my bowel to work perfectly. For me and my patients, great health was something we had to earn.
If you have never before cleaned out your bowel and have now done my 5-Day BOWEL Detox, CONGRATULATIONS! This is a great start to a healthier life. I’ll say it again, this program is very simple!
71
THE 5-DAY DETOX FOOD
You can eat or drink anything during your 5-Day Detox, but to achieve maximum results, I suggest the following raw food and juice flush program.
Fresh fruit or vegetable juice is the best way to get your vitamins, minerals and other essential nutrients. They are also very important for cleansing and detoxification.
Day 1 & 5 (Raw Food)
BREAKFAST: If you’re hungry before lunchtime, you may have fruit, diluted fruit juice and fruit smoothies. Stop all fruit and fruit juice at least one hour before lunch. It is best not to mix fruits and vegetables, while on this program.
LUNCH: For lunch, you can have fresh raw vegetable juices, raw vegetables (alone or in salads), sprouts, potassium broth and herb teas. You may use dressings for your salads and vegetables, if you like—use olive oil, avocado, raw apple cider vinegar, lemon juice, garlic, onions and any herbs and spices.
AFTERNOON SNACKS: Raw vegetables, raw vegetable salads, diluted vegetable juices, sprouts, potassium broth and herb teas. All vegetable foods and juices must be stopped by 6pm.
DINNER: Diluted fruit juices, fruit, fruit smoothies, fruit salads and herb teas.
Days 2, 3 & 4 (Juice Flush)
Now, we begin the 3-day fast. Consume at least one gallon (128 ounces) of liquid a day. That’s eight 16-ounce servings a day. If you get hungry, DRINK MORE LIQUID!!!
MORNINGS: Start with water, your morning flush, herbal teas/tonics and your morning SuperFood Plus drink.
72
Detox
The Solution: Dr. Schulze’s 5-Day BOWEL
The Solution: Dr. Schulze’s 5-Day BOWEL Detox
AND JUICE PROGRAM
MID-MORNINGS: Diluted fruit juices, herb teas and water until noon.
AFTERNOONS: Diluted vegetable juices, potassium broth, herb teas and water until evening.
EVENINGS: Diluted fruit juice, herb teas and water in the evening.
Day 5 (Raw Food)
Day #5 is the day you will be breaking your fast. Your food program will be the same as Day #1. Breaking your fast is a very important part of this program. Chew your food slowly, mixing each mouthful with plenty of saliva. Eat until you are satisfied, not full. You can always eat more later, if you are still hungry. Chew everything to a liquid pulp.
POTASSIUM BROTH RECIPE
This is a great-tasting addition to any 5-Day Detox program. It will flush your system of toxins, acid and mucous while giving you concentrated amounts of minerals.
Fill a large pot with:
� 25% Potato Peels
� 25% Chopped Whole Beets and Carrots
� 25% White Onions and Garlic
� 25% Dark Greens
Add hot peppers to taste. Add enough distilled water to just cover vegetables and simmer on very low temperature for 1–4 hours. Strain and drink only the broth. Make enough for two days, and refrigerate the leftover broth. Use only organic vegetables! We do not want to consume any toxic, immune suppressive insecticides, pesticides or inorganic chemical fertilizers while we are on a detoxification program.
My broth will flush you out and build you up. Start it now!
73
FOOD
The Solution: Dr. Schulze’s 5-Day BOWEL Detox
Intestinal Formula #1


� Promotes regular, healthy and complete bowel movements
� Stimulates and strengthens the muscular movement of your colon
� The best bowel cleanser on the planet
BOTANICAL INGREDIENTS:
Curacao & Cape Aloe Leaf, Senna Leaves & Pods, Cascara
Sagrada Aged Bark, Barberry Rootbark, Ginger Rhizome, Garlic Bulb, African Bird Pepper
Intestinal Formula #1 stimulates your colon’s natural muscle action and strengthens the muscles of the large intestine. It relieves constipation. It also halts putrefaction and disinfects, soothes and heals, improves digestion, relieves gas and cramps, increases the flow of bile which in turn cleans the gallbladder, bile ducts and liver, destroys Candida albicans overgrowth and promotes a healthy intestinal flora. It also destroys parasites, increases circulation and is anti-bacterial, anti-viral and anti-fungal.
The herbs in this formulae, like Aloe, Senna and Cascara
Sagrada all contain the natural phytochemical (plant chemical) called Emodin, which increases peristaltic waves, the propulsive contractions of the colon muscle. Oregon Grape Root stimulates and flushes the liver, the gallbladder and the production of bile. Garlic is anti-bacterial, anti-viral and anti-fungal. Habanero and
74
90-ct 250-ct
The Solution: Dr. Schulze’s 5-Day BOWEL Detox
Ginger are both powerful stimulants to the colon. Habanero will also correct intestinal bleeding.
If your bowels are irritated, inflamed, hot or working too frequently, skip Intestinal Formula #1 and go directly to Intestinal Formula #2.
Intestinal Formula #2


� A powerful intestinal vacuum that draws out old fecal matter, toxins, poisons, bacteria, drug residues, mercury and lead
� A strong anti-inflammatory and soothing agent
BOTANICAL INGREDIENTS:
Flax Seed, Apple Fruit Pectin, Pharmaceutical Grade Bentonite
Clay, Psyllium Seed & Husk, Slippery Elm Inner Bark, Marshmallow Root, Fennel Seed, Activated Willow Charcoal
Intestinal Formula #2 is a strong purifier and intestinal vacuum. It draws old, hardened fecal matter off the walls of your colon and out of any diverticula.
Intestinal Formula #2 contains the three most powerful and effective absorbers and neutralizers known: clay, charcoal and pectin.
Our Pharmaceutical Grade Bentonite Clay will actually absorb up to forty times its weight in intestinal fecal matter and waste. It also smothers and draws out intestinal parasites. The Activated
75
Capsules
Packets
Willow Charcoal is the greatest absorbing agent for every toxin and poison known. It will absorb and render harmless over 3,000 known drug residues, pesticides, insecticides and just about every harmful chemical known. This is why it is the active ingredient in nearly every water filter made today. Apple Pectin draws numerous harmful substances out of your intestines, especially heavy metals like mercury and lead, and carcinogenic radioactive materials.
The addition of Marshmallow Root along with Psyllium Seed and Flax Seed makes the formula mucilaginous as well as demulcent. Mucilaginous means that all the water and herbs can sit in your bowel, soaking against the internal wall of your colon, softening and breaking up old, dried and hardened fecal waste that may have been in you for years. Demulcent means it will also ease the pain and suffering of a hot, irritated and inflamed intestinal mucous membrane. It literally heals the tissue! From stomach ulcers to colitis, Crohn’s disease, IBS, spastic colons, and all types of inflammatory bowel diseases, mucilaginous and demulcent herbs are the healing answer.
Your body knows how to heal itself from every disease. All it needs is your help.
76
The Solution: Dr. Schulze’s 5-Day BOWEL Detox
“ The first and most important step for preventing and healing disease is Bowel Cleansing.”
77
Solution: Dr. Schulze’s 5-Day BOWEL Detox
The


CHAPTER 8
ADDITIONAL PRODUCTS TO RELIEVE CONSTIPATION
If you suffer from constipation, here are two more formulae I created to give you amazing results!
Intestinal Formula #3

4 ounces
� Promotes soft and easy bowel movements
� Strengthens colon muscles
� Tastes great to kids of all ages
BOTANICAL INGREDIENTS:
Senna Leaf & Pod, Cascara Sagrada Aged Bark, Anise Seed, Clove Bud, Tangerine Oil, California Fig Concentrate
79
This formula is a great-tasting, liquid laxative for the whole family. Although I originally designed this herbal colon cleanser primarily for children, it’s strong enough for adults, too. In fact, many adults prefer it instead of Intestinal Formula #1, because it has a milder action.
Every year, hundreds of parents brought their babies, toddlers and children into my clinic. Some were very constipated. I had some babies that were so constipated, they had fecal matter backed up into their stomachs. One little eight-month-old baby in my clinic, who was actually scheduled for colostomy surgery, actually regurgitated fecal matter. I am happy to say that this child never had the surgery.
In the clinic, I saw hundreds of children and teenagers with extreme constipation. This formula saved all of them from torturous, disfiguring and life-altering colon surgeries. In fact, all of these constipated kids improved in just a day or two after starting this formula.
Like my Intestinal Formula #1, my Intestinal Formula #3 also contains Senna Leaf and Pod and Cascara Sagrada Aged Bark. Both contain the natural phytochemical (plant chemical) called Emodin, which increases the normal muscular contractions (peristalsis) of the gastro-intestinal tract, especially the colon. This formula promotes soft, easy bowel movements and it will help strengthen the colon for better future elimination.
Figs and prunes have been used effectively as a natural treatment for constipation since the beginning of recorded medical history. The base of this tonic, California Fig concentrate, acts not only as a mild natural laxative, but also makes the formula sweet and taste good for the kids.
Anise Seed and Clove Bud are strong carminatives and antispasmodics and therefore are used to relieve gas, cramps, colic,
80 Additional Products
indigestion, nausea and stomach aches. Tangerine Oil is antibacterial, but is also used to mask and flavor the formula.
You can’t have SWEET THOUGHTS on a sour stomach.
DOSAGE:
Start with 1 teaspoon daily. Increase if necessary by 1 teaspoon each day until desired effect is obtained. This formula works best if taken with food. We suggest during or just after dinner.
Children’s Dosage:
Children vary dramatically in size and shape. One 5-year-old can be very different from another. In my clinic, I found the safest and most effective way to dose children was by weight. After all, we want to adjust their dosage by how much their metabolism can handle, not by their age. The surest way to do so is by weight.
An adult dose is based on the adult weight 150 pounds. So, to calculate any child’s dosage, simply make a fraction of the recommended adult dosage. Just look at the following example:
A Child of:
30 pounds = 1 of the 150 pounds 5 adult dose
81 Additional Products
Intestinal Formula #1 - MAX

� PROMOTES regular, healthy and complete bowel movements
� STIMULATES and STRENGTHENS the muscular movement of the colon
� New STRONGER and more POWERFUL formula
HERBAL INGREDIENTS:
Curaçao & Cape Aloe Leaf, Senna Leaf & Pod, Cascara Sagrada Aged Bark, Hawaiian Yellow Ginger Root, Habanero Pepper
This new MAXIMUM STRENGTH version of my Intestinal Formula #1 is for those who are taking more than 4 capsules a day of my original Intestinal Formula #1, and who need something even stronger and more effective. This is a very potent formula for those who chronically suffer from constipation and need relief right away.
About The Herbs In This Formula:
Cape & Curaçao Aloes, Senna Leaf & Pod and Cascara
Sagrada Aged Bark
These herbs have all been used for centuries, if not millennia, to stimulate and tone the muscles of the large intestine to be stronger, and promote more complete and more frequent bowel elimination.
82 Additional Products
Because these herbs offer so many health benefits, they were considered almost magical by the many cultures, who have used them and referred to them as Miracle Healers and Sacred Barks.
Ginger Root
This herb is a powerful carminative, that relieves gas and bloating in your intestinal tract.
Habanero Pepper
These peppers dramatically increase blood circulation flow and are a wonderful remedy for the intestines.
DOSAGE:
Start with 1 capsule daily. Increase by only 1 capsule each day until desired effect is obtained. This formula works best if taken with food. We suggest during or just after dinner.
83 Additional Products

SIX NATURAL WAYS TO GET YOUR COLON WORKING AGAIN
Here are some ways to stimulate your bowel.
People always forget the simple things that our grandparents knew. Often with patients, I would just get them to soak some prunes. I mean, when my plum trees ripen here in my orchard I don’t get one a day, I get four thousand in an hour. And then, the tree is bare three days later. So often what fruit is telling you is gorge on it, have massive amounts for a short period of time, do a plum cleanse. With prunes, you can just soak them in water, put them in a blender, add some apple juice, and for some people that’s enough. I found that for my patients most of them needed something to jump-start the engine, something to get that bowel working effectively. But there’s basically six natural ways to get your colon working.
The first one is to drink more liquid. The bowel can’t work properly without a minimum of two quarts, or sixty-four ounces of liquid, in a day. The fastest way to get your bowel to stop working is to dehydrate yourself. Your bowel needs water in order to process the fecal matter and get it out of your body. The second one is to eat more fiber. Fiber makes your bowel work. Sludge doesn’t. Animal foods are sludge. Refined flour products are sludge. We have to eat more fruits, vegetables, grains and sprouts. Adding more fiber and drinking more liquid can make your bowel work tremendously better. And the least altered something is from its natural form (the more raw it is), the more powerful it is. Then there are the natural laxative foods, like fruit. Fruits are great.
85
CHAPTER 9
Apples, dates, figs, bananas, just about any food that contains liquid. Stay away from the dehydrated fruits if you’re constipated, because they suck moisture out of your body and we’re trying to add more in. The fourth way is to move your body. Just walking creates peristalsis. Sexual intercourse creates peristalsis. Next are the positive emotions. You have to think positively. If you hate yourself, if you’re filled with fear, that’s a good way to shut your bowel down totally. And the last one is to get into the herbs. Herbs are foods, too. Start using some herbs to get your bowel stimulated.
DRINK MORE LIQUID.
You need to drink at least 2 quarts of liquid a day, if not more. Anything less than 64 ounces (2 quarts) of liquid a day doesn’t give your fecal matter enough hydration to come out normally and easily. So in other words, your fecal matter gets too hard and has a hard time leaving your body. Dehydration is the number one cause of constipation. The best liquids for you to drink are pure water (never tap water), herb tea and diluted fruit and vegetable juices.
EAT MORE FIBER.
You have to eat food with more fiber in it. There is no fiber in any animal food or any animal by-products. Let’s make it clear— there is ZERO FIBER in any meat, chicken, fish, eggs, dairy, cheese or any other animal food. Fiber makes you poop—it is that simple. Fiber is only found in NON-ANIMAL foods. So you want a high fiber vegetarian food program: fruits, vegetables, nuts, seeds, grains, beans and legumes. That’s where the fiber is.
1 2 3
EAT NATURAL LAXATIVE FOODS.
Apples, bananas, figs and dates are famous. Did you forget about PRUNES? Fresh, juicy organic fruits that have a high water content are always better than dried, but even dried fruits can be of help. As with tip #2 above, all non-animal food is fibrous, but grains are naturally very fibrous and help the bowels move. Go on a raw food program for a few days and you won’t have to worry
86 Six Natural Ways to Get Your Colon Working Again
about constipation at all, but you might need to make a map of all the nearest bathrooms.
4
MOVE YOUR BODY.
All movement excites peristaltic muscular waves, the muscular contraction of the bowel. Exercise will get your bowels working again. I’m not talking sit-ups, I’m talking walking, breathing, laughing, running, dancing, yoga, swimming, anything, but you’ve got to get up and move around.
5 6
POSITIVE EMOTIONS.
We have to reduce our stress level. Stress, fear and hate are strong emotions that will cause people to get constipated more than eating ten pounds of cheese a day. We have to learn how to release our stress. Laugh more, learn some jokes. Do some deep breathing during the day. Develop positive emotional habits and learn positive emotional phrases like “I love myself” and “I love my life.” You must learn that EVERYTHING is a blessing from God and even if it seems bad now, it is just because you can’t see the whole picture. Tomorrow is what you Believe and Do Today.
MY 5-DAY BOWEL DETOX.
Never underestimate the power of colon cleansing. My 5-Day BOWEL Detox is EASY, SIMPLE to do and extremely EFFECTIVE. In the clinic, I witnessed thousands of patients have a dramatic change in their lives, just by doing this bowel program. Approximately 80% of my patients healed themselves by just doing this program. Again...
Never, never underestimate the healing power of colon cleansing.
87 Six Natural Ways to Get Your Colon Working Again

CHAPTER 10 ALL ABOUT DIARRHEA
What it is, how it happens, and the natural cures...
We have all heard the old kids’ baseball song, “When your sliding into home and you fill your pants with foam, DIARRHEA!” Well, Diarrhea isn’t really a laughing matter. Most people don’t know it’s genetic. That’s right, it runs in your jeans. OK, enough with the diarrhea jokes.
Seriously, most people have experienced it and know what it feels like, but they really don’t know what it actually is let alone what causes it, why your body is doing it and most important, how to treat it, naturally. Well, read this chapter and you will be prepared the next time you or a loved one gets it.
What Causes Diarrhea?
What we call diarrhea is actually the end result of poisoning. Diarrhea in America is most often caused by food poisoning. Although there are stomach and intestinal virus, in my clinic, what my patients often referred to as the 24-hour stomach flu, was actually just plain and simple food poisoning. The most common types are bacterial poisoning from fish, especially sushi (raw fish) and from chicken, although any type of dead animal flesh or milk is a bacterial breeding ground nightmare and can cause it.
When traveling to third world countries, diarrhea may feel the same, but the cause is a bit different. In fact, it is so common in many countries they have many colorful slang names for it like
89
“Montezuma’s Revenge” or the “Mexican Hat Dance” in Mexico or Central America, and “Delhi Belly” in India or the “Katmandu Quickstep” in Nepal. Regardless of its name, and how you ingested it, it is almost always caused by accidentally ingesting other people’s fecal matter.
The most common way to get it is simply by drinking contaminated water or even the ice in your drinks or droplets of water on a washed glass. It can also be on any type of food. I know this is gross, but one of the triumphs of the civilized world and modern public health is that we have succeeded in separating our feces from our water supply, and the general environment, for that matter. The country you are visiting and surroundings may look very different, but the micro-organisms that cause traveler’s diarrhea are pretty much the same organisms worldwide. The reason that we get diarrhea when we travel is simply that peoples’ stool is more available in the environment: drinking water, on the street, on people’s hands, on flies and on the food itself. So the main way to get traveler’s diarrhea is by consuming organisms that have grown in someone else’s intestines. In other words, you have to eat someone else’s stool. In almost all developing nations, fecal matter is so widely strewn in the environment, it is almost impossible to avoid.
Recently, diarrhea caused by parasites is becoming so prevalent, it may surpass bacterial diarrhea. And, diarrhea caused by viral infections that lurk on cruise ships has also been rising dramatically.
The absolute best safeguard against getting diarrhea, whether due to bacteria, parasites or virus, is to always drink bottled water, which is available everywhere today. Contaminated water is the number one way people get infected. If no bottled water is available, which is extremely rare, you can use all types of water filters sold in backpacking, camping and survival stores. A last ditch effort is to boil and strain your water before drinking. Also wash your hands every hour and wash everything you eat, and don’t eat out, especially at street vendors or street cafes. But no
90 All About Diarrhea
matter how careful you are, in many countries you are almost certain to get it regardless of how careful you are, but you won’t get it as frequently or as bad, if you follow my advice. In countries like India and the many countries in Africa and Asia, you will probably get it within the first few days. Don’t worry, later I will tell you how to heal it and be comfortable almost immediately.
What Is Going On In Your Body?
I know that most Americans think of diarrhea as a disease, so it’s a surprise to them when I tell them that it is actually another beautiful and miraculous way that your body is protecting your health and taking care of you. Let’s face it, in America most of what we know about health has been advertising from the beef, dairy and junk food industries—and most of what we know about disease has been through the onslaught of magazine and television ads from the pharmaceutical industry. In other words, most of what we know about health and disease, we are told by someone who is trying to sell us something. So the information may be a bit slanted, if not totally absurd. For this reason, I will not mention any of my products in this article until the end in a special section titled, “Natural Cures For Diarrhea”, OK.
“Diarrhea is a natural protective function of your body. It is a response to intestinal poisoning. Normally, most of the water is removed from your fecal matter by your colon, which creates a normal partially formed stool. But when your immune sensors in your intestinal tract (the Peyer’s Patches and appendix) detect harmful toxic bacteria or micro-organisms, they immediately force your bowels to evacuate all its contents before the water is removed, while your feces is still in liquid form. This is done to remove toxic bacteria from your body, IMMEDIATELY, before it could penetrate your organs and hurt you, or EVEN KILL YOU.”
When we consume any liquid or food that is toxic to our body (bacteria, virus, fungus, parasites, any poison) we have numerous ways that our body detects it and neutralizes, kills and eliminates
91 All About Diarrhea
it long before the poison reaches our bowel. The tonsils are an immune aggregation and can detect all types of harmful organisms that enter our mouths and create an immune response against them. And if the tonsils miss them, well, just the PH of our digestive juices, the liver’s bile or the pancreas’ hydrochloric acid is enough to destroy just about any bug. We have numerous other passive and active defense mechanisms in our digestive tract long before any toxic micro-organism can reach our bowel, but if there are enough of them and they are resilient and toxic enough, well, sometimes they can reach there.
If they make it, they are often detected in the small intestine by the immune aggregation, a mass of immune system tissue called the Peyer’s Patches. Upon entering the illeocecal valve, the entrance to your colon, the first stop in your large intestine is the cecum. Perfectly placed in the very bottom of your cecum, the first resting place for feces in your colon is the appendix.
Your appendix is the immune aggregation of your colon. Again, an immune aggregation is the same as your tonsils, a mass of immune tissue and white blood cells ready and waiting to defend you against any attacker. Well, when the appendix detects any harmful organism that is still alive, that made it past all of your many immune defenses, well then it knows that this is either a lot of poison or very strong and harmful micro-organisms. So what do you think the best thing for the appendix to tell your bowel would be? Hold on to all of this disease causing and potentially lethal poison, or get rid of it as soon as possible. That’s right, to get this poison out of you the fastest way possible, to empty your bowels contents before you assimilate the water out of your feces, while your feces are still in a liquid state. So your body forces you to evacuate your very wet and watery feces as fast as possible, to protect you from assimilating any more poison. This is diarrhea.
Diarrhea is a general term to describe when a person’s stools are more liquid or more frequent than normal. In America, having 2 to 3 regular bowel movements a day, that are soft and not black hard as granite balls, is considered by some to be diarrhea,
92
All About Diarrhea
even though this is what normal bowel movements should be like. Diarrhea is when you have many fluid stools in a short period of time. The word comes from the Greek meaning “to flow through”. Dysentery, another word originating from the Greek, meaning “bad intestine” (the Greeks must have had a lot of diarrhea and dysentery) is when there is evidence that the harmful micro-organisms have invaded and perforated your intestinal wall and you will most often see pus, mucus and blood in the liquid stool, and be in a lot of pain and cramping. Although the words diarrhea and dysentery are often commonly interchanged, medically there is a strong dividing line between the two. Diarrhea can easily turn into dysentery, especially by going against what your body is naturally trying to do and by using medical treatment and using drugs.
Diarrhea is uncomfortable, painful, inconvenient, cramping, watery, foul-smelling, liquid stools, and often you have them many times a day, from 4 or 5 to 30. Because it is so uncomfortable and debilitating, the medical doctors and drug companies prey on your weakened state and offer you a drug or some potion to stop it. Do you really want to stop it?
Most all medical and drug treatments for diarrhea are to stop it. They are usually designed to stop your bowels natural peristalsis, the muscular contractions of your bowel. They are often referred to as bowel paralyzers. When taken, they stop the diarrhea by simply drugging and paralyzing your colon, so it can’t eliminate. This is very dangerous, and very typical of most medical and drug treatment that is usually designed to stop your body from doing what it is naturally trying to do, PROTECT YOU! Literally stopping your body from protecting you and healing you. When you drug paralyze your bowel, well, of course the bacteria or other organisms love this, and they multiply and you get worse (more poisoned that is) because your diarrhea is stopped. You may feel better for the moment, but as the bacteria grow, a relapse or a more lengthy recovery is certain. This is a very dangerous thing to do and can even be fatal.
93 All About Diarrhea
All About Diarrhea
Natural Cures for Diarrhea
First, when having any digestive system problem, from gas, cramps, indigestion, heartburn, acid reflux, nausea all the way to diarrhea and EVERYTHING in between, always use my Digestive Tonic. 1 to 4 droppersful in an ounce of water will help your digestion back on its normal downward path, increase all digestive peristalsis, which in turn stops nausea, relaxes cramping and relieves all the symptoms I mentioned earlier. For diarrhea, use 4 to 8 droppersful in 2 to 4 ounces of water. So even with diarrhea, my Digestive Tonic is wonderful, especially with the gas, intestinal bloating, cramping and pain.
The absolute cure for diarrhea that does NOT go against what your body is trying to do, but actually aids and assists your body in many ways is my Intestinal Formula #2.
First and foremost the Activated Willow Charcoal in the formula, (this is why it is a bit black in color) absorbs and neutralizes any toxic bacteria and poison, encapsulates it and renders it harmless. This is why you will find charcoal in EVERY water filter manufactured. It absorbs over 3,000 known types of harmful bacteria, micro-organisms and other chemicals, toxin and poisons. If the charcoal in your water filter missed the bacteria, the charcoal in my Intestinal Formula #2 will get it. Having this in the formula starts absorbing what is causing your diarrhea in the first place, the minute it reaches your bowel.
I also have Bentonite Clay in this formula that can absorb over 30 times its weight in toxic harmful substances and literally draws and vacuums this toxic material out of your bowel. It also contains Fruit Pectin, which removes other types of toxic material and residues.
These herbs absorb, neutralize and render harmless whatever you have been poisoned with while this material is still in your intestines. As a bonus, these herbs not only neutralize the poisons, but they also naturally coagulate your liquid stools so when they
94
come out they are not liquid, but have a thicker consistency which is far more comfortable.
Second, the mucilaginous herbs like the Psyllium Seeds, Flax Seeds, Marshmallow Root, Slippery Elm Inner Bark and Fruit Pectin will also give you thicker more gelatinous, semi-formed and thicker consistency bowel movements, even though they may still be frequent until all the bacteria is gone. This is a pleasant rest from frequent brown water diarrhea discharges. Instead, you will be having less frequent and slightly formed bowel movements, instead of watery discharges. Not only is this far more comfortable, but it can help you to avoid hemorrhoids as well. The mucilaginous herbs also soothe an inflamed, damaged, raw and bleeding intestinal lining and heal it fast.
Use one packet of the powder or a heaping teaspoon of the bulk formula, at least five times or more a day, shaken in liquid as directed on the packet (or the bulk jar), but you can use it every hour if necessary. Stop all food and fast until you are healed.
Also, I know you don’t want to think about more pooping at a time like this, but often diarrhea is followed by constipation so have your Intestinal Formula #1 or Intestinal Formula #3 ready and waiting. Also, a few days after a bout of food poisoning or traveler’s diarrhea is a perfect time to do my entire 5-Day BOWEL Detox.
My friends, shit diarrhea happens. Everyone experiences it at some time in his or her life, whether you’re a world traveler or just eat out occasionally at your local neighborhood grill.
The best way to avoid diarrhea is drinking clean water and eating clean food, especially when you are traveling. But also be prepared, and always have your Intestinal Formula #2 on hand at home, in the glove box of your car, and anywhere you travel.
95 All About Diarrhea

“Your body has a BLUEPRINT, a SCHEMATIC, of what perfect health is and is constantly trying to achieve this goal for YOU.”
— Dr. Richard Schulze
CHAPTER 11
IS YOUR APPENDIX NECESSARY?
For your education I would like to set this issue straight.
Well, who am I to judge God and Nature. Obviously EVERYTHING in your body, every part, every organ, every cell is necessary, or it simply wouldn’t be there. But we hear this time and time again, from some godless, ignorant medical doctor, “this organ has no use”, or “this is a vestigial organ leftover from when we lived with dinosaurs and we don’t need it anymore.” Well, if this theory of evolution was true, and we did live with dinosaurs, then wouldn’t we have evolved, eliminated or grown out of any unnecessary organs and systems in our body?
If there is one organ of the human body I have heard more ignorant medical doctors make this statement about, more than any other, it is definitely the appendix. For your education, and for theirs, I would like to set this issue straight.
Open any standard medical immune text and it will clearly tell you that the appendix is a lymphoid aggregation. Does this sound familiar? Yes, this is exactly the same as the tonsils. So you could call the appendix, “the tonsils of the bowel.” As we know, any lymphoid aggregation, is a mass of lymph tissue, loaded with white blood cells, perfectly placed in an area to warn our immune system of invasion by bacteria, virus, fungus and other harmful micro-organisms, and is also the military base for immune cells to fight off any infection.
97
Is Your Appendix Necessary?
In fact, immunology textbooks also tell us that, once you get an appendectomy, the rest of your immune system doesn’t work as well, especially the spleen. The spleen is a major component of our immune system, and one of the major reservoirs for our white blood cells. I quote from medical textbooks: “The spleen’s regeneration of lymphatic immune follicles and white blood cells after an attack by harmful micro-organisms, is dependent on the presence of the appendix.” And, “the spleen’s potential to form antibodies is also dependent on the presence of the appendix. The appendix contributes to the recovery of the spleen’s antibody-forming capacity by the production of antibody-forming cell precursors.”
When the appendix swells and is painful (exactly like the tonsils), it is telling us that there is an invasion of harmful bacteria, and our immune system is excreting white blood cells, and IS DEFENDING US! We wouldn’t want to cut off our appendix any more than we would want to cut off our tonsils!
I could go on for hours about the pages and pages written about the function and necessity of the appendix in the maintenance of your health and having a functional strong immune system, but I believe I have made my point.
What Is Appendicitis?
The appendix is right below your illeocecal valve (the entrance to the large intestine). Here is the perfect placement to detect any pathogen or micro-organism that may be harmful to you, as food enters the final stage of digestion before elimination. If the appendix detects anything harmful, it will get inflamed, much like your tonsils, and go on the offensive to kill the pathogen before it can be digested and circulate into your bloodstream. This is one of the ways you can get “appendicitis”, and it’s actually your body protecting you, not malfunctioning, as some medical experts will tell you.
The other, more common way you can get appendicitis is from backed-up fecal sludge in your large intestine. See, the appendix is
98
located at the base of your ascending colon. This is the biggest antigravity and uphill trek for your digested food. Your appendix will actually excrete fluids to lubricate food and stimulate peristalsis (the muscular contractions of the colon that move everything along). But, if there are pounds of excess fecal matter sitting on top of your appendix, it can’t do this very well. If your peristalsis is weak, then the feces just sits there festering, becoming toxic, until the appendix swells, gets sick, and, if left unattended long enough… BURSTS!
I’ve worked with a lot of people with appendicitis. I had one rule in my clinic. Nobody goes to the hospital. And, I had a second rule in my clinic. Nobody goes to the hospital. And, I had a third rule in my clinic. Nobody goes to the hospital.
Now that we’ve established this simple first rule we can go on to...
Dr. Schulze’s Appendicitis Remedy:
STEP 1: STOP EATING NOW!

Don’t put anything in your mouth. Don’t. Stop eating immediately. You’re already stuffed. You’re so stuffed that poop is sitting on top of, and even inside of your appendix. So, stop eating.
STEP 2: GET THE GARBAGE OUT... FAST!

Get an enema. You’ve got to get that stuff out and give your appendix some relief. Natural Healing is very simple. It’s always just a matter of STOPPING what is hurting you, and STARTING what will help you. So, if you’re stuffed, and so much that your fecal matter is pushing into your appendix, stop stuffing and start eliminating. Dr. Christopher used to say that he gave so many enemas that one day he knocked on the door of one of his patients and they yelled, “Friend or enema?”
99
Your Appendix Necessary?
Is
Is Your Appendix Necessary?
Basically, you want to get your bowel cleaned out quick. You want all the fecal matter out of that bowel, all the way up the descending colon, across the transverse, down the ascending, all the way to the cecum. You might even be able to get some of that fecal matter out of the appendix. It could take an hour or two working to get that bowel clean.
Once you’ve done your enema, you want to consume lots of water and fresh juices. Start drowning yourself with fluid and flush your system. You might have a little fever too, so staying hydrated is important.
STEP 3: TAKE INTESTINAL FORMULA #1

The next thing is to take Intestinal Formula #1. It’ll take about 8 to 10 hours before you see the results of it, but take it anyway. Take it with some prune juice. Prune, yeah, any juice that will make you go. That would be the next thing to do.
Once the initial attack is over, I’d recommend doing my entire 5-Day BOWEL Detox and also making some changes to your food program, but first things first.
STEP 4: DO SOME BODY WORK!

Now, you don’t want to put your elbow right on the appendix and go for the gold, but you want to start some movement. The appendix is plugged up, so start some massage down at the iliac crest of the pelvis, and work your way up moving along the path of the large intestine. Also, get in the shower and do some hot and cold therapy right over the appendix where it hurts. This helps break up and move the congestion. Simply alternate with 15 seconds of hot water and 15 seconds of cold water for 7 repetitions (that’s 7 hots and 7 colds).
100
90-count
Final Thoughts
These simple things always got my patients over their appendicitis. I’ve had calls where I wasn’t able to be there, from all around the country, and I told people to do this exact routine and they got their children and their grandparents and everybody through their appendicitis. So it’s not too difficult. And, I have never, ever seen or heard of anybody’s appendix blowing up from doing this routine. They always got better. How soon? Three hours in some cases. Three days in others. It all depends on how sick you were. It depends on what you’ve been doing. Remember, the key is STOPPING what is making you sick and STARTING what will assist your body in healing itself.
101 Is Your Appendix Necessary?


FREQUENTLY ASKED QUESTIONS
The following are the most commonly asked questions and concerns about bowel cleansing.
What is the food program while doing your 5-Day BOWEL Detox?
The reason for doing my 5-Day BOWEL Detox in the first place is to first get your bowel to work better, more frequently, and more completely, to empty the waste out of your body. And secondly, it is to clean out old waste that has accumulated in your bowel.
The reason your bowel isn’t working well and has accumulated waste is because of what you ate. Food that is difficult to digest and assimilate and food that is difficult to eliminate—processed foods, cooked foods, junk foods. So it only makes sense that when you’re doing a bowel cleansing program, you wouldn’t want to be consuming those foods that caused your bowel problem. So although you can eat a varied food program while you’re doing the bowel cleanse, it would be nice to not be consuming the food that caused the bowel problem in the first place. Some people think they have to fast or just drink juices. That’s not true. Other people would like to do the cleanse and not really modify their food program much. That’s possible.
I would say for the average person, you can go ahead and consume food. But just make it so that during the 5-Day BOWEL Detox that you’re consuming clean food, the type of food that’s loaded with fiber. Preferably a vegetarian diet. Fruits, vegetables, nuts,
103
CHAPTER 12
legumes, seeds and grains and sprouts. This type of food is loaded with fiber, loaded with nutrition, and it’s not going to add to your bowel problem. In fact, it’s going to aid the 5-Day BOWEL
Detox in scrubbing out your intestines. What you want to stay away from are refined flour products, like bread and pasta. Those things you could glue wallpaper to the wall with. And you want to stay away from animal products. Why? Because all animal products—beef, chicken, pork, fish, eggs, dairy— everything that had a face on it or came from anything with a face on it, has zero fiber. All this is going to do is slow down your bowel. All animal (fiber-less) food is going to do is cause further constipation and further plaquing in your bowel. So the main food program you would want to follow would be a clean vegetarian food program.
Now, if you want to assist the bowel cleanse or if you have had chronic problems with constipation or chronic problems with accumulated waste in your bowel, go ahead and assist it by making the food program even lighter. Have a few days of juice flushing in there. Go ahead and consume food for a day on your normal vegetarian, healthy, clean food program. Then, have a day or two of raw foods. Then, have a day of juice cleansing. Then go back to raw foods, and then go back to the vegetarian diet. That would assist your cleanse, and certainly you can juice cleanse for the whole 5 days that you’re doing this bowel program. But for the majority of people, just a clean, healthy, fiber-full vegetarian food program is the best way to eat while you’re doing my 5-Day BOWEL DETOX.
What if I am afraid of doing the program?
For all of you out there who are afraid to start my 5-Day BOWEL Detox, afraid you might not make it to the bathroom, don’t be afraid. Your fear should be about going to a doctor. Your fear should be about ever having to go to a hospital. Believe me, the American Medical Association and the pharmaceutical industry have done a great job in brainwashing you if you’re afraid to begin your own self-treatment, create a healthier lifestyle and use some herbs to heal yourself. That’s exactly where they want you.
104 Frequently Asked Questions
My job is to empower you. Come on, we’re talking herbology and Natural Healing here. We’re not talking about nuclear physics or advanced calculus. This is simple, and it’s your God-given right to heal and cleanse and detoxify and build your strength and help yourself and your family members. So break free of that ironclenching fist of the AMA and the drug companies that want you to be stupid and led like sheep to the slaughter in the hospital. Believe me, that’s what they want.
I had thousands of patients in my practice, and believe me, I cleansed all their bowels, and they weren’t a bunch of out-of-work bohemians. They all worked for a living. In fact, almost all of them were in the television and movie and music industry, and they couldn’t just say, hey everybody, stop everything, I gotta go to the bathroom for about three hours. They worked regular jobs, they were regular people, and believe me, they all cleaned their bowels and they didn’t have to take time off of work. Granted, when you’re cleansing your bowels, you will notice that you have to go a lot more often. But it’s not a big deal. It’ll be very quick and complete. In fact, even if you go to the bathroom one extra time a day, I guarantee you, you’ll be spending a lot less time in that bathroom. You can throw out all the magazines, because you won’t have time to read anything. You’ll sit down, you’ll have your bowel movement, and you’ll be out of there in two minutes flat. So don’t use time as an excuse not to do the program.
What if I experience cramping while on the cleanse?
For those of you experiencing stomach cramps from taking the Intestinal Formula #1, relax. Any time you use a muscle that hasn’t worked in a long time, you’re going to feel it. This is no different than if you go to the gym for a week’s worth of new workout sessions after years of a sedate lifestyle and no exercise. Believe me, you’re going to feel it.
The analogy I always used with my patients in the clinic is, imagine you have an old car in the garage that maybe you inherited from your dad and you haven’t started it up in a few years, and you decide
105 Frequently Asked Questions
one day to go out, charge the battery and crank it up. Is it going to run smooth at first? Of course not. It’s going to shake, it’s going to rattle, it’s going to backfire from the carburetor and it’s going to smoke from the exhaust. And then maybe in 10 or 15 minutes, it’s going to smooth out and run nice.
So remember, when you first start taking the Intestinal Formula#1, you might have some cramping in your lower abdomen. You might feel it when you sit on the toilet the next day and that bowel starts to really work, the muscles contract, and you have a great bowel movement. That’s great. You’re alive. Remember, like that car, you might shake and sputter and skip and backfire and smoke and even stink a few minutes when you first start the bowel up, but I guarantee you, in a few weeks, in a month, that bowel is going to work and you’re going to be absolutely thrilled you started working on healing and strengthening it.
I’ve tried other colon cleanses and they didn’t work. How do I know yours is going to work?
In my clinic, I found that generally as patients came to me I’d say, “We’re going to do some Herbal Therapy.” They’d say, “I’ve tried herbs and they don’t work.” And, I used to get irritated by that. And then I went out and tried the majority of herbs, and I thought, they really don’t work. And, it’s not that the herbs don’t work. I’m not blaming the herbal manufacturers, because they’ve just been beat up by the government for the last 50 years in America, but the idea became, don’t make something that can cause any negative effects in anybody. Well, what that means is creating a product that won’t cause any effect at all. So in the clinic, I dealt with people differently. I figured we needed something strong. For some of my patients, I had to actually get out the old seventeenth and eighteenth century veterinarian books and come up with laxatives that were used for two thousand pound animals, like horses. That’s the degree of constipation that we have in America today. I had patients that went once a month, and that wasn’t unheard of. I had patients that went once every other month, a thirty-eight year old woman that went six times a year.
106 Frequently Asked Questions
Then I had a record-breaker, a young lady from Northern California, who went only three times during her pregnancy, and then two times outside that—so we’re talking five times a year. And my ultimate record-breaker was two bowel movements a year. So basically, I concocted an emergency, full-strength formula that my brother originally named Depth Charges, because I gave it to him years ago and he said his bowel is still working great to this day. So don’t worry about what any other herbal cleanses did or didn’t do for you. Just trust me and try my 5-Day BOWEL Detox.
How many times should I do your 5-Day BOWEL Detox?
A lot of people wonder how many times they should do my 5-Day BOWEL Detox. The answer is easy, and it applies to all cleansing. My patients, once they were well, once they were feeling great, with energy and vitality, and free of disease, I would suggest that they do one of my 5-Day Detoxes once every season. So, that’s four times a year for a week. For most of my patients, I suggested my 5-Day BOWEL Detox in the Spring, my 5-Day LIVER Detox in the Summer, my 5-Day KIDNEY Detox in the Fall and my 5-Day BOWEL Detox again in the Winter.
Should I do the 5-Day BOWEL Detox while doing either the 5-Day LIVER Detox or 5-Day KIDNEY Detox?
A lot of people ask if they should be taking the Intestinal Formula#1 and #2 during the Liver and Kidney Flushes, and the answer is yes. Any time you’re fasting, any time you’re flushing, when you’re doing your seasonal cleanse, any time you’re cleaning yourself out, the foundation of any cleansing is the bowel program. You need to keep that bowel working and activated so that any debris that you’re cleaning out of your body can get out immediately. Whatever program you’re doing, make sure you’re cleansing your bowel.
I saw many patients who had gone through many types of detoxification programs, and in the middle of those programs got themselves into deep trouble and came running to my clinic for help. And I was amazed at how many different so-called hip or sophisticated cleansing programs did not include getting
107 Frequently Asked Questions
the bowel working. I know some groups that put you in saunas and have you drink liquids, and that’s great, that can really purge poisons out of your body—but, if you haven’t had a bowel movement in a week, you’re going to be in a lot of trouble.
The foundation of any cleansing program or routine has to be getting that bowel working. In fact, it should have been working long before you even thought about another detoxification. Remember, in my clinic, I said you had to earn a cleanse by doing your homework up front.
Can I still do the 5-Day BOWEL Detox if I’m pregnant or nursing? And if I’m nursing, is it harmful to the baby? No, it is not harmful to the baby, and yes, you can do it while you’re pregnant. In fact, you can do any of my programs. In extreme situations, where mom was going to die before delivering the child (in other words, maybe mom was given a month or two to live and the baby wasn’t ready for five months), I even had moms do the Incurables Program, my thirty-day intensive cleansing and detox program, because mom was going to die and we were going to lose the baby. But in a normal situation, yes, mom can do any of these programs while she’s pregnant. You just want to use your common sense. Certainly SuperFood Plus is the best for pregnancy and for nursing, because you’re feeding either the fetus or that baby the best blood and then, once it’s born, the best milk that you can imagine. Because you’re fortifying your blood and your milk with SuperFood Plus.
The Intestinal Formula #1, well, here’s where the common sense comes in. You shouldn’t be sending yourself into an extensive, intensive, cathartic bowel movement in your eighth and a half month of pregnancy, unless you want to bring on labor. That said, you can use your Intestinal Formula #1 even in your third trimester, that’s no problem. Just don’t cause some major bowel catharsis. Keep it simple and lower your dosage.
108
Frequently Asked Questions
Once you have your baby, if you want to use your Intestinal Formula #1, that’s fine. But remember, any herb you take will get through your milk into your baby on a reduced level. So you’re also going to be treating your baby, too, which is great, because if your baby has an infection, you can take high dosages of Echinacea Plus, and it will get through the breast milk into your child. So yes, you can do all the programs when you’re pregnant and when you’re nursing. Just use your head and your good common sense.
Can I take Intestinal Formula #1 indefinitely?
Most people start taking the Intestinal Formula #1 and feel great. They love it. They’re having regular, frequent, complete, full bowel movements, probably for the first time in their life. They feel great, they’ve lost weight, their tummy’s flat, but then they wonder, can I take this formula for a while or a month or six months or a year, or even indefinitely? And of course, the answer is very simple. To poop or not to poop... that is the question.
The downsides of constipation are endless and infinite. You can have sickness, illness, disease, immune weakness, low energy, back problems, headaches, leg pain, menstrual irregularity, hormone imbalance, emotional problems, bad digestion, poor assimilation... numerous diseases, including diverticulosis and herniation of the intestine due to impaction. Modern medicine says that a hundred percent of Americans, before they die, are going to have herniated intestines due to constipation. I saw hundreds of patients that developed cancer in the bowel simply because of constipation. I also saw every disease, every illness, no matter what it was, helped by cleaning out the bowel.
You may think that your disease or your problem is totally unrelated to your bowel, but let me tell you, the old Natural Healers knew it, and they were right. You clean out your bowel and miracles can happen. Now, for those whose diet and lifestyle inhibit them from having regular bowel movements, or those who have inherited sleepy and sluggish bowels, I couldn’t suggest using this formula
109 Frequently Asked Questions
enough to get your regular bowel movements until the time comes when your bowel works perfectly on its own.
What’s the downside? I don’t know of any. Besides the cost of the herbs, there’s none that I’m aware of. Rumors suggest that constant use of cathartic herbs will become addicting, but I’ve never, ever seen this. Constant use of cathartic herbs with no lifestyle change, well, if you want to continue to poop, you better keep taking the herbs. But on the other hand, I’ve seen thousands of people worldwide, including myself, that used Intestinal Formula #1 for years and then, when their lifestyle was corrected and adjusted enough, the bowel started working naturally two to three times a day on its own. I’m one of those. I took the formula for over ten years before my lifestyle, my exercise program, my new emotional program and all of the good things I was doing kicked in enough for me to feel better and have those regular two to three bowel movements a day where my bowel moved thirty minutes after each major meal. So it can take some time, especially if you have years of hard living or bad living habits or, again, have inherited a very weak, sleepy bowel.
Once my patients would start having regular bowel movements without the formula, the only time they used Intestinal Formula #1 again was during episodes of constipation, usually Thanksgiving, Christmas and any time the family gets together and eats, or when they traveled... any time they threw off their system and it resulted in constipation. Then you can use Intestinal Formula #1 on a temporary basis, but believe me, my patients didn’t get addicted.
I always say it’s like going to the gym. If you do isolated biceps curls, that makes your biceps stronger, and when they’re stronger they work better. So, so much for this rumor of addiction.
What is the dosage for Intestinal Formula #1?
Taking the Intestinal Formula #1 is simple. Unless you want to learn the laws of jet propulsion, start with one capsule. It’s a strong formula. The best way to take it is during or just after dinner. When
110 Frequently Asked Questions
you have some food in your stomach, take just one capsule. The next morning when you wake up, you might notice a dramatic difference in your bowel movements. If not, if you don’t look at that toilet in amazement at what came out of you, then this evening with dinner take two capsules, and wait and see what happens the next day. You keep increasing by one capsule every day, and you’ll know when you achieve the right dosage. You’ll feel it. You’ll feel that colon, that large muscle in your lower abdomen, beginning to work and removing all the bowel material.
I’ve already worked up to a high number of the Intestinal Formula #1 and I’m afraid to take more. What do I do?
A lot of people with sluggish bowels work up to a high number of pills and are afraid to take any more. Don’t be afraid. What we need to fear is all the health problems and diseases and illnesses that are caused by constipation.
There’s no limit to the amount of Intestinal Formula #1 you can take. I received a letter from one man in Hawaii who had to take 45 capsules before his bowel opened up. And after 24 hours of sitting on the toilet this man lost 52 pounds. That’s right—52 pounds of fecal matter! Now, this was a heavy man, well over 400 pounds. His wife was the one who told me this story, and she said to me, “You know, Dr. Schulze, I always knew he was full of crap.” And she was right. As far as I know, 48 capsules is the record, and I doubt if it will take you that much. But don’t be afraid to take as many capsules as you need to get your bowel working.
I’m having two to three bowel movements a day, but not thirty minutes after each meal like you suggest. Is this OK?
Hey, remember, I’m going for perfection here. Like I said, when I examined primitive people who lived very natural lives, they would eat, and after every major meal, within about 30 minutes, their bowel would move. That’s what I’d like to see, and that’s the way
111 Frequently Asked Questions
most of my healthy patients’ bowels work most of the time. Not every time. Not everybody within 30 minutes evacuates their bowel. But that is a goal that you are going for. That is definitely a good goal, that at least one of your major meals that you eat during the day, whether in the morning, evening or midday, that thirty minutes afterward you have a bowel movement. That’s when you know your bowel is getting really healthy and strong.
If I’m having a bowel movement thirty minutes after a meal, isn’t that too fast for all this food to be moving in and out of me?
Well, not really, because the bowel movement that you’re having thirty minutes after a meal is not the material from the meal that you just ate. Say you have a bowel movement 30 minutes after having your dinner. At best, that’s your lunch. Probably, most likely, it’s your breakfast. Maybe even the dinner from the night before. But it’s not the food that you just ate coming out of you.
The reason is that when you start chewing food, you excrete saliva and you start out a peristalsis action, a muscular wave in your esophagus that works its way down to your stomach that also squeezes to help digest the food that you’re eating. But at the same time, a peristalsis is triggered in your small intestine. There’s a triggering reaction, and that starts helping you digest, assimilate and eliminate the meal that you ate before. And that usually starts a wave going of peristalsis or muscular movement, contraction and action in your colon which will start you to eliminate the previous meal or two meals after you eat your current meal. So what am I saying? When you have a meal and a bowel movement 30 minutes later, you are not excreting the food that you just ate. It’s from one or two, if not three, meals ago.
I’m experiencing a lot more gas when I use your Intestinal Formula #1. Is that OK, or am I allergic?
Well, no, you’re not allergic, and that’s perfectly OK. I always use the analogy, if you had an old car in your garage and you hadn’t started it in years and you went out and started cranking the
112 Frequently Asked Questions
engine you might get explosions out of the carburetor or backfires out of the rear end, and it would shake and sputter, but after about fifteen minutes it’s going to hum, it’s going to run well. Well, this is just like your bowel. When you have more gas it means that the Intestinal Formula #1 is breaking up old deposits of fecal matter, stuff that’s in there for years, the fudgsicle you ate when you were fourteen, all those candy bars you had on Halloween when you were five. Let me tell you, there’s a lot of old material in everybody’s bowel, and the Intestinal Formula #1 breaks up that old fecal matter, that old toxic poisonous material. And when it does that, you can often get a little more gas.
If you want to help relieve the gas, use my Digestive Tonic along with the Intestinal Formula #1, and that will give you more gasrelieving capability. Take a couple droppersful in about an ounce of water, knock it back, and that will help move the gas on.
Why can’t I continue having regular bowel movements when I stop taking the Intestinal Formula #1?
Well, there’s a couple reasons for this. One is your bowel is not healed and strong enough yet. Remember, taking Intestinal Formula #1 is like sending your colon to the gym and doing an isolated biceps curl. Every time you take that formula it works the muscles of your bowel, creating more peristalsis. So every time you take that formula, your bowel gets cleaner and stronger. But, it doesn’t happen overnight. Some people need to take the formula for months, others for up to a year.
Personally, I had to take that formula for 12 years before my bowel (because I inherited a very bad bowel) worked perfectly on its own. And now, I only take the formula maybe once or twice a year, maybe if I’m traveling (because that can cause constipation), or if I go to too many parties in a row, have some food that really isn’t on my day-to-day program and want to get it out of my body. But that’s the main reason.
Also, another reason is maybe your lifestyle, especially your food program, hasn’t changed enough yet, or you haven’t had those
113 Frequently Asked Questions
changes made for a long enough period. Because, remember; so many things also affect your peristalsis, like the type of food you’re eating. Is it live enough? Is it raw enough? Does it have enough fiber? Does it have enough enzymes? The more you get towards that good, organic fruit, vegetable, vegan food program, the better your bowel is going to work.
Also, lifestyle changes. If you’re happy, your bowel is going to work much better than if you’re unhappy. Maybe you sit in an office all day long, and that certainly isn’t going to promote the bowel to move as much as it would if you were working outside and up and moving.
So, again, the two reasons that when you stop the 5-Day BOWEL Detox that your bowel stops working is, one, your bowel isn’t strong enough yet, so continue the program, and two, your food program and your lifestyle changes need to be more dramatic or need to be better for a longer period of time. So don’t stop them, either. In fact, make your food program cleaner, get in more exercise and make your lifestyle changes, keep up with your Intestinal Formula #1, and you, like all my patients, will end up having a perfect bowel.
Can I start taking the Intestinal Formula #2 right away?
Do not start taking the Intestinal Formula #2 until you get your bowels working. I suggest, in all the literature, that you use the Intestinal Formula #1 for a week and then, as your bowels are regulated, you start with the #2. But do not start the Intestinal Formula #2 until your bowels are regulated. So for those of you who are constipated or who have had years of constipation or maybe have inherently weak bowels, don’t be in any hurry. Nobody should be in any hurry to start Intestinal Formula #2. Stay on Intestinal Formula #1 until you are having regular, frequent bowel movements that put a smile on your face every morning, and you’re starting to have bowel movements even at other times during the day after your meals. And when you’re feeling really good about your bowel and the way it’s working, then you start the Intestinal Formula #2.
114 Frequently Asked Questions
Why does Intestinal Formula #2 constipate me?
Some people take the Intestinal Formula #2 and find that it constipates them, and there’s a few reasons for this. First off, remember, the whole time you’re using the Intestinal Formula#2 you should also be using the Intestinal Formula #1. In fact, if you read the directions you should be using more of it than you normally need, because Intestinal Formula #2 is the great drawing, cleansing, detoxifying formula for the bowel. It’s going to go in there and pull out everything. But on its own, inherently, Intestinal Formula #2 is constipating for most people, especially if you suffer from some form of constipation. So if you just take Intestinal Formula #2 on its own, it may just solidify your bowels and stop them from working.
The first step is getting a good dosage of Intestinal Formula #1 down, to where your bowels are working and you’re very happy with the frequency and completeness of your bowel movements, and then increase it by a capsule or maybe even two, and then begin the week-long process of Intestinal Formula #2.
Do I have to consume the whole bottle OR BOX OF PACKETS of Intestinal Formula #2?
Yes. Intestinal Formula #2 is designed for one person to consume in one week, and it’s not until you finish the bottle that you finish the cleanse. If you are using Intestinal Formula #2 capsules, your goal is to take 10 capsules five times per day for the next five days. That is 50 capsules a day. If you are using Intestinal Formula #2 packets, then simply take 5 packets five times a day for the next five days. Remember, during this program on average you will be taking Intestinal Formula #2 (capsules or packets) every 2 to 3 hours throughout the day.
I’m taking your Intestinal Formula #2, but isn’t this black drink a bit radical?
Well, let me tell you something... It doesn’t taste black, and it doesn’t taste radical. Some people are so brainwashed by modern
115 Frequently Asked Questions
medicine that they begin to think that herbal medicine and Natural Healing is radical. They think that medical doctors and the practice of modern medicine is normal, is rational, but that herbs and Natural Healing is radical. People who think this are the living proof of the success of one of the greatest con jobs in American history. And this con job is to sell medicine to a society of people, but scare them out of ever taking their healing into their own hands. Let me tell you something, kidney dialysis, that’s radical. That should be in a vampire movie. Liver and heart transplants, that’s radical.
The fact that even medical universities like Stanford, say that the human body should live 125 years but we’re all dying in our early seventies... that’s radical. Let me tell you radical...
I had a patient who was in her early thirties and she had an aggressively growing brain tumor. The doctors did a surgery, and they opened up her skull and they scooped most of the tumor out, but they couldn’t get it all. They closed her back up, where she laid in intensive care for almost 30 days. She said she was in the worst pain of her entire life. She was totally paralyzed, couldn’t talk, couldn’t communicate, couldn’t even blink her eyes, and she said it felt like someone had hot nails driving through her head, and every moment of every day, every second, she was screaming silently to herself. That’s radical.
Let me tell you, I had a patient who had a tumor in her rectum, and the doctor said, “Hey, let us do some pinpoint, laser-guided smart bomb radiation treatment and we’ll get rid of that tumor.”
I tried to explain to her that radiation treatment is not that smart and not that well-guided and that she could end up with a horrible burn and that we should try Natural Healing. But no, she went ahead and had her radiation treatment on that tumor, and two days later when she was having a bowel movement, the bowel material came out her vagina, because they burned out the wall between her rectum and her vagina. Friends, that’s radical. Get with it here.
116 Frequently Asked Questions
There is nothing radical about going out into your backyard and finding a few plants that God has provided for our food and for our medicine. This is not radical. Natural Healing and water treatments and exercise and being happy and having a great spiritual life, this is not radical. Mutilating surgery, burning toxic radiation and killer chemicals called chemotherapy, this is radical. Intestinal Formula #2 has a little charcoal, a little fruit pectin and a few herbs. This formula may be black in color, but mix it with juice, it will taste just fine, it will clear years of poisons out of your bowel, and I assure you, it is nowhere near a radical treatment.
If I have Crohn’s disease or Colitis or Irritable Bowel Syndrome, how do I approach the cleanse?
For those of you with Crohn’s disease or colitis or irritable bowel syndrome, do not start with the Intestinal Formula #1. Intestinal Formula #1 is for about 98% of the people out there, the people with sluggish bowels, maybe a history of constipation, but who do not have a bowel movement twenty to thirty minutes after each major meal.
The other 2%, those who are having too many bowel movements, don’t need to increase their bowel movements, and that’s what the Intestinal Formula #1 does. So instead of using the Intestinal Formula #1, just go right to the Intestinal Formula #2. If you’re one of those two percent, you’ll love it. You’ll think it puts the fire out in your bowel. It’ll soothe the irritated tissue, reduce the inflammation in your colon, and solidify the diarrhea-like bowel movements. You’ll feel wonderful. Believe me, it will be a blessing in your life to start on the Intestinal Formula #2.
Is it constipation that causes a fecal encasement?
Yes. Basically, as Americans, we’re not big on fiber. We love meat, dairy, chicken, fish, eggs, cheese, and the first thing people have to realize is, animal equals zero fiber. Anything that came from an animal has no fiber, which means it sits in your bowel, and it really won’t go anywhere until you consume something that has fiber, which pushes it out. So the good old American food program of bacon and eggs is literally stuck down there.
117 Frequently Asked Questions
I had patients that during a bowel cleanse, after having already done three or four previous cleanses, would eliminate the entire casing of the inside of their bowel. I’m talking five feet long here, and they’d eliminate it in one bowel movement. And they’d be frightened, because they thought they were losing their colon, not just eliminating the old toxic liner. And you could even see the sacks on it; they would come out at the same time. But during normal bowel cleansing, those diverticuli don’t get emptied. It takes a little bit of advanced bowel cleansing to get rid of them.
Do I need to be taking acidophilus?
For those of you worried about taking acidophilus or lacto-bacillus bacteria after doing the bowel cleanse, I ask you this: Who said that my program took the flora out of your bowel? If you’re on a good food program with some nice raw fruits, vegetables, sprouts, soaked beans and all those good things, you shouldn’t have any problem with your intestinal flora. And if you think you do, think about fermented veggies and garlic.
Garlic is wonderful for your intestinal flora, also raw sauerkraut, Anne Wigmore’s Rejuvelac, fermented soy yogurts, seed cheeses and all those wonderful things that you can use to get bacteria back in your bowel.
And if you’re really worried or have a history of problems, then sure, you can take some bacteria, like various lacto-bacillus strains, but when you do, please stay away from the ones that are made with dairy products. Use the ones—I see them all the time—that are made with apple juice and other great foods instead of getting near all that cow juice that’s just going to constipate you and cause problems all over again. And now that you’ve cleaned out your bowel, you don’t want that. But if you need to, or if you feel you need to, sure, you can take some added bacteria to help your intestinal flora.
118
Frequently Asked Questions
Are there things you eat that actually stay in your colon for years and years?
Yes. It’s actually a medical fact more than a Natural Healing fact. The Merck Manual is the American standard, if not the international standard, of diagnoses of disease. It’s produced by Merck Research Laboratories, one of the largest drug companies in America, and it’s a standard medical text of disease used around the world. Every doctor has one. And their statistics say that in 1950, 10% of all Americans had diverticulosis, or herniated sacs, in their colon caused by the pressure and stuffing of constipation, where fecal matter literally pushes into a weak part, or a balloon, in the wall of the muscle of the bowel and stays there. But in 1955, they raised that to 15%. And in 1972, they went up to 30%, and in the 1987 edition, they said just about half of Americans have diverticulosis or herniated sacs in their colon. And in the most recent edition of the Merck Manual, it says if people live long enough, every American will have herniated bowel pockets or diverticuli (which are just like a weak spot on a balloon or a rubber tire where it bulges), and they get filled with fecal matter. And basic common sense will tell you it just stays in there. In fact, the whole colon can get encased in fecal matter in advanced constipation, to where it looks like a rusty pipe, an old steel or galvanized pipe in your house, and when you look through it you can only see a small hole.
How can an herb stimulate a sluggish bowel that’s been a chronic problem?
It’s great. I’m always amazed by how many people say, I don’t get it, how do herbs work? And I think, I don’t get it, how do they not? We don’t question food, do we?
All food, herbs, plants, trees, barks, berries, resins, strawberries, blueberries and anything that grows on this planet contains chemicals. Some of these chemicals are nutritional, like vitamins, minerals and enzymes. Other chemicals are stronger, like essential oils and alkaloids, and they’re very medicinal. All the original
119 Frequently Asked Questions
classic prescription drugs in America were isolated from chemicals found in plants.
Over 50% of the drugs used today were originally chemicals found in herbs. Herbs simply work off chemicals. There’s a group of chemicals called anthroquinones, and there’s a particular anthroquinone, called Emodin, which is in certain herbs like the aloes that grow equatorially around the world, or Senna Pods and Leaves, which were famous throughout recorded history as laxatives even in ancient Egypt.
And then there’s Cascara Sagrada, which is our California plant. These all contain the Anthroquinone Emodin, and Emodin, when it gets inside your bowel and touches your colon wall, actually makes the muscle move. It stimulates that muscle to move. It’s kind of like going to the gym. You’re strengthening that muscle by stimulating it to move. And it stimulates it to move so much that in one naturopathic school we took a bowel out of a dead person and when we smeared the different Emodin herbs in it, the bowel actually contracted. So hence comes my statement that I’ve been accused of making a few times, that I can even get a dead person to have a bowel movement. And it comes from the fact that I don’t need any participation from the patient.
These herbs are powerful enough to make the bowel contract and work. It starts that muscular peristalsis, specifically in the colon. So it’s going to make your bowel work tomorrow, and I don’t care what you’re eating, drinking or thinking. We’ll get right, but that might take a month or two. Right now, tomorrow, I need your bowel to work. So I made the Intestinal Formula #1 in the clinic to guarantee me that I could get my patients’ bowels to work regardless of whether or not they had corrected anything yet. I had to get the elimination channels, the channels of waste removal, working in the body and the herbs are what did it.
120 Frequently Asked
Questions
121 Frequently Asked Questions


INTRODUCTION TO LIVER CLEANSING
Who knows what some of our ancestors were thinking over a thousand years ago when they came up with the word to describe this organ. I believe they were thinking of the word LIVE, which comes from the word ALIVE, which means to continue life. Again, who knows, but they knew one thing for sure… when this organ gets injured, or gets sick, you cannot continue life
Feel More Alive With A Healthy Liver
Your liver is the LARGEST solid organ in your body. It does more varied and different jobs for you than any other organ. In fact, medical science doesn’t know everything it does, and in my opinion never will. What we do know is that it creates glucose, the body’s only chemical that gives us pure energy. It creates digestive fluids needed to digest foods. It creates enzymes that neutralize toxic poisons in your blood. It creates hormones, breaks down fat, kills bacteria and viruses, synthesizes protein and stores everything from immune cells to iron to Vitamins A, B-12, D, E, K and on and on and on.
Your Ultimate ENERGY Organ
It’s your liver’s job to convert carbohydrates you eat into glucose. Glucose is the primary ENERGY source of the human body. Your liver makes glucose and then stores it for you as a reserve energy supply. When you need energy anytime 24/7, your liver releases this stored glucose and WOW, you get an energy blast second to none,
123
.
better than coffee. Keeping your liver healthy and clean simply helps you have all the energy you need, whenever you need it.
Your Ultimate DETOXIFICATION Organ

Your liver is the ultimate detoxification organ in your body. Most of the food you consume is dusted with, dipped in, sprayed, mixed, colored, flavored and preserved with thousands of different toxic chemicals and then packaged in toxic containers. And God only knows what is in the water you drink and the air you breathe?
Everything you eat and drink is digested and travels from your intestines, via your portal vein, to your liver FIRST. Everything that goes into your mouth must first pass through the liver, and its numerous safety checks, before entering your bloodstream to feed every cell in your body. One of your liver’s most important jobs is to produce enzymes and numerous other chemicals that neutralize and render harmless all the harmful and toxic substances in your food, water and air.
If your liver is clean and healthy, then it also contains millions and millions of immune cells, called macrophages, which literally means “big eaters”. These macrophages are the back-up system to your liver’s detoxification ability killing and eating bacteria, virus, fungus, parasites and any harmful toxin, poison or chemical that they come in contact with.
Create an Energized, Healthy and Long Life
Whether you are living the American Dream, or the Japanese, Russian or Chinese, modern living in most of the civilized world is also a toxic, poisonous and actually lethal experience. What is in your food, water and air is trying to create disease and kill you
124
Introduction To Liver Cleansing
every second of every day. Thank God for your liver, because it’s saving your life, every day. Think about it, my friends, considering that there are about 100,000 new chemicals floating around in our environment, and our bodies, a little flushing, cleaning and protecting of your liver once a year doesn’t seem so extreme, does it?
The bottom line, keeping your liver healthy… keeps you healthy, so let’s take a look at some of the health benefits of my 5-Day LIVER Detox.
Why Do We Need To Clean And Flush Our Livers?
As mentioned, it’s the liver’s job to filter everything we eat and drink and remove anything harmful from our digested food before it enters our bloodstream. It removes cholesterol and harmful fats from eating too much animal food and removes the literally thousands of additives in the food and liquid that we consume.
Your liver removes all of this harmful material from your blood that if left behind, will cause heart attacks, strokes, circulatory disease, cancer, neurological diseases and a hundred other diseases. This is why many doctors will often say that when you have almost any disease, your liver was sick long before your disease developed.
An unhealthy lifestyle and diet causes the liver to be overworked and then congested with this same toxic waste it has removed from your blood. But now, in it’s constipated and sick state, your liver can’t get the poison out of itself. This accumulated waste eventually causes your liver to get diseased and even causes liver cancer.
Liver flushing and cleansing does just that. It causes the liver to empty its toxic contents, when it is constipated and overloaded with them. Think of it as an enema for the liver.
125 Introduction To Liver Cleansing
“Getting well is easy. All you have to do is… STOP doing what is making you sick and killing you. START doing what will heal you and Create Powerful Health.”
126
WHY CLEANSING YOUR LIVER IS VITAL
Disease doesn’t just happen overnight. Heart disease, cancer—most all diseases—develop months, even years after your liver failed to keep your blood clean.
That is its job. 24 hours a day, 7 days a week, 365 days a year, every second of every day, NONSTOP… your liver cleans and detoxifies your blood. Its job is to trap, filter, neutralize, render harmless, kill and eliminate ANYTHING you have inhaled, consumed or absorbed which may be damaging to your body.
Bacteria, fungus, virus, parasites, old pharmaceutical drug residues, alcoholic beverages, old worn out red blood cells, carcinogenic vapors from plastics, toxic household chemicals or just the pesticides, insecticides, preservatives and chemical additives in the food on your dinner plate, natural or man-made toxins, whatever, your liver has to deal with it and it does. There are literally millions of toxic trash bits circulating in your blood and they’re hurting every cell in your body.
If your liver didn’t continually remove this toxic trash, you would be dead in hours!
Over 72,000 synthetic chemicals have been developed since WWII and less than 2% of them have been tested for toxicity. Many are known to cause birth defects and cancer and to damage the liver, kidneys, and brain. Most have NEVER been tested for long-term effects.
127
CHAPTER 13
Why Cleansing Your Liver is Vital
Most people think that even though there are thousands of toxic chemicals found in our air, water, earth and food, that these poisons aren’t in our bodies. Most people are wrong. Analysis of human fat, blood, urine, breath, mother’s milk and even semen demonstrate that EVERYONE (especially Americans) carries hundreds of toxic lethal chemicals in their tissues. Dioxins (Agent Orange), PCBs, DDT, Organophosphates, Orangochlorines, the list goes on and on. Most of these toxic chemicals present in our bodies have been linked to the skyrocketing cancer rate and alarmingly high rate of reproductive disease and failure.
Most people also believe that low dose exposure to these chemicals can’t possibly harm us, that the government wouldn’t possibly allow it. Once again, most people are wrong. Everyone on earth now eats, drinks, and breathes a soup of toxic chemicals that cause health damage at low doses.
If you think you’ll get protection by locking yourself up in your house, think again. A recent EPA study concluded that air inside American homes is up to 70 TIMES more polluted than outdoor air and that toxic fumes from common household cleaners cause cancer.
If all this isn’t bad enough, toxic radiation from Chinese weapons tests and poisonous industrial chemicals from Japan and Russia arrive in America often within hours of their emissions. Not long ago, deadly bacteria from Africa caused disease outbreaks in Florida. The contamination was found to be caused from the pathogens living in the cracks of African sand particles that were picked up in African desert dust storms, drawn up into the upper atmosphere and then dropped out of the sky with rain in Florida to maim and kill Americans.
The bottom line is, I don’t care who you are, and I don’t care how healthy you think you might be. I don’t care if you live in Tahiti, eat only organic fruit, drink only distilled water, and exercise eight hours a day. If you are a human being who eats, drinks and breathes,
128
and if you live anywhere on this planet, your liver has been attacked, damaged and is possibly even sick.
Your only possible defense is a strong offense, in other words, a strong and healthy liver. And, the best way to maintain a strong and healthy liver is to cleanse it regularly.
Prevent Disease And Protect Your Liver NOW!
The main idea in Natural Healing (as opposed to conventional medicine) is to prevent disease and protect your body, before it gets sick. Your liver (more than any other organ in your body), prevents you from getting sick. Since your liver is the defensive barrier between the things you take into your body and the blood that feeds that body, it is often referred to as your first line of defense. Even conventional doctors will tell you that long before most diseases surface, often the liver was weak and unable to perform its job. That’s why it is so important to cleanse your liver on a regular basis.
The #1 and #2 Causes Of Death In America Are Directly Linked To The Liver.
Heart attacks and strokes, the #1 cause of death in America, are caused by cholesterol build-up blocking either the coronary or cerebral arteries, which ends up either killing the heart or killing the brain. It’s one of the liver’s main duties to filter this cholesterol out of your blood.
The #2 cause of death in America is cancer. Everyone now agrees that toxic, carcinogenic chemicals in our environment cause almost all cancers—chemicals that have found their way into the food we eat, the water we drink and the air we breathe. These poisons get into our bloodstream, kill our cells, create tumors, cause cancer, and ultimately kill us. Another one of the liver’s main duties is to eliminate these poisons from our blood. For either one of these two things to happen, the liver must first fail to do its job.
129 Why Cleansing Your Liver is Vital
#1:
HEART
ATTACKS AND STROKES ARE CAUSED BY HIGH CHOLESTEROL FACTS
� Over one million Americans will be killed by circulatory disease, heart attacks and stroke, this year alone.
� Every hour of every day, over 500,000 Americans swallow a pharmaceutical drug to try to lower their cholesterol.
Your liver has many functions and one of its main ones is balancing the amount of cholesterol in your blood. It is common scientific knowledge and simple Newtonian physics that too much fat in your blood causes your blood to be thicker, which in turn requires your heart to pump harder, which in turn causes hypertension (high blood pressure). When this cholesterol increases and accumulates even more, it can block off critical arteries to your heart and brain, causing heart attacks and stroke. It is your liver’s job to filter that cholesterol out, which it does.
But when in turn that cholesterol clogs up your liver, your liver becomes overloaded, and then the excess cholesterol spills off into the bloodstream and ends up clogging your arteries.
THIS IS THE DIRECT CAUSE OF 99% OF ALL HEART ATTACKS and the majority of strokes and other circulatory diseases.


130 Why Cleansing Your Liver is Vital
The only source of cholesterol that can get into our body is from our food. It doesn’t come from our air and it doesn’t come from our water—only from our food. And the only food source of cholesterol on the planet is animal food. Being that Americans eat more animal food than almost any other nation on the planet, we as a nation have the highest amount of cholesterol in our bloodstream.
#2: CANCER IS CAUSED BY ENVIRONMENTAL TOXINS AND POISONS FACTS
� Cancer is the #2 cause of death in America today, killing well over 1/2 million Americans every year!
� 80% of all cancers are a direct result of chemicals in our air, water and food, according to leading experts.
� More than 72,000 synthetic chemicals are in commercial use today, with approximately 1,000 new chemicals introduced each year.
� Of those 72,000 plus chemicals, less than 7% have been tested for adverse effects.
Modern life in America literally surrounds us with poisons and toxic chemicals. They come from our air, water and food, and are absorbed directly through our skin. They are found everywhere, from our household furniture, rugs and construction material off-gassing, to the plastic wrap and containers we store our food and liquids in, to the products we clean our house and body with. THEY’VE GOT US SURROUNDED!
The issue of environmental toxins is complex, and that’s because the poisons are coming at us from all directions. They come not only from our food, like cholesterol, but from our water and air, as well. Some of them are actually being assimilated directly through the pores of our skin right at this very moment.
131 Why Cleansing Your Liver is Vital
It doesn’t take a genius to figure out that we’re getting bombarded with more chemicals today than ever before in history. When your liver is weak, these chemical poisons and toxins start to slowly but surely poison every cell in your body, causing numerous diseases that could eventually KILL YOU!
Again, almost all scientists, medical researchers and top cancer specialists now agree…CANCER is caused by TOXIC and POISONOUS chemicals from our environment that get into our body and irritate, inflame, harm and eventually mutate our bodies’ cells.
In the next chapter, I expose facts that are almost too horrible to believe, but they speak for themselves. The reality is that in pursuit of the American Dream, we have poisoned our air, water and food. And almost all our modern conveniences are killing us in some way or another. Unless you are ready to drop out to the jungles of Ecuador, there is literally no escaping it. You can live depressed, paranoid or just plain freaked out, or better, you can learn to do something about it.
132
Why Cleansing Your Liver is Vital


Junk Food


Air Pollution
Poisons And Chemicals


Water Pollution
134 A Daily Dose of Poison: Modern Life in America
DISEASED
...AND
THE PROBLEM:
LIVER
THE CAUSES!
A DAILY
DOSE OF POISON:
MODERN LIFE IN AMERICA
24 hours a day, 365 days a year, you are bombarded. Your only possible defense is a strong offense. In other words, a CLEAN and STRONG LIVER.
There Is No Escape.
RURAL LIVING doesn’t stop you from being contaminated by global pollution.
POLITICAL BORDERS won’t stop you from being infected with diseases from other parts of the world.
What Can You Do?
Your only possible DEFENSE is a strong OFFENSE, in other words, a clean and strong liver.
I don’t care if you live in Tahiti, eat only organic fruit, drink only distilled water and meditate eight hours a day. If you live anywhere on this planet and want to be healthy, and stay that way, you need to flush out your liver and gallbladder... and do it regularly!
Medical doctors often say that before most diseases develop, the liver was malfunctioning and not doing its job. I have heard oncologists (cancer specialists) say that long before a person develops cancer, almost always, the liver was weak and not protecting the patient. This is why the liver is referred to as your first line of defense. Your liver is your defensive barrier between the things you take into your body and your blood. It literally
135
CHAPTER 14
A Daily Dose of Poison: Modern Life in America
blocks harmful substances from getting into your blood. To explain this let me refer briefly to the bowel anatomy section of this book...
“…The small intestine is where the majority of food absorption takes place; the more surface area to absorb, the better. Each villus (the singular of villi) contains a capillary network which introduces the digested food nutrients into your bloodstream. The portal vein transports this digested food first from your small intestine into your liver and then, if deemed acceptable, onward into your entire circulatory system to feed every cell in your body.”
So as you can see, everything you breathe and swallow—food, water, drugs, EVERYTHING—once it is assimilated by your small intestine, everything goes directly to your liver. Even what is in the air you breathe is taken into your bloodstream and then dealt with by your liver. If it is toxic, then your liver creates particular chemicals, like enzymes, that can actually neutralize the poison.
You Say You DON’T EAT Or DRINK POISON?
You can’t say that anymore. If you live anywhere on this planet, you are breathing, drinking and eating poisons. The FDA says that just the food in the average American grocery cart contains over 50 known poisons and toxic substances. Just read the newspaper or listen to the radio, and you’ll hear a current hot news story about a health concern that affects the liver. Most of the stories have to do with our liver cells being hurt, damaged, sometimes even destroyed, by toxic chemicals in our food, air, water and environment and especially by pharmaceutical drugs that have been found, after approval, to be liver killers.
Let me give you just a few examples of extremely common killer poisons that target the liver, that we take into our bodies and blood every day. (I have left out thousands that cause disease and kill other organs; I’ve just stuck to the liver.)
136
A Daily Dose of Poison: Modern Life in America
� 1,3-Butadiene, in everything from rugs and rug pads to gasoline, rubber tires, car exhaust and groundwater, is known to cause liver cancer.
� Benzenes in plastics, polypropylene food and water containers and tobacco cause liver tumors and cancer.
� Chlorinated water, whether you drink it or just breathe the vapor from your shower, destroys liver white blood cells.
� Carbon Tetrachloride, found in groundwater, destroys the liver’s enzymes that it creates to render poisons harmless.
� DEHP (Diethylhexyl-phythalate) that is in many plastics, food wraps and even used to make blood storage bags (and can leach into the stored blood) is a killer to the liver.
� Dioxins, which are common in pesticides, herbicides and now found worldwide in air, water, animal products and even in human livers, kill the liver, too.
� Ethanol, in all alcoholic beverages, causes cirrhosis of the liver and kills liver cells.
� Ethylene Oxide, an anti-bacterial that is gassed onto almost all herbs sold in America today. Even 95% of organically grown herbs after harvesting are gassed with this toxic chemical. Dr. Schulze’s American Botanical Pharmacy is one of the only companies in the world that doesn’t use chemically gassed herbs that cause liver damage, promote cancer and mutate unborn children.
� Glycol Ethers, in anti-freeze, glue, paint, sealants, chalking compounds, circuit boards and ink, kill liver cells.
137
A Daily Dose of Poison: Modern Life in America
� Nitrosamines, in baby nipples and pacifiers, soaps, cosmetics, food additives, food containers, pesticides, insecticides and herbicides, cause liver cancer.
� Styrene, a very common plastic used in food containers, water bottles, carpets and paper, destroys liver enzymes that protect you.
� Trichloroethylene, found in dry cleaning fluid, paint, glue, cleaners, degreasers, insecticides, drain cleaners and ink, kills liver cells.
My personal toxic horror pick is PCBs (Polychlorinated Biphenysis) from transformer leakage, and used in copy papers, paints, plastics, flame retardants, glues, adhesives, coolants, inks, common furniture fabric protectors and is now found in groundwater WORLDWIDE. This common, but powerfully toxic and poisonous chemical, kills liver cells and causes cancer and fetal death. This is a big one. You definitely have PCBs in your house in everything from your shower curtains to your bed mattresses to your children. You heard me right. This chemical is commonly found in the blood and tissue of newborn babies.

And finally, the Vinyl Chloride scandal. A few years back, it was all over every news channel that the chemical industry in America has been accused of not disclosing how toxic many common household chemicals and ingredients are. They were further accused of discussing this in closed-door corporate meetings, and subsequently covering up how poisonous and toxic some commonly used chemicals are. Way back in the 1950s and 1960s
138
A Daily Dose of Poison: Modern Life in America
workers at the chemical plants that produced Vinyl Chloride, a very common plastic used in everything from plastic food wraps to PVC (PolyVinyl Chloride) water pipes, were found to have the bones inside their fingers partially dissolved, along with skin damage, nerve damage and immune cell destruction, leading to cancers of the brain, lung, kidney and, you guessed it, the liver.
The Shocking Truth
You’ve heard it before, the AIR you breathe (we inhale 15,000 quarts of air every day), the WATER and LIQUID you drink and the FOOD you eat is loaded with toxic poisons. Your entire living environment is a chemical swimming pool.
FACTS
� Over 72,000 new synthetic chemicals have been developed since WWII and less than 2% of them have been tested for toxicity. Many are known to cause birth defects, cancer and damage the liver, kidneys and brain.
� Most have NEVER been tested for long-term effects.
� Many people think that even though there are thousands of toxic chemicals found in our air, water, earth and even in our food, that these poisons aren’t in our bodies.
� Analysis of human fat, blood, urine, breath, mother’s milk and even semen demonstrate that EVERYONE on this planet (not just those that live near big cities and pollution sources), but EVERYONE (especially Americans) carry hundreds of toxic lethal chemicals in their tissues—Dioxins (Agent Orange), PCB’s, DDT, Organophosphates, Organochlorines...the list is very long. Most of these toxic chemicals present in our bodies have been linked to the skyrocketing cancer rate and alarming high rate of reproductive disease and failure. OK, so these poisonous chemicals are in our bodies, but can this low dose exposure really hurt us? The government wouldn’t allow it—or would they?
139
A Daily Dose of Poison: Modern Life in America
� Joe Thornton, a biologist at Columbia University’s Center for Environmental Research, says that everyone on earth now eats, drinks and breathes a soup of toxic chemicals that cause health damage at low doses, and that these toxic chemicals have already begun to cause large scale damage to the public health, including increasing cancer rates and impaired child development.
� Thornton and his wife Margie are expecting their first child. Thornton said, “My wife (being an Average American) has accumulated hundreds of industrial compounds in her tissues, and these substances have already crossed the placenta and entered the baby’s bloodstream. My semen (being an Average American) contains scores of pollutants that may have damaged the DNA that I contributed to the baby.” Thornton continued, “My baby is awash in industrial chemicals.”
� Even the Food and Drug Administration has warned that there are over 50 different known poisons and toxic substances just in the Average American’s grocery cart. These chemicals combined cause hundreds of different diseases and eventually kill you.

140
As many as 50 million Americans have been poisoned by radioactivity in their tap water.
A Daily Dose of Poison: Modern Life in America
Maybe each separate low chemical dose isn’t enough to kill you, but every day you are exposed to a concentrated cocktail of literally thousands of lethal toxic chemicals—even in your food. Some people say that food and household products couldn’t contain dangerous chemicals, again, that the government wouldn’t allow it.
The Average American’s Home Is Really A Toxic Gas Chamber.
Tens of thousands of different chemicals have been used to create the modern American “way of life.” Cancer-causing vapors offgas from most common household carpets, because they are made from petrol-chemicals and cause liver and kidney damage. Don’t worry about your poisonous insecticides and oven cleaners that you keep under the sink or in your garage, what’s in your drapes, wood furniture, plastics, beds, and even your clothing is poisoning you faster. To make matters worse, American homes and workplaces are now so energy efficient (air tight) that toxic chemicals build up to lethal concentrations.
FACTS
� The average American home has more toxic chemicals than a chemistry lab did less than 100 years ago.
� Americans on average spend 90% of their life living indoors.
� A recent EPA study concluded that air inside American homes is up to 70 TIMES more polluted than outdoor air and that toxic fumes from common household cleaners cause cancer.
� The National Institute of Occupational Safety and Health has found over 2,500 toxic chemicals just in common cosmetics that cause cancer tumors, reproductive disease and mutate unborn children.
141
A Daily Dose of Poison: Modern Life in America
� According to a study by the American Chemical Society, taking a shower leads to a greater exposure to toxic chemicals than if you drink the water, because the chemicals evaporate out of the water and are inhaled. In fact, in the average 10 minute shower, the human body absorbs as much chlorine as if you drank 20 gallons of tap water.

All organophosphate insecticides and pesticides like DDT and hundreds of others that are still used, were derived from Adolph Hitler’s Nerve Gas that he developed and used to kill millions of Jews. We stole his formula after WWII and “adapted it” and now it is coming back to haunt us.
As I stated earlier, toxic radiation from Chinese weapons tests and poisonous industrial chemicals from Japan and Russia arrive in America often within hours of their emissions. In 2001, deadly bacteria from Africa caused disease outbreaks in Florida. The contamination was found to be caused from the pathogens living in the cracks of African sand particles that were picked up in African desert dust storms, drawn up into the upper atmosphere and then dropped out of the sky with rain in Florida, to maim and kill Americans.
142
Toxins such as carbon monoxide, lead, insecticides and pesticides fill the air you are breathing right now.
A Daily Dose of Poison: Modern Life in America
The American chemical industries, power companies, petrolchemicals, plastics, manufacturing, mining, farming, might be getting a bit cleaner every year, BUT, even if we stop making and using ALL chemicals right now… many experts report that just our past chemical mistakes will still linger and continue to haunt us, create disease, cause cancer and EVEN KILL OUR GRANDCHILDREN’S GRANDCHILDREN.
Poison Medicine

Hippocrates, the so-called father of modern medicine (he was actually an herbalist) said, “Physician, do no harm” when he stated his basic philosophy of treating patients. He would be spinning in his grave on this one. Recently, the FDA banned numerous common pharmaceutical drugs suspected of hurting and KILLING people, killing thousands of people for that matter. Most people reading this book probably had a relative use one or more of these drugs—maybe you even used them yourself. One of the drugs was Propulsid, the nighttime heartburn drug, that despite the 1993 warning that it caused heart rhythm disorders was kept on the market. It is suspected of killing hundreds of people. Also, despite that it was suspected to have killed eight children in preclinical trials, no one told this to pediatricians who widely prescribed it to infants for common digestive disorders. “We never knew that,” said Jeffrey A. Englebrick, a heavy equipment welder in Shawnee, Kansas, whose three-month old baby boy, Scott, died after taking Propulsid. “To me, they used my baby as a guinea pig to see if this drug would work.” By the time this drug was pulled off the market, it was suspected of killing many children, but the manufacturer had already made 2.5 billion dollars on its sales. Other drugs that were recently banned (that
143
A Daily Dose of Poison: Modern Life in America
you may still have in your medicine cabinet) and are suspected of maiming and killing are:
� Redux, a diet pill, suspected in hundreds of deaths.
� Raxar, an antibiotic that is suspected of killing by disrupting heart rhythm.
� Posicor, a blood pressure medication, again suspected in hundreds of deaths due to heart rhythm disruption.
� Lotronex, a drug for treating irritable bowel, suspected of killing many and requiring many users to have their colons removed.
Of course, many banned drugs are suspected of killing the patient by destroying their liver, such as Duract, a painkiller, suspected of causing liver failure and other deaths but…
The winner is… Rezulin.
This drug was taken off the market and is suspected of being one of the biggest drug scandals in years. This diabetes drug was approved in 1997 and is suspected of numerous liver failures and hundreds and hundreds of deaths. Scandal has rocked both the drug manufacturer and the FDA on this one. Apparently pressure, corruption and subsequent cover-up is suspected in the drug’s approval. And, it is alleged that people’s jobs were threatened at the FDA, if they didn’t cooperate. The drug made over 2 billion dollars in the few short years, before it was recently banned. The medical doctor in charge of this drug company told the FDA that liver damage from this drug was the same as in the placebo group, but in fact it was almost 400% greater. Currently, it is unknown how many people got liver damage or died from using this drug.
144
FACTS
� The National Cancer Association concluded a 15-year study proving that women who work at home are over 50% more likely to get cancer.
� Breast cancer rates have skyrocketed in the last 20 years; IT IS THE #1 KILLER OF WOMEN. Even common bleach has been linked to causing breast cancer, along with laundry detergents, household cleaners and pesticides.
� Bleach has also been linked to reproductive failure in men and behavioral problems in children. Even when we try to do some good and protect people (and even children) by putting flame retardants in all foam furniture and television and computer chassis, we don’t really protect them. Well, the most common one, EBDE, is now found in women’s breast tissue and breast milk and the potential nightmare is so big that most countries in the world have now banned its use, but American homes and offices are swimming in it.
� Actor Michael J. Fox has Parkinson’s Disease. It has now been discovered that numerous other people that worked on the same television and movie sets with him over two decades ago also have Parkinson’s Disease, far too many people to be a coincidence. Medical authorities now call this type of incidence a “cluster” outbreak. And even though this and many other diseases are not considered contagious, facts prove that they do “attack” in “clusters” and are now being linked to toxic chemical exposure. Many nervous system diseases are now being linked to insecticides and pesticides.
� Allergies, Fibromyalgia, Chronic Fatigue Syndrome, arthritis, diabetes, asthma, immune system suppression, Lupus, Multiple Sclerosis, heart and circulatory disease, Alzheimer’s, Parkinson’s, Lou Gehrig’s and almost all other degenerative nerve disorders, depression, schizophrenia, liver disease, kidney disease, infertility, impotency, reproductive disease and hormonal imbalance can all be induced by toxic chemical exposure.
145 A Daily Dose of Poison: Modern Life in America
Are Over-The-Counter Drugs Safe?
First, many of the common drugs now sold over the counter, without prescriptions, were prescription drugs only a few years ago. Over-the-counter drugs are very potent and are also suspected in killing their users. Just simple aspirin and aspirin substitutes like Acetaminophen, (the active ingredient in Tylenol, Excedrin and an ingredient in Percocet, Vicodin, Sinutab, Sudafed and many more drugs) have been exposed as harmful to your liver, even killing you if you overdose. Medical doctors and government officials said they were basically shocked at this information, but I really don’t know exactly why, since it has been published for years. Although the deaths are due to overdose, painkillers are the most common drugs that people take more than the recommended dosage of, ignoring the instructions and just literally sucking a bunch of pills right out of the bottle.
OK, so now I think it’s safe to say that if you are a human, living anywhere on this planet, breathing, eating and drinking, that your Liver has been attacked, damaged and is maybe even sick. So, what the heck do we do NOW?
146 A Daily Dose of Poison: Modern Life in America

YOUR LIVER AND GALLBLADDER
Knowing how to clean and protect them can SAVE YOUR LIFE

Digestive, Assimilation & Elimination Tract
Liver cleansing and detoxification is one of the most important things you can do for your health.
Esophagus
Portal Vein
Gallbladder
Liver (RIGHT LOBE)
Liver (LEFT LOBE)
CHAPTER 15
ANATOMY AND PHYSIOLOGY OF THE LIVER AND GALLBLADDER
Your Liver is your Life Force, the source for your ENERGY.
This chapter is for anyone who wants to know more about their liver and gallbladder, where they are, what they do and how and why they get sick.
You do not need to know this information in order to flush out your liver and gallbladder. If you are not one for anatomy and physiology, NO PROBLEM. Just skip to Chapter 17 and I’ll tell you how to do my 5-Day LIVER Detox.
The Liver
Although your medical doctor would like you to believe that they have figured your liver out and got it all down, the reality is that your liver is the most metabolically complex organ in the entire human body, more than even your brain. It has numerous different microscopic functional units and is as complex and infinite as outer space. One of the main reasons I know God was a Natural Healer (and NOT a medical doctor) is the liver itself. It is so incredibly complex that you know it’s best to just leave it alone and create a healing lifestyle for it, and DON’T TOUCH IT, HANDS OFF. Now, let me try to boil it down and make understanding the functions of the liver as simple as possible.
Your liver is the largest organ inside your body. It weighs around three pounds. It is on your right side under your lower ribs. The underneath of your liver is concave, because it covers your
149
Anatomy and Physiology of the Liver and Gallbladder
stomach, duodenum, hepatic flexure of the colon, right kidney and right adrenal. Blood passes through your liver, especially blood from your digestive organs, which contain end-products of digestion and nutrition, before this blood enters your general circulation to the rest of your body. If I were to divide the two main tasks of your liver, they would be ENERGY/NUTRITION and DETOXIFICATION.
Energy And Nutrition:

Your liver is your Life Force, the source for your ENERGY. Your liver synthesizes the sugar glucose from carbohydrates or starches that you eat. Glucose is the most important carbohydrate in your body’s metabolism. It could just be called PURE ENERGY, because it is used by your brain and every other cell of the body for just that: ENERGY. Excess glucose is stored in your liver as glycogen and is ready to be converted back to glucose, if any energy is needed. Your liver also stores other SUPER ENERGY NUTRIENTS like Vitamin B-12 and Iron to be used any time you need a turbo-charge.
Your liver also makes vitamins, clotting factors and amino acids. It makes cholesterol that you need to produce steroid hormones (sex hormones) and other important metabolic chemicals. It also makes the lipoproteins (like HDL’s) that transport fat around in your blood. (Too much cholesterol in your blood, causing coronary arterial blockages, is from eating too much animal food and rarely from a liver gone haywire.) The liver stores other vitamins too, like A, D, E and K.
150
Close-up of fatty liver
Detoxification:
Your Liver is the Blood Detoxification organ in your body.
The liver recycles and removes worn out blood cells. Each red blood cell has a life span of 120 days (4 months). Once it is old and its time is up, macrophages, big eating white blood cells in your liver, eat the red blood cell. Every RBC (red blood cell) contains hemoglobin. Hemoglobin is the iron-containing pigment in your blood that makes it red, which carries the oxygen from your lungs to all the cells of your body. Your liver recycles this iron, stores it for later use or turns it into bile, which it excretes as a digestive juice.
Bile stimulates digestion, emulsifies fats, stimulates peristalsis (the muscular waves of the intestines), and is a natural laxative and a natural digestive antiseptic.
Bile contains bilirubin, a yellow-orange pigment from the iron in the hemoglobin from the dead red blood cells that macrophages ate. Phew… if you didn’t catch that one, don’t worry. Remember, getting well is easy.
Now for you numbers freaks, each red blood cell has over 200 million hemoglobin molecules in it and you have over 35 trillion red blood cells, so that’s over 7,000,000,000,000,000 (how the heck do you say this number) hemoglobin molecules that your liver has to recycle, or over 58,000,000,000,000 (58 trillion) hemoglobin molecules every day.
OK, let’s get simple. The liver detoxifies, metabolizes, renders harmless and eliminates harmful toxic poisons, chemicals and substances from your blood. It produces many different enzymes that actually convert toxic poisons into harmless chemicals and then they are eliminated in the bile that your liver excretes.
A small list of the substances that your liver detoxifies and renders harmless are alcoholic drinks, street drugs, pharmaceutical drugs, insecticides, pesticides, food additives, environmental toxic
151 Anatomy and Physiology of the Liver and Gallbladder
Anatomy and Physiology of the Liver and Gallbladder
chemicals, parasites, bacteria and viruses. So, one of the liver’s main jobs is to eliminate toxins, chemicals, poisons and drugs from your body. Then, it only makes sense that the more intake you have of toxic substances, the harder it is on your liver, the more work it has to do. This makes a great case for organic food. It not only tastes better and is more nutritious, but it doesn’t overwork or deplete your liver.
The liver also has to metabolize and render harmless anything that causes increased ammonia in the body. The main culprit here is animal food. When animal food is digested it forms ammonia (an alkaline gas), which is absorbed by your intestines into your blood to be hopefully converted into urea by your liver to be removed by your kidneys. Americans, (being the highest LIVER
DISEASES OF THE LIVER AND GALLBLADDER
Normal Liver
Bacterial Hepatitis
Viral Hepatitis
Cirrhosis

Post Necrotic Cirrhosis
Gallstones in:
Cystic Duct
Gallbladder
Common Bile Duct
152
Anatomy and Physiology of the Liver and Gallbladder
consumers of animal food on the planet per person), have a constant overproduction of ammonia gas in the intestines, which in turn weakens the liver and promotes hepatic coma or paralysis of the liver. Substances that contain ammonia (besides animal flesh, organs, eggs and milk), are mainly drugs, such as sedatives, tranquilizers, anesthetics, analgesics (pain relievers) and diuretics.
AT HOME EXPERIMENT:
Take two aspirin and place them in a spoon, hold the spoon over a candle (or the stove), until the aspirin melt. WOW! Ammonia city.
For years in my clinic, I saw patient after patient with liver trauma and even acute failure that caused hepatic comas worse than alcohol, drugs and toxic poisons. It was caused by fad high protein diets. These diets have come and gone and the current ones are The Zone and Atkins. These diets (like any diet) can cause weight loss, but they can also skyrocket your ammonia levels and paralyze your liver. This is a double whammy, because your liver now cannot process all of this added cholesterol that you are eating more and more of. And, this alone could give you a heart attack or stroke. Granted, you will look fit and trim in the hospital bed or the casket, but better to have a healthy liver, than to be sick or dead.
Jaundice: When Your Liver Gets Sick.
As I have discussed, one of the liver’s primary jobs is the production of bile, which is its waste product and also a great digestive system aid, among many other things. When the liver gets sick, it gets constipated, and the bile, instead of getting released, backs up in the body. Remember the part before about the 58 trillion hemoglobin molecules that the liver has to process EVERY DAY from the dead red blood cells? Well, when the liver backs up with bile (which contains bilirubin, an orange-red iron pigment from the old hemoglobin that the liver eats) and at the same time the liver can’t continue to clean all the 58 trillion a day recently dead orange-red hemoglobin molecules out of your blood—well, in a very short time you have all this excess
153
DISEASES OF THE LIVER






Normal Liver
Recent Hepatic Infarction
Liver death due to either a blockage or loss of oxygen-rich blood flow to the liver.
Steatosis (Fatty Liver)
This condition often occurs when there is too much fat in the diet.
Metastatic Adenocarcinoma
Cancer that originated in another organ (such as the pancreas, thyroid or kidneys) and then quickly spreads to the liver.
Hepatocellular Carcinoma
Cancer originating in the liver. Usually due to a previous liver ailment such as Cirrhosis, Hepatitis or even Fatty Liver.
Hemosiderosis
Due to iron overload of the liver, most often from blood transfusions, pharmaceutical drugs or even iron poisoning.
154
and Physiology of the Liver and
Anatomy
Gallbladder
Anatomy and Physiology of the Liver and Gallbladder

circulating orange-red bilirubin and hemoglobin. And what color do you think you are going to turn? You guessed it, ORANGERED. When your sclera (the whites of your eyes), your skin and even your urine takes on a orange-red color, this is called Jaundice and is a good sign that your liver is very constipated. It is that simple. This is why one of the major cleansing and detoxifying aids that I used in my clinic was a liver/gallbladder flush, to unconstipate the liver and get the bile flowing again. There are 2 main types of Jaundice and they are referred to as Intra Hepatic (inside your liver) and Extra Hepatic (outside of your liver), referring to where it is thought the trouble is.
Intra Hepatic Jaundice
The most common causes of Hepatitis (which just means liver inflammation) and Intra Hepatic Jaundice are drugs, alcohol, liver damage, almost any virus, bacteria, fungus, fad heavy animal protein weight loss diets and viral hepatitis.
Viral Hepatitis
There are currently six known types of Viral Hepatitis. The most commonly known are Hepatitis A, Hepatitis B and what used to be referred to as Hepatitis non-A, non-B which is now called Hepatitis C, and Hepatitis D, E and G. Soon, we will discover so many more that we will run out of letters of the alphabet and have to start giving them names like tropical storms and hurricanes, like Hepatitis Harry. Currently there is a medical mass panic to vaccinate for Hepatitis C. This dangerous vaccination is even given to children born in hospitals in NYC within hours after birth and most school kids in California. But, the only real prevention is to STOP doing what hurts your liver (like drugs and toxins), and START living a healthy liver lifestyle. As I said earlier, the liver’s
155
Patient with Jaundice
Anatomy and Physiology of the Liver and Gallbladder
job is to neutralize poisons and toxins and the more a person or child is bombarded with poisons, the weaker the liver becomes. What poisons, you ask? Well, when was the last time you were around a typical American kid and watched him eat, or any adult for that matter? Weak livers have less resistance to infections. We will never get rid of germs and viruses. As I always say, the only defense is a strong offense, which means building a strong healthy body. The massive amount of hepatitis infections all around America is just a reflection that we have beaten up our livers for too long.
Extra Hepatic Jaundice

Gallbladder filled with gallstones.
The most common cause of Extra Hepatic Jaundice is some type of blockage. Sounds like my theory of all diseases being caused by blockage, doesn’t it? And the major blockage is gallstones stuck in the gallbladder and bile ducts. Over a half million people this year in America will have their gallbladders carved out of them by medical doctors. Medical doctors are so absolutely stupid. FLUSH IT OUT, don’t CUT IT OUT.
Minor Jaundice or liver constipation can go on for years almost unnoticed, causing all sorts of health-related problems. Neurological diseases, neuromuscular diseases, paralysis, chronic fatigue, immune system depression and disorders, cancers, heart disease, stroke, hypertension, high cholesterol, every digestive disorder from indigestion to constipation, diabetes, dementia, depression, painful and stiff joints, sexual dysfunction, eyesight problems... the list is almost endlesssssssssss.
Many old sage doctors used to say when you have someone that has cancer, you have a patient who had a sick liver three to five years ago. I will go a step further, with any sick patient and with
156
Anatomy and
any disease we need to look at the liver and get it clean. This is why in my clinic, EVERYONE, EVERY SINGLE PATIENT, had to do my 5-Day LIVER Detox along with my Liver/ Gallbladder Flush. The bottom line:
“Let the liver get run down and congested and you will become toxic and weak. Keep the liver healthy and you will be protected from chemical poisons, disease, feel great and have TONS of energy.”
Hepatitis-C And Other Viral Ailments

Normal, healthy blood under a microscope.

Normal, healthy blood under a microscope. Blood containing Hepatitis C virus under a microscope.
Here are some names you may have heard of who are among the 4.5 MILLION Americans living with Hepatitis C: Pamela Anderson, David Crosby, Naomi Judd, Larry Hagman, Jack Kevorkian, Natalie Cole, Natasha Lyonne, Dusty Hill (ZZ TOP), Steven Tyler…the list goes on and on. You could assume, since most of these people are musicians and actors, they simply contracted the disease through hard partying, but you’d be wrong. The fact is most of them contracted Hepatitis C from blood transfusions.
Hepatitis C often leads to chronic liver infections, cirrhosis of the liver (scarring, deformity and non-functioning liver cells), hepatocellular necrosis (liver cell death) and eventually hepatocellular carcinoma (liver cancer) and liver failure and transplantation. It is the beginning of the end for many. Author Ken Kesey, poet Allen Ginsberg, blues legend Willie Dixon and baseball’s Mickey Mantle all died from liver disease soon after contracting Hepatitis C.
157
Physiology of the Liver and Gallbladder
If you, or anyone you know, has Hepatitis C, you were probably informed by your doctor that cancer, cirrhosis and ultimately a liver transplant would be your future. If you are the Average American, your doctor would be right. However, if you decide not to be the Average American, and make positive, healthy changes in your lifestyle, well, you can expect a long, healthy life regardless of any virus that may be lurking in your body, including Hepatitis C.
So instead of waiting for the virus to kill your liver, I’ve got a better idea…
First, I am a Natural Doctor who knows your body can heal itself of anything, any disease. But medical doctors say that most diseases are incurable and that there is nothing you can do. I suggest my approach.
In the past, it was believed that once you were infected with Hepatitis C, that there was nothing you could do and your body had no defense. However, current medical research has focused on virus specific immune T-cells in your body that go to your liver and destroy the HCV (Hepatitis C Virus).
New research released just last year showed two types of specific T-cells (T-4 and T-8) can kill the virus. From this research I quote: “Several groups have reported an excellent correlation between a robust and persistent T-cell response and viral clearance during Acute-C viral infections. Evidence also suggests that this immune response is maintained for several years following recovery from the infection. Therefore, Persistent-C virus infection is now associated with a poor T-cell response.”
OK, so now the question is how do you get, build and create, a “robust” and “persistent” T-cell response?
Let me make another point here. According to most oncologists, everybody has cancer, meaning that everybody has cells in their body that become malignant cells, every day. Most of us also
158
Physiology of the Liver and Gallbladder
Anatomy and
have strong enough immune cells and immune chemicals that destroy these cancer cells every day, too. That is why most of us do not have cancer.
I used to always say to my cancer patients that I am not so worried that you have cancer, but what I am very concerned about is why isn’t your immune system killing and eating up the cancer cells in your body? Why is your immune system NOT taking care of business? Why is your immune system NOT working? With cancer, AIDS, Hepatitis or any virus, or any disease for that matter, the real question is why isn’t your body doing its job and protecting you? In Immunology 101 on the first day of class, you learn that your immune system’s main job is to kill the bad guys, the harmful bacteria, virus, fungus, disease, whatever, and keep you healthy and alive. This is the primary job of your immune system!
Over the next few decades, many Americans will find themselves hosts to a wide variety of virus from herpes, to hepatitis to HIV— there is no escaping it. But, being a host to a virus and actually getting sick from the virus are two very different things. What makes the difference between carrying the disease and actually getting the disease is the health of your immune system. I always say the only defense is a powerful offense, which is building and maintaining a powerful immune system.
OK, so again, the question is how do you get, build and create, a “robust” and “persistent” T-cell response?
159
and Physiology of the Liver and Gallbladder
Anatomy
Dr. Schulze’s Healing Program For Hepatitis
Get more nutrition into your body! You can’t build powerful immune cells and a powerful immune system on junk food, pizza and beer. My suggestion is to flood your blood with massive amounts of vitamins, minerals and other nutritional building blocks that your body needs to build T-cells and a “robust” immune system. And, the best way I know how to do this is by taking SuperFood Plus two times daily. SuperFood Plus is organic and clean, so it doesn’t hurt your liver and pollute your body, like many nutritional products. It is also so easy to assimilate into your blood, so it won’t tap your energy—it will give you energy.


Powerful, high-quality and concentrated Echinacea extracts have been proven to measurably increase the number of T-cells in your body. (Here is the “ROBUST” the doctors were talking about.) Echinacea has also been proven to stimulate these T-cells into a higher level of activity (here is the “PERSISTENT” the doctors were talking about) and cause a significant decrease in reoccurring viral infections. Echinacea is a specific for Hepatitis C. I suggest taking one bottle of Echinacea Plus, the first week of every month, for the rest of your life!
2 3 1
The phytochemicals in my L-GB Formula are proven to bind to, coat and protect your liver cells from damage from attacking micro-organisms, including viruses. I would do my 5-Day LIVER Detox immediately and in addition, make my L-GB Formula something that you never leave home without. Take it at least every other week, 2 droppersful three times a day.

160 Anatomy and Physiology of the Liver and Gallbladder
My friends, I have always said you can heal yourself of anything, just STOP doing what is making you sick and START doing what will create powerful health. Amen!
Cholesterol Artery

The Gallbladder
The gallbladder is a pear-shaped sac on the underside of the right lobe of the liver that stores bile from the liver. While in the gallbladder, the bile is concentrated by removing water. The bile is released through the cystic duct, which joins the hepatic duct from the liver to create the common bile duct, which empties into the duodenum (the beginning of the small intestine).
Bile is not only the waste product of the liver that carries away the neutralized poisons, but, as stated previously, also stimulates digestion, aids digestion by emulsifying fats, stimulates peristalsis (the muscular waves of the intestines), is a natural laxative and a natural digestive antiseptic.
When the bile contains too much cholesterol from eating too much animal food (or for some people ANY animal food), the cholesterol can’t be kept in solution anymore and forms very hard stones and rocks. These can form in the gallbladder and also the bile ducts, causing Extra Hepatic Jaundice.
DISEASES OF THE GALLBLADDER
LIVER

Gallstones in:
Cystic Duct
Gallbladder
Common Bile Duct
161
the
Anatomy
and Physiology of
Liver and Gallbladder
Major cholesterol blockage on arterial wall


KEEPING YOUR LIVER CLEAN AND HEALTHY
How can you continue to live in America and keep your liver clean and healthy?
Teaching in many universities for over 20 years, I had the wonderful opportunity to dissect and examine numerous cadavers to show students what the liver and gallbladder actually looks like, which, believe me, is usually very different from the picture perfect anatomy books.
Often in bodies of people over 60, the internal organs are in such a mess that it is very difficult for students to identify things. They smell so bad that students would run from the room and vomit. One time, I had a student actually vomit in the cadaver, which in turn caused almost every student in the class to involuntarily start vomiting all over the laboratory. After that incident, I almost always tried to get the bodies of younger people killed prematurely due to an accident (rather than disease), so the internal organs would be more normal and less diseased.
What was surprising to me at first was how many young, supposedly healthy individuals would have fairly normal looking internal organs, but when you got to the liver and gallbladder, well, it was like an alien encounter.
Often the liver was shaped drastically different, swollen much larger than normal, filled with bloody fluids, pus, tumors, scar tissue and
163
CHAPTER 16
Keeping Your Liver Clean And Healthy
parasites. Sometimes there was so much swelling that the liver had doubled in size and extended way beyond its normal area, even into the area normally occupied by the spleen and colon.
The gallbladder was often really frightening to students, again being stretched way out of shape, often doubled in size, hemorrhaging internally and filled with coagulated liquid fats, pus, blood, gallstones, worms, cancer and just ungodly goop that was literally unidentifiable. Every student was shocked to see such advanced disease and degeneration in such young, supposedly healthy people.
What I Learned In My Clinic… You Are A Very Busy Person!
My clinic was in Hollywood and Malibu, California, and my patients were all from the entertainment industry. If you watch any movie that was filmed in the last 30 years, chances are your favorite scenes were filmed by a cameraman (who was on the program in this book), the audio people, the lighting staff or if not someone behind the scenes, then maybe the actor, actress or even the director was on my program. In spite of the glitz and glamour that surrounds the movie industry, directors, producers, actors and actresses, movie industry people usually work long 16-hour days under impossible deadlines and tremendous stress. And when they’re not working, they are rushing from one appointment to the next. So as my patients, they didn’t need me to give them more work than was necessary to get the job done.
So, I needed to develop healing programs that were EFFECTIVE, but also EASY enough for my patients to do at work. Most people can’t take a week off every season just to cleanse and still pay their bills, so I needed to design a week-long cleansing and detoxification program that a person could do without quitting their job and becoming a hermit.
164
The bottom line is not only that this program is effective, but, more importantly, that all of my patients were successful in easily completing my 5-Day LIVER Detox.
Why Do A Seasonal Cleansing?
Your body is really no different than your car. Like any machine, if you want it to last and give you the maximum lifespan that it was designed for, and give you years and years of trouble-free service, then it needs routine maintenance.
If you want to get the most miles out of your vehicle, then you have to follow a routine preventative maintenance program, just like the one that comes inside the glove compartment of every new car. You know, change the oil and oil filter every 5,000 miles, rotate the tires, change the air filter every 10,000, a tune-up in 20,000 or 25,000 miles, radiator flush, check the battery and so on. Any mechanic will tell you that if you want your car to last for years and years, you need to take care of it.
What If You Could Add 10 Years To Your Life…
By Just Doing A Simple Cleanse A Few Days A Year?
In fact, you will also notice that the manufacturer’s new car warranty is void if you do not follow the manufacturer’s suggested maintenance program. In fact, the warrantee will also be voided if you don’t use approved parts, lubricants, oils, filters and so on. In other words, the automobile’s manufacturer will not guarantee your vehicle if you don’t take care of it.
Well, in my lifetime, I have never heard of God personally coming down and telling anyone that if they don’t follow the manufacturer’s program that the guarantee will be void. But nevertheless, “God’s Laws of Nature” dictate that if you do not follow a routine maintenance program using the proper fuels and fluids, if you do not follow a routine preventative maintenance program, as sure as the wind, your vehicle will prematurely break down and you will die.
165 Keeping Your Liver Clean And Healthy
Keeping Your Liver Clean And Healthy
Your body, like any machine, uses fuel to run and as it runs it creates waste products. To have your machine run its best, it is important to use the absolute best fuels and to periodically cleanse your internal parts. This is very important even when you live in the best of environments, but we live far from the best environment. This is the problem…
Regardless of the fact that the Average American dies in 70 or 75 years, most medical universities today like Stanford and others agree that the human body, if properly nourished and maintained, should last about 125 years. They say that the only reason it doesn’t, the reason it is shortened by 50 YEARS is because of our lifestyle. The air we breathe, the fluids we drink, the food we eat and the life we live, KILLS YOU 50 YEARS EARLY!!!
Yeah, OK, I have been called “the toughest Natural Healing Doctor On The Block” and also the “Dirty Harry of Natural Healers.” And I know that some of my Natural Healing Routines, my Incurables Program and some of my Clinical Herbal Formulations and Dosages can make even the most diehard health fanatics get weak in the knees and cry for mommy.
And I Know That You’ve Heard, “This Guy’s Tough” And That My Programs Are Even Tougher.
I know some of my programs are tough, because I’ve done them all to heal myself. But when death is knocking at your door, and time has run out, it’s time to put the pedal to the metal and pull out all of the stops. People need to understand… that while Natural Healers and Herbalists pussyfoot around with minimal dosages and scented candles, and play politically correct games with government agencies to get recognized… medical doctors are sharpening their scalpels and getting ready to cut your ass off, fry you with radiation and fill your body with the most concentrated poisons in their arsenal.
In my clinic, I learned that to literally save my patients from killer diseases I had to match the medical doctors level in intensity, but
166
with Natural Healing Programs and Herbal Formulations and Dosages. So, I literally tried to kill my patients with water, juices, flushing and fasting, raw food, hydrotherapy, movement, herbal medicines and new, positive emotional habits. I made them blow up and destroy their lives, the way they lived that caused their disease in the first place. This is how I helped literally thousands save their lives and HEAL THEMSELVES, after the medical doctors gave up and sent them home to rot and die.
But…The Program In This Book Is Not Tough!
In Fact, It’s Very Simple, Easy And Fast!
Besides my life-saving programs, I also spent decades in my clinic developing and refining the most effective programs for SEASONAL CLEANSING AND DETOXIFICATION for my patients who were not dying, for my patients who had minor health problems or who were healthy and just wanted to stay that way.
Many of my patients, before they came to my clinic, had done these Overnight Miracle Flushes, 24-Hour Detox Programs or 2-Day Quick Cleanses you see in health food stores or hear about… and discovered for themselves that they didn’t work or weren’t thorough. What I know is that the average person needs about five days to get the old toxic accumulations out of their liver.
I also quickly learned that when my patients failed to stay on my cleansing program (they would say that they fell off, but it looked more like leaping off to me) their failure always took place on a weekend, not a weekday. Friends called for a last minute party, you forgot someone was having a get together, whatever, but trying to follow a detox routine on a weekend is a set up for failure.
Therefore, I discovered that a 5-Day Detox Program done Monday through Friday was not only long enough to be completely effective but also, by being during the work week, it gave my patients the best chance at succeeding and completing the program.
167 Keeping Your Liver Clean And Healthy
MY 5-DAY LIVER DETOX IS:
� Effective enough to FLUSH out your liver and REMOVE old toxic, poisonous waste.
� Powerful enough to FLUSH GALLSTONES, sludge and sediment from your gallbladder.
� PROTECTS and COATS your liver cells from future damage.
� And so EASY to do that you really won’t notice the effort it takes, the five days will fly by.
� And in five days, you’ll FEEL BETTER and have MORE ENERGY than you’ve had in years.
168 Keeping Your Liver Clean And Healthy

“Your disease is not a curse, it is a GIFT, a BLESSING. It is what brought you to this new beginning of the greatest adventure in your life, to discover and create a new life, a much better life, and to create a NEW YOU!”
— Dr. Richard Schulze
DR. SCHULZE’S 5-DAY LIVER DETOX

� Triple your energy and helps create Powerful Health
� PROTECTS and coats your liver cells and helps eliminate harmful, dangerous contaminants
� Flushes, dissolves and removes hardened sediment from the gallbladder
� Cleans your blood of unhealthy accumulated deposits
170
...ALL
IT TAKES IS 5 DAYS!
THE SOLUTION: DR. SCHULZE’S 5-DAY LIVER DETOX
I created my 5-Day Detox Program as an entry-level cleanse for all my patients. This program is an EASY cleanse that anyone can do.
After my patients started taking their SuperFood Plus on a regular basis and then did my 5-Day BOWEL Detox, and their bowel was working normally, it was then time to do their first detoxification program. If you are ill, you can start my 5-Day LIVER Detox IMMEDIATELY! You don’t have to do my 5-Day BOWEL Detox first, just add the Intestinal Formula #1 to the following program.
I give you my guarantee that you will feel physically better, more alive and more energetic after five days on this program. Also, you will feel better about yourself and your life too!
Come on friends, don’t take this program (or life for that matter) too seriously. Just do it—jump right in! Next Monday sounds like a good time to start to me, and if it’s already Tuesday, how about a 4-day cleanse? LOOK, any of you out there who think that this might be a little inconvenient or cramp your busy lifestyle, well, all I can tell you is that once people end up in the hospital, under the knife, they wish they would have done it 20 times. But more importantly, everyone should experience a few days of a juice flush and a few days on raw foods. For my patients, this program turned their health and their life around.
171
CHAPTER 17
The Solution: Dr. Schulze’s 5-Day LIVER Detox
The Liver/Gallbladder Flush Drink and Herbal Formulae stimulate the liver to produce more bile and get the bile moving through the gallbladder and ducts. This action unblocks and unconstipates the liver and gallbladder and even dissolves and removes hardened sediments from the gallbladder. This is what will clean and detoxify your liver and gallbladder and what you need to START.
My program is two days of a Purifying Raw Food Program and three days of a Juice Fast.
YES, I designed my 5-Day Detox Program to be done during the week, at work or during your regular weekly routine. Look, nobody wants to do a cleanse or detox on the weekend. And usually, if you are silly enough to plan it that way, the phone rings, friends or relatives call, and the next thing you know, you’ve blown it. Weekend fun, friends, parties and eating are all a big part of this.
172
The Solution: Dr. Schulze’s 5-Day LIVER Detox
5-DAY DETOX DAILY ROUTINE:
DO THESE 8 STEPS EVERY DAY!
STEP 1: Upon arising drink 8 oz. of distilled or purified water.
STEP 2: Prepare and drink the Liver/Gallbladder Flush Drink (see How to Make Dr. Schulze’s Liver/Gallbladder Flush Drink on page 174).
STEP 3: 15–20 minutes after drinking your Liver/Gallbladder Flush Drink, drink two cups of Detox Tea (see Dr. Schulze’s Detox Tea directions on page 178). Put 2 droppersful of my L-GB Formula in each cup of tea (consume total of 4 droppersful) or have the tonic separately in one ounce of water.
STEP 4: Finally, take 3 droppersful of my Detox Formula. This formula is my strongest tasting, so you can put it in a little grape juice, if you wish.
STEP 5: One hour later, drink your SuperFood Plus Morning Nutritional Drink.
SuperFood Plus Directions:
In a blender, mix 8 ounces of organic fresh fruit juice, 8 ounces of pure water, 1/2 cup of fresh organic fruit and 2 tablespoons of SuperFood Plus.
STEP 6: Repeat the same dosage of the Detox Tea & L-GB Formula two more times during the day, consuming a total of 6 cups of Detox Tea and 12 droppersful of the L-GB Formula a day.
STEP 7: Repeat the same dosage of my Detox Formula four more times during the day, consuming a total of 3 droppersful five times a day.
STEP 8: Continue with the Food and Juice Program as outlined on pages 180 and 181.
173
How To Make Dr. Schulze’s 2-Minute Liver/Gallbladder Flush Drink



TOOLS
�Blender (any)
�1 measuring cup (at least 16 oz.)
�1 water glass (at least 20 oz.)
�1 manual citrus juicer
�1 knife (wider is better)
�1 tablespoon
(FOR 1 FLUSH DRINK)
�3-4 juice oranges, 1 lemon and 1 lime (enough for 8 oz.)
�1-5 cloves of Organic Garlic
�1 inch of fresh,Organic Ginger
�1-5 tablespoons of Olive Oil (extra-virgin, cold-pressed organic)
�8 oz. distilled or filtered Water
STEP 1: PUT 8 OZ. OF FRESH JUICE IN YOUR BLENDER
NOTE: During Spring or Summer, mix the juice of 1 lemon, 1 lime and enough oranges to make 8 oz. of a citrus combination juice. During Fall or Winter, mix 8 ounces of fresh apple or grape juice or an apple/grape combination juice.
STEP 2: ADD 1 TO 5 CLOVES OF GARLIC
(1 clove for DAY ONE, 2 for DAY TWO... until you reach 5 cloves by DAY FIVE)
NOTE: Do not chop the Garlic, just throw it in whole, the blender will do the rest. The best way to peel garlic is to smash it under the flat side of a knife, the peel will just slip off. Use medium sized cloves. (Use larger or smaller cloves, depending on your garlic tolerance.)
174
LIVER Detox
The Solution: Dr. Schulze’s 5-Day
The Solution: Dr. Schulze’s 5-Day LIVER Detox





STEP 3: ADD 1 PIECE OF FRESH,ORGANIC GINGER ROOT (ABOUT 1 INCH LONG)
NOTE: Do not peel it. The blender will liquefy it.
STEP 4: FINALLY ADD:
�8 oz. of distilled or filtered Water
�1 to 5 tablespoons of Olive Oil (1 tablespoon for DAY ONE, 2 for DAY TWO...until you reach 5 tablespoons by DAY FIVE.)
STEP 5: BLEND ALL OF THESE INGREDIENTS IN THE BLENDER FOR ABOUT 60 SECONDS AND DRINK!
STEP 6: DON’T FORGET!
15-20 MINUTES AFTER YOUR FLUSH DRINK, PREPARE AND DRINK 2 CUPS OF DETOX TEA (SEE PAGE 180 FOR HOW TO MAKE THIS TEA)
NOTE: Put 2 droppersful of my L-GB Formula in each cup of tea (total of 4 droppersful) or have the tonic separately in an ounce of water or an apple/grape combination juice.
175
The Solution: Dr. Schulze’s 5-Day LIVER Detox
SHOPPING LIST FOR DR. SCHULZE’S LIVER/GALLBLADDER FLUSH DRINK
Take this shopping list to the store, get these ingredients and you will be set up to do my entire 5-Day LIVER Detox Kit!
15-20 Organic Juice Oranges
It is important to use organic when you are flushing, because you don’t want to put toxic, poisonous insecticides and pesticides into a drink that you are supposed to be cleaning your liver with.
5 Organic Lemons and 5 Organic Limes
2 bulbs of Organic Garlic
One bulb should do it, but why not have some extra garlic around?
5 inches of fresh, Organic Ginger Root
3 gallons of distilled or purified Water
This will make enough for your Liver/Gallbladder Flush Drink, as well as the 2 1/2 gallons you’ll need for your
24 oz. bottle of organic, extra-virgin cold-pressed Olive Oil

176
Real People. Real Results.
“18 months ago my cholesterol was 1469, almost 1500, my triglycerides reached 8664, almost 9000! It was really scary. My head felt like the top of it could just explode, and my brain even felt like it was shaking, along with the rest of my body. I had to resort to nerve medication, and I tried the drugs to lower cholesterol, but found it was damaging my liver. I was hospitalized 3 times with pancreatitis, and I had another 4 attacks after, but just stayed home and survived. The hospital stays were complete nightmares. No one I have ever talked to, no doctor or lab worker, had ever heard of someone with cholesterol and triglyceride levels so HIGH and still be ALIVE.
I did the LIVER FLUSH five times in a row, as well as the whole Incurables Program. I passed two tumors with ‘tentacles’ and hundreds of small green stones. After a year on the programs, my cholesterol is now 158 and my triglycerides are down to 444! I thank God for the information arriving when it did! May God bless you and guide you in your adventure! If I could do it, I know you can do it too!! My prayers are with you. Love in Christ.”
— J.K. in Mound City, MO
“I was doubled over in pain, and the doctors wanted to get rid of my gallbladder. Instead, I did your Liver & Gallbladder Program. The pain was gone immediately and in 5 days, I went back to the doctor and he said my gallstones were gone.”
— L.Q. in Boca Raton, FL
177
5-Day LIVER Detox
The Solution: Dr. Schulze’s
How To Make Dr. Schulze’s Detox Tea
Put six rounded tablespoons of Detox Tea into 60 ounces of distilled water. Be sure to use only stainless steel or glass cookware. Let the tea sit in the water overnight. In the morning, heat up to a boil, reduce heat and let simmer for 15 minutes. Strain the herbs, do not discard them, let the tea cool a bit, but use it hot. This will give you enough tea for your six cups for the day. Put the used herbs back into the pot, add three tablespoons of fresh herbs and 60 ounces of distilled water. Let sit overnight and repeat whole process. Keep adding new herbs to old ones for three days, then discard all herbs and start over.
Detox Tea is cleansing and detoxifying to the entire digestive tract. Brew some today!
SUGGESTED DOSAGE: Two cups, three times daily.
178
LIVER Detox
The Solution: Dr. Schulze’s 5-Day
The Solution: Dr. Schulze’s 5-Day LIVER Detox
EMERGENCY GALLBLADDER ATTACK TREATMENT
1 STOP EATING ALL FOOD immediately, which is a good idea with any acute illness. Take 4 droppersful of my Digestive Tonic and 4 droppersful of my L-GB Formula in an ounce of warm water, immediately.
2 PREPARE AND DRINK A LIVER/GALLBLADDER FLUSH DRINK. In an emergency, fresh apple-lemon juice is preferred, but any juice will work. Use at least 5 cloves of Garlic and 5 tablespoons of Olive Oil.
3 LIE ON YOUR RIGHT SIDE WITH A HOT PACK OVER YOUR LIVER. Castor Oil packs over the liver are very beneficial, as is hot and cold hydrotherapy.
4 15 MINUTES LATER DRINK 2 CUPS OF HOT, STRONG DETOX TEA with 6 droppersful of my L-GB Formula in each cup.
5 WHEN THE PAIN HAS SUBSIDED A BIT, GIVE YOURSELF A HIGH ENEMA. Relax, take an hour to do it.
6 For any spasmodic pain and cramping in the liver, TAKE AN ADDITIONAL 4 DROPPERSFUL OF MY DIGESTIVE TONIC AND 1/2 TO 1 DROPPERFUL OF LUNG TONIC in an ounce of water.
NOTE: If the pain persists after an hour, repeat all of these steps using 5 cloves of Garlic and 5 tablespoons of Olive Oil.
I don’t recall any patient ever having to do this entire routine more than twice, before they got relief. The patient should then immediately start on my 5-Day LIVER Detox using the Liver and Gallbladder Flush Drink and my L-GB Formula, Detox Tea and Detox Formula. Remember, a gallbladder attack should be a wake-up call to change a person’s lifestyle to a liver-friendly one.
179
THE 5-DAY DETOX FOOD
You can eat or drink anything during your 5-Day Detox, but to achieve maximum results, I suggest the following raw food and juice flush program.
Fresh fruit or vegetable juice is the best way to get your vitamins, minerals and other essential nutrients. They are also very important for cleansing and detoxification.
Day 1 & 5 (Raw Food)
BREAKFAST: If you’re hungry before lunchtime, you may have fruit, diluted fruit juice and fruit smoothies. Stop all fruit and fruit juice at least one hour before lunch. It is best not to mix fruits and vegetables, while on this program.
LUNCH: For lunch, you can have fresh raw vegetable juices, raw vegetables (alone or in salads), sprouts, potassium broth and herb teas. You may use dressings for your salads and vegetables, if you like—use olive oil, avocado, raw apple cider vinegar, lemon juice, garlic, onions and any herbs and spices.
AFTERNOON SNACKS: Raw vegetables, raw vegetable salads, diluted vegetable juices, sprouts, potassium broth and herb teas. All vegetable foods and juices must be stopped by 6pm.
DINNER: Diluted fruit juices, fruit, fruit smoothies, fruit salads and herb teas.
Days 2, 3 & 4 (Juice Flush)
Now, we begin the 3-day fast. Consume at least one gallon (128 ounces) of liquid a day. That’s eight 16-ounce servings a day. If you get hungry, DRINK MORE LIQUID!!!
MORNINGS: Start with water, your morning flush, herbal teas/tonics and your morning SuperFood Plus drink.
180
LIVER Detox
The Solution: Dr. Schulze’s 5-Day
The Solution: Dr. Schulze’s 5-Day LIVER Detox
AND JUICE PROGRAM
MID-MORNINGS: Diluted fruit juices, herb teas and water until noon.
AFTERNOONS: Diluted vegetable juices, potassium broth, herb teas and water until evening.
EVENINGS: Diluted fruit juice, herb teas and water in the evening.
Day 5 (Raw Food)
Day #5 is the day you will be breaking your fast. Your food program will be the same as Day #1. Breaking your fast is a very important part of this program. Chew your food slowly, mixing each mouthful with plenty of saliva. Eat until you are satisfied, not full. You can always eat more later, if you are still hungry. Chew everything to a liquid pulp.
POTASSIUM BROTH RECIPE
This is a great-tasting addition to any 5-Day Detox program. It will flush your system of toxins, acid and mucous while giving you concentrated amounts of minerals.
Fill a large pot with:
25% Potato Peels
25% Chopped Whole Beets and Carrots
25% White Onions and Garlic
25% Dark Greens
Add hot peppers to taste. Add enough distilled water to just cover vegetables and simmer on very low temperature for 1–4 hours. Strain and drink only the broth. Make enough for two days, and refrigerate the leftover broth. Use only organic vegetables! We do not want to consume any toxic, immune suppressive insecticides, pesticides or inorganic chemical fertilizers while we are on a detoxification program.
My broth will flush you out and build you up. Start it now!
181
FOOD
A Letter From A More “Enlightened” Doctor About Dr. Schulze’s 5-Day DETOX Program.
Dear Dr. Schulze,
I have performed many cholecystectomies (surgical removal of the gallbladder) on my patients, during my professional career as a surgeon. In the past, I felt that your treatments, specifically your Liver and Gallbladder Flush, were quite harsh. But after reading about another doctor’s positive experience with the Liver and Gallbladder Flush, I decided to try it myself and on my wife. Subsequently, I have had my patients do it also.
I am now convinced that the Flush is not only safe, but effective in cleansing the gallbladder, the liver and even the entire body, resulting in energy and stamina galore. Considering the degenerative change in people’s present day lifestyle, I now find that I am in agreement with what you recommend, particularly your 5-Day BOWEL Detox and your 5-Day LIVER Detox.
Secondly, in the past I was often baffled by patients that would continue to have the same pain and complaints, after I removed their gallbladder. Particularly Post Cholecystectomy Biliary Dyskinesia (after surgical gallbladder removal the flow of bile is still interrupted). What we surgeons had never considered is that there may also be stones that could be lodged in the liver.
When surgeons do a cholecystectomy, they render only a partial treatment, with nary a thought that they might be leaving stones behind in the liver, thus sometimes causing a reoccurrence of the same problem after surgery.
Since today, surgical removal of liver stones is impossible, why not recommend your non-invasive, painless liver flush to remove the stones both in the liver and the gallbladder? And, give the patient a total cure! The Liver Flush is a simple procedure that any patient can do for themselves on the advice of the healthcare provider. Your Liver Cleanse requires no hospitalization, the necessary ingredients are inexpensive and readily available, the instructions are simple and the procedure is not uncomfortable nor distasteful.
Yours truly,
—T.H., MD,FACS

182 The Solution: Dr. Schulze’s 5-Day LIVER Detox


DR. SCHULZE DESCRIBES HIS HERBAL FORMULAE
Stimulate, cleanse and protect your liver and gallbladder and rid the body of parasites.
L-GB Formula

� FLUSHES and DETOXIFIES the liver and gallbladder
� PROTECTS liver cells from damage and eliminates parasites
� CLEANS the gallbladder and removes hardened sediment
� A HEALTHY liver cleans your blood and prevents disease
Botanical Ingredients:
Milk Thistle Seed, Dandelion Root, Oregon Grape Root, Gentian Root, Wormwood Leaf, Mojave Chaparral Herb, Black Walnut Hull, Hawaiian Yellow Ginger Root, Garlic Bulb, Fennel Seed, Artichoke Leaf CHAPTER 18
185
Dr. Schulze Describes His Herbal Formulae
Your liver is your blood filter. Every second of every day, it filters, traps, neutralizes, kills and eliminates poisons that you inhale, ingest and absorb. From common poisonous chemicals in the home, workplace or even on your dinner plate, to prescription drug residues, air pollution and worn out blood cells, there are literally millions of toxic trash bits circulating all over your body that your liver has to defend you against. Almost ALL cancer today is directly linked to toxic chemical exposure. Your liver is your defensive barrier. But, when modern living attacks your liver with a constant chemical barrage, it can’t do its job of protecting you.
The herbs in this formula are famous for their ability to stimulate, cleanse and protect the liver and gallbladder and rid the body of parasites. Milk Thistle contains many phytochemicals, three chief ones being silibinin, silydianin and silychristin. These three plant chemicals are often collectively referred to as silymarin. There are many ways in which these plant chemicals protect and heal your liver, too many for this book. But, two main ones are protection and regeneration. The phytochemicals in Milk Thistle actually strengthen the structure of the hepatocytes (liver cells) skin or membrane, which prevents the penetration of known liver toxins.
These protective chemicals also stimulate the action of the nucleolar polymerase A, resulting in an increase in ribosomal protein synthesis and thus stimulating the regeneration of damaged liver cells and stimulating the formation of new liver cells. These chemicals are so powerful they can even protect you from some of the most lethal poisons on the planet, like Deathcap Mushrooms. Simply put, ingesting Milk Thistle is like putting a protective coating around your current liver cells, while it also speeds up repair of damaged cells and building new strong cells.
Oregon Grape Rootbark, Gentian Root, Wormwood Leaves and Dandelion Root are some of the most bitter plants on the planet and are all classic bitter liver tonic herbs. They contain phytochemicals like berberine alkaloids and volatile oils, which stimulate the liver to produce more bile to flush out the bile ducts and gallbladder.
186
Black Walnut Hulls, Wormwood and Garlic are strong ANTIPARASITICAL plants. Parasite infestation is a fact of life. One cubic inch of choice beef can have over 1,000 living parasite larvae waiting to hatch in your body. Over 65% of fresh fish tested had toxic levels of bacteria and parasites. Chicken is even worse. I’ve had hundreds of patients expel toilet bowls full of intestinal parasites, tape worms over 30 FEET LONG and also kill cellular parasites with this formula. It works best if used in conjunction with both Intestinal Formula #1 and #2. Use if parasites are suspected, or if there has been a history of bowel problems, constipation, eating of animal products, prolonged illness, disease and degeneration. If you have been exposed to any toxic substances, or drank alcohol or other harmful beverages, this formula is for you. It is also beneficial if you have had high cholesterol, blood fats or any family history of liver or gallbladder problems. Many believe that anyone who has cancer or any immune dysfunction had a weak, congested liver to begin with. Even if a person has had their gallbladder removed, these herbs will still be effective to clean the liver and bile ducts.
Detox Tea

� DETOXIFIES the blood, liver and gallbladder
� STIMULATES and CLEANSES the entire digestive tract
� ELIMINATES gas and indigestion
� INCREASES the flow of urine
187
Formulae
Dr. Schulze Describes His Herbal
Botanical Ingredients:
Dandelion Root, Burdock Root, Cardamon Seed, Ginger Root, Pau d’Arco Bark, Cinnamon Bark, Clove Bud, Fennel Seed, Licorice Root, Juniper Berry, Black Peppercorn Uva Ursi Leaf, Horsetail Herb, Parsley Root, Orange Peel
The Detox Tea has numerous health benefits. It is literally an allpurpose herbal tonic. It is a powerful stimulant, especially to the stomach, liver and digestive side of the pancreas. It also cleanses the skin and detoxifies the blood, liver and gallbladder and is the perfect tea to use after the Liver Flush Drink. It stimulates your liver to produce more bile and then flushes away the bile and fats that congest your liver and gallbladder. This tea is an excellent coffee replacement. It tastes good and has no caffeine.
Ginger Root, Cardamon Seed, Fennel Seed, Cinnamon Bark, Black Peppercorns and Clove Bud are famous classic digestive herbs. They are extremely effective and have been a part of traditional Chinese, Indian, European and American herbal medicine for centuries. They are specifics for dyspepsia (basically gas), cramps, colic, bloating, indigestion, heartburn and nausea. They contain essential oils, that stimulate ALL aspects of digestion, from saliva excretion and digestive juice stimulation to antispasmodic, and even stimulate the villi of the small intestine for better assimilation.
Cardamon Seeds, Roasted Dandelion Root, Burdock Root and Orange Peel all stimulate the liver to excrete more bile. While Cardamon has essential oils that cause this hepatic action, the three later herbs all contain bitter hepatic stimulating phytochemicals. Dandelion and Burdock also stimulate the kidneys to excrete more urine, along with the Horsetail Herb and Parsley Root. Juniper Berries and Uva Ursi Leaf are also diuretics and urinary tract disinfectants. They make you urinate more and destroy urinary infections. Pau d’Arco Inner Bark is a classic South American immune stimulant and Licorice Root is soothing and healing to the lining of the entire digestive tract.
188
Describes
Formulae
Dr. Schulze
His Herbal
Some of the botanicals in this politically incorrect herbal formula have been vigorously attacked by our federal government and medical groups during the past century, some within the past 10 years.
Some of these herbs have been illegal to use, like Chaparral, which was outlawed for almost five years. Suppliers stopped selling it and herbalists sucked up politically. Instead, I harvested my own in the California deserts and continued to use it. After all, in my clinic, potent healing ability dictated which herbs I put in my formulations and used with my patients, NOT politics. How could I look a patient in the eye who was suffering and tell them that I know what helps, but legally I can’t sell it to you? Because I continued to use this herb during its prohibition, this became just one of the reasons my clinic was shut down. Other botanicals in the formula are highly discouraged by medical doctors like Lobelia Seed, Poke Root, even Red Clover Blossoms. Consequently, many herbalists (myself included), have been arrested and incarcerated for even discussing the benefits of these types of herbs, because of their association with treating cancer and chronic disease. Having said all of this, I must tell you that the herbs in this formula are classic and traditional blood and lymph cleansing tonics and the ones that I used successfully for many years in my clinic.
REAL PEOPLE. REAL RESULTS.
“I was diagnosed with Hepatitis in ’99, and now it’s 2004. I never had a liver transplant. After your program, my skin is clearer than it’s ever been. My health just keeps getting better and better. My eyesight is getting better. My prescription for my glasses has dropped two times in the last two years.”
— B.S. in Los Angeles, CA
189
Schulze Describes His Herbal Formulae
Dr.
Detox Formula

� The most powerful DETOX formula available anywhere
� CLEANS accumulated toxins and poisons out of the body’s blood and lymphatic system
� PROMOTES healthy skin and complexion
Botanical Ingredients:
Red Clover Blossom, Mojave Chaparral Herb & Resin, Oregon
Grape Root, Burdock Root, Yellow Dock Root, Poke Root, Goldenseal Root, Fresh Garlic Bulb, Lobelia Herb Seed, Habanero Pepper
This formula is based on the famous Hoxey Formula, Dr. John Ray Christopher’s Red Clover Combination (both herbalists were arrested on numerous occasions for these formulations) and many similar powerful alternative (blood-cleansing) formula from around the world. These herbs are used in herbal medical clinics worldwide for scrubbing the accumulated toxins and poisons out of the body’s blood, fat and cells and also heralded for their efficacy.
The following is common knowledge from highly respected and accepted medical text. According to pharmacology manuals, Chaparral contains nordihydroguaiaretic acid. According to the Merck Index, this acid from Chaparral is listed as an antioxidant with a Therapeutic Category, as an antineoplastic. According to
190
Dr. Schulze Describes His Herbal Formulae
Taber’s Cyclopedic Medical Dictionary, an antineoplastic is “an agent that prevents the development, growth and proliferation of malignant cells (tumors).”
This is by far one of my most powerful and strong tasting herbal tonics. You will want to add your 3 droppersful to 1 ounce of strong apple or grape juice and knock it back. This is an herbal Jack Daniels, not a fine wine. Don’t savor it. GET IT DOWN. You might even want a chaser.
191
Dr. Schulze Describes His Herbal Formulae


FINAL THOUGHTS ON LIVER DETOXING
My friend and CPA, Kirt, always says, “Look at the doughnut, not the hole.” So let me be clear... I love America, even if it’s filthy. I love my life and I LOVE LIVING IN AMERICA.
I learned long ago, that the best way to change anything is to start at home, not in the Senate, House of Representatives or in Washington, DC. So I take personal responsibility for the filthy state of our American water, earth and air, and I work to clean it up every day. You can help in an enormous way just by making better choices. I call it voting with your dollars. Choose to buy products from companies that are making an effort to not only stop polluting, but to also help clean up America.
If you want to know who the worst polluters are in your neighborhood, log on to www.scorecard.org sponsored by the Environmental Defense Fund. You just plug in your zip code and they will tell you who the bad guys are in your neighborhood. You can make a big difference just by not supporting these companies or, if you like their products, letting them know how you feel.
At my company, American Botanical Pharmacy, we are a National Leader in many areas of recycling and other earth-friendly policies. We are one of the largest buyers of what we call really recycled paper in America. We not only promote the use of hemp instead of trees, but also use post-consumer recycled paper (which I call really recycled since pre-consumer recycled isn’t recycled at all, it’s just new paper that was not used and then resold). There, now I let that cat out of the bag. We also choose paper that comes
193 CHAPTER
19
from the cleanest paper mills that DON’T use chlorine to bleach the paper, which ends up in the nearby streams poisoning and killing fish, birds and other wildlife, including your wild children.
At American Botanical Pharmacy, we only use starch ecofoam packing peanuts instead of plastic foam. And if we do use plastic bubble wrap, it is 100% recycled. We shred all of our recycled office paper and then reuse it as shipping material. Almost all of our waste is recycled and we throw very little away.
We use organic herbs and foods not only because they are more potent, but also because they are not toxic. Every year in America, billions and billions of tons of poisonous chemicals are dumped and sprayed on our soil, to the point where most of American land is now poison.
Today, organic herbs are very popular and most herb companies are being forced to convert to using them, unfortunately not because they want to, but because customers like you are demanding organic. But, unfortunately being grown organic and remaining organic and chemical-free until you put them in your mouth are two very different things. As far as I am aware and have been told by my many organic farmers and suppliers, American Botanical Pharmacy is one of the ONLY COMPANIES in America that demands that the organic herbs we purchase are NOT GASSED with toxic ETHYLENE OXIDE, an industrial antibacterial gas that is proven to cause cancer and birth defects. Apparently, other herb companies simply cave in and go with the toxic crowd. You will never see this on their labels, but it is the industry standard. This gas after use is vented into the open air and one such herb supplier—in fact, one of the biggest herb suppliers in America, one that supplies a large portion of herbal product manufacturers, Botanicals International in Southern California—was fined for polluting the air and endangering the nearby residents by letting ethylene oxide out of their herbal gas chambers.
194 Final Thoughts On Liver Detoxing
Every day, you cast a big vote when you spend your money. You literally promote and support and build companies and corporations and put other ones out of business. You can make some companies that share your philosophy grow big and other ones disappear.
This is what is so great about the American economic system of supply and demand, unlike the old Communistic system of government controlled businesses where the people end up getting whatever big brother thinks you should have. In America when you buy any product, you promote that company, and when you don’t buy the competitor’s product, well, they are just one more step towards closing their doors and going out of business. If you think that your opinion or your choices don’t matter, you are very wrong.
Make good informed choices with your purchases, not just the green-looking companies that give the green appearance, but really aren’t doing the work. The commonplace nowadays is that most manufacturers stamp on their products that their product is recyclable (not recycled). What they should really say is that they have done nothing and we want you to do all of the work. Please support companies that make the health of our land, air and water as big a priority as making a good product. If you will help me do this, we can clean up America in a heartbeat and make it a safer and healthier place to live, grow up, work and play in.
195 Final Thoughts On Liver Detoxing


FREQUENTLY ASKED QUESTIONS
The following are the most commonly asked questions and The following are the most commonly asked questions and concerns about liver cleansing.
How many times a year should I do the cleanse, and how long should I stay on the formulas when I’m cleansing?
For the average person who’s healthy and does not have any disease or illness, the great prevention is to have a one-week cleanse four times a year. That’s a week during the Spring, Summer, Fall and Winter. Pick a week when you can, for five, six or seven days in a row, perform a cleanse, an oil change, a prevention. Clean yourself up. My patients who did that rarely ever had any health problems or ever got sick. And, the length of it is a week long. That’s usually good enough for the person who lives a good, healthy lifestyle to prevent any problems from happening. Now, if you’re ill, certainly you can do it more often. And certainly if you’re ill right now, you can extend it. Remember, my Incurables Program starts with a minimum of 30 days of juice flushing and health programs. So, you can cleanse for as long as you want. But the minimum is one week, four times a year.
Do I need to reserve special days for doing my cleanse?
Everything in life works better when you prepare yourself for it. Mark out the days on your calendar at least a couple weeks in advance. It doesn’t do you any good to wake up in the morning and say, “Hey, I’m going to do my cleansing routine,” but you binged the weekend before and you open your refrigerator and there’s nothing you need to start your cleansing routine. Just like
197
CHAPTER 20
anything else you want to succeed in, a little preparation will really help you in being successful.
Is Juice Flushing mandatory?
Personally, if you want to get well, juice flushing is mandatory. My 5-Day Detox is two days of raw foods and three days of juice flushing. If you do it Monday through Friday, Monday and Friday are raw foods and Tuesday, Wednesday, and Thursday are juice flushing. When you go back into the last century, you look at any of the great natural healers and you’ll see that juice flushing was a foundation of the programs they used to get well. I don’t care who you study and who you look at. All my great teachers, like Paavo Airola, Dr. Bernard Jensen and Dr. John Christopher, used juice flushing as one of their primary healing tools. We should really call it juice flushing, because what you are doing is introducing a gallon a day or more of herb teas, distilled water, and fresh juices through your body that not only give you super nutrition but also flush out unwanted acids and salts and old minerals and toxic accumulations and chemicals. This is probably the greatest part of a Natural Healing cleansing and detoxification routine. So do not skip your juice flushing. I have seen it create miracle after miracle in the clinic. Juice flushing is what you want to be doing.
However, having said that, you do not have to do the whole program. You know, some mornings I wake up (don’t hesitate to try this) and I feel like I could use a Liver Flush, I feel a little sluggish. Or I feel like I could use a Kidney/Bladder Flush. So I make a Liver Flush Drink or a Kidney Flush Drink and I have it in the morning. And then, I just go about the rest of my day. Maybe have a SuperFood Plus drink a few hours later, and then a few hours after that I might have some lunch and then some dinner. So the point is, never hesitate to just wake up in the morning and do a flush drink, whether it’s the Liver/Gallbladder or the Kidney/Bladder. You don’t have to do the whole program.
I would rather see you modify the program all the way down to doing one flush drink, than not doing anything at all. Now, certainly it’s optimum to add in the juice flushing. Some people
198 Frequently Asked Questions
ask this question because they have diabetes and they’re afraid to do juice flushing. Let me tell you, I have had so many diabetics, both type one and type two, do my juice flushing program. You have nothing to worry about. Just use your good smarts and your common sense, and you can do it, too. Because the program is much more powerful, both the Liver/Gallbladder and the Kidney/Bladder, if you do it with the whole 5-Day Detox, which includes my 5-DAY Food Program.
Can you modify the 5-Day LIVER Detox?
Well, I never really expected anybody to methodically follow exactly what I said to do. You would have to be a robot to be doing things that way. All I want you to do is your best. Of course, the times can be modified. They can be modified to your lifestyle, and they can be modified to your workplace, because you’re probably doing the cleanse at your workplace. What I would like you to think about is this: at the end of the day, I would like you to have consumed all the foods, all the juices and all the herbs and herbal formulas that I suggested. And, space them out as much as possible. Do you have to follow my program down to the minute or the hour? No, you don’t. And you’d probably have a very hard time trying. In fact, any patient that follows any of those programs to a tee, well, I would worry about them. They may be a little bit neurotic. Sure, modify it to where it works with your life. The bottom line is I want you to do it. You’re never going to get well if you look at my 5-Day Detox and study it, but figure you can’t ever do it perfectly so you won’t do it at all. Do your best. That’s all I’m asking of any of you is, do your best at doing the program.
Do you suggest doing the Detox Formula along with the 5-Day LIVER Detox?
In the clinic, whenever I had a patient do my five-day cleansing and detoxification program, they did one of two things on top of it. They either consumed one entire two-ounce bottle of my Detox Formula, or they consumed one entire two-ounce bottle of the Echinacea Plus. The idea is, when you’re doing that cleanse and detoxification program, you either want to be scrubbing out your
199 Frequently Asked Questions
blood even more with the great herbal blood cleansers or boosting your immune system. So if you do the blood cleansers in the Spring, then boost your immune system in the Summer. But definitely do the Detox Formula, or Echinacea Plus, during your five-day cleanse. And remember to consume one entire two-ounce bottle.
What are the benefits of taking Intestinal Formula #1 and #2, while doing the 5-day LIVER Detox?
The bottom line is that when you flush your liver and gallbladder out, the waste that you flush out goes directly into your intestines and colon. If your bowel is not working properly or you are constipated this toxic waste cannot get out of your body.
Remember, your bowel is your major elimination organ for your solids. Some of the herbs in the Intestinal Formula #1 also stimulate your liver and gallbladder, so this helps with their cleansing. Also, by keeping your bowel clean, this takes the pressure off your kidneys and bladder and certainly will assist in their cleaning. So, it is very important to use your Intestinal Formula #1 and your Intestinal Formula #2. In other words, do your 5-Day BOWEL Detox during my other 5-Day Detoxes, whether you’re doing the Liver/Gallbladder Flush or the Kidney/Bladder Flush.
How do I improve my digestion after I’ve done your 5-Day LIVER Detox?
First of all, continue on Intestinal Formula #1. That speeds up your elimination, which will help take the pressure, especially any back pressure, off of your whole digestive tract. So don’t forget to use your Intestinal Formula #1. Secondly, use my Digestive Tonic. It is a godsend for people with all types of cramps and colic and indigestion and heartburn. Two droppersful in an ounce of water, knock it back, and your digestive problems are gone. It’s one of my personal favorites. And, lastly, there’s my Detox Tea, and it’s a wonderful digestive tea. There are so many herbs in it to aid your digestion, so if you’re a tea drinker this is a good formula for you, and it will help your digestion out, too.
200 Frequently Asked Questions
Can I really flush the stones out of my gallbladder and avoid having it removed?
Absolutely, you can. I’ve had thousands of patients with ultrasounds and X-rays showing they were packed full of rocks, and they got rid of their rock collection using this program. Gallbladder surgery is the most ridiculous surgery. It’s so stupid to cut a weak or sick organ out of the body. It’s like cutting your bowel out because it’s constipated. And I shouldn’t laugh, because many colostomies were performed on my constipated patients, before I got my hands on them. Surgery is only for people who won’t change their lives. In fact, almost all of medicine is for people who won’t change their lives and take responsibility for themselves. So, I can assure you that the 5-Day LIVER Detox will do exactly that. It will flush any stones, pebbles or rocks out of your gallbladder, through your digestive tract and you’ll eliminate them. In fact, on page 180 of this book you can read a letter from a surgeon, a medical doctor, who performed many cholecysectomies (surgical removals of gallbladders). Now, with his patients, he does my 5-Day LIVER Detox and finds it to work in every instance, and doesn’t do the surgery anymore. That is a very new type of medical doctor! Now we can give him some applause for seeing the light. I can assure you that the 5-Day LIVER Detox will do the job.
Which 5-Day detox should I do first, the Liver/ Gallbladder CLEANSE or the Kidney/Bladder?
There’s a couple ways to make this decision. The first has to do with your history. Have you had any problems with your liver and gallbladder? Have you had any gallbladder congestion? Do you have high cholesterol? Any history of hepatitis, or any family history of any liver or gallbladder problems? If you fall in that category, then yes, go ahead and start my 5-Day LIVER Detox.
On the other hand, if you’ve had kidney stones, kidney or bladder infections, frequent urination, or any family or personal history of kidney or bladder problems, then you should start with the 5-Day KIDNEY Detox. If you haven’t had any problems at all and have
201 Frequently Asked Questions
no family history of problems with either the liver, gallbladder, the kidney or bladder, then there’s a very simple way to decide. If your eyes are light brown or brown, then I would suggest that you do the 5-Day LIVER Detox for the first cleanse. And if you have blue eyes, then you should start with the 5-Day KIDNEY Detox. And if you have green eyes, well, you can go either way. And then on your next seasonal cleanse, do the other program. Now, if you have problems with just one, you can do that flush for the first two or three seasonal cleanses, but at least once a year try the other flush and the other herbs. So if you do the 5-Day LIVER Detox for Spring, Summer and Fall cleanses, then in the Winter do a 5-Day KIDNEY Detox. You should at least do the other cleanse one time a year.
Will I get better results doing a liver purge, like the ones that use epsom salts and olive oil?
There are many extreme programs out there, where you consume copious amounts of oil, copious amounts of citrus juice, Epsom salts, Coca-Cola…believe me, there are many of them out there. And only in maybe 1% of my patients’ extreme cases would I find those necessary (but never the Coca-Cola). Generally, I would just repeat my 5-Day LIVER Detox and Liver Flush Drink, and that would do the job. So I just want to caution people—there are a lot of extreme gallbladder flushes (or what people might call liver flushes), but that’s not what we’re talking about here. We’re talking about five days of a vegan raw food program, and within those five days, two to three days of juice flushing, along with my Liver Flush Drink and Detox Tea and L-GB Formula. People who do this program are shocked at how simple, easy, and effective my Liver Flush Drink and 5-Day LIVER Detox can be.
Have you heard the studies linking Tylenol with liver cancer?
No, I haven’t heard about the studies with Tylenol, but let me tell you something... ALL drugs have to be cleaned out of your blood by your liver, and all drugs kill your liver cells, therefore all drugs
202 Frequently Asked
Questions
kill your liver. The more drugs you’ve taken, the more your liver is dead. Immediately start on my L-GB Formula that contains Milk Thistle, which is a liver cell protectant, so you protect whatever cells you have left, and then immediately think about doing my 5-Day LIVER Detox, along with the Liver Flush Drink.
What do you think about chelation treatments?
I don’t like them. Chelation is usually taking the blood out of your body and washing it, or adding something to the blood of your body to clean it up. Sometimes minerals, sometimes other things. Let me tell you something. This stuff called skin that covers our body should not be broken for any reason. I do not believe in any therapy that involves shots, needles or puncturing the skin.
What if I’m diabetic, or if I don’t have a gallbladder, or if I have Hepatitis B? Can I still do the cleanse?
The answer is yes, yes, yes, across the board. Don’t use any of these excuses for not getting well. Because believe me, while you’re futzing around with should I or shouldn’t I cleanse, the doctors are grinding and sharpening their scalpels, they’re fixing up their deadly chemotherapy and they’re tuning in their laser and radiation beams. They’re not going to fool around. You walk in a hospital, they’re going to hit you hard and fast and you’re not going to know what blasted you. So, don’t let all of your piddly little problems and questions get in the way of you creating a new, healthy lifestyle and a great healing program to make yourself well.
203 Frequently Asked Questions

“It’s so silly that kidney and bladder disease has become an epidemic in America, especially since it’s so easy to prevent… and so simple to heal.”
— Dr. Richard Schulze

INTRODUCTION TO KIDNEY CLEANSING
Assimilate and Eliminate
The Old “In and Out”
You and every organ in your body, in fact, every one of your 100 trillion cells, have the same two basic functions—in and out, in and out, in and out. Assimilate nutrition in and eliminate waste out. And, when it comes to the out (the elimination of waste), your body only has two major ways to get this waste out of your body. Your solid waste is removed by your large intestine and your liquid waste is removed by your kidneys and bladder.
Your solid waste removal system (also known as your intestinal tract), is as long as two cars parked end to end. It is a big, long tube from your mouth to your anus. Your colon, just one part of this system, is the biggest organ in your body, measuring in at 7 inches in circumference and 60 inches long.
Your kidneys, on the other hand, are much more refined organs. They are comprised of approximately 2,000,000 very complex, microscopic units called nephrons that filter mostly liquid waste out of your blood. The end waste product is urine and is about 95% liquid and 5% dissolved substances like minerals, nitrogen waste products and even blood, pus, bacteria and microscopic parasites.
As I always say, on a very basic level, scientists and medical doctors understand the anatomy and physiology of the urinary tract (in other words, the basic parts and how they work). But this
205
Introduction To Kidney Cleansing
system (as you will see me describe in Chapter 22), like all systems of the human body, is really beyond mankind’s comprehension.
Early on in my medical career, it became very obvious to me that the human body was designed and put together by someone or some force much greater and much smarter than me. Therefore, the next simple, logical and common sense conclusion for me to make was to never attempt to heal this amazing machine from the inside, like medical doctors do with surgery, radiation, chemotherapy and even kidney transplants. But instead, healing the human body from the outside by creating a healthy lifestyle that would involve STOPPING my patients from doing what made them sick and what hurt their organs in the first place and STARTING them on new habits that healed their bodies and prevented future disease. This is what created the thousands of healing miracles in my clinic.
In this next section of my book, I will take you on a journey. In the next chapter, I will expose just how bad the kidney and bladder disease epidemic has gotten in America, from the over 40,000,000 Americans with kidney impairment, infections and disease to the
206
1.7 Billion 392 Million ADULT DIAPERS SOLD
2002 O ver 430% Increase!
1982
100,000 new cases of kidney and bladder cancer every year to the skyrocketing increase in sales of adult diapers.
Then, in Chapter 22, I will simplify the kidneys, bladder and the entire urinary system, so anyone can understand it. At least, you will know the basic parts and the fundamental ways they work, which can help when you, a loved one or a friend gets sick. More importantly, this information can help you get well.
In Chapter 23, I tell you all about kidney and bladder disease with lots of pictures that will hopefully shock and motivate you into Chapter 24, which includes my many natural flushes, routines and programs that I developed in my clinic to help you clean, detoxify, strengthen and protect your kidneys and bladder.
Friends, don’t be the Average American. Don’t suffer with painful and debilitating diseases that destroy and shorten your life. Don’t torture yourself with the horror, pain and bankrupting expense of medical doctors, hospitals and drugs.
My 5-Day KIDNEY Detox is my easiest program to do. In the clinic, my patients had amazing results just by doing a routine seasonal cleansing of their kidneys and bladder, and so can you!
207 Introduction To Kidney Cleansing


CHAPTER 21
KIDNEY AND BLADDER DISEASE:
THE PREVENTABLE EPIDEMIC
FACTS
� Over 40,000,000 Americans have kidney and bladder infections, impairments and disease.
� Incontinence, the new American epidemic, attacks over 25,000,000 adults.
� Over 300,000 Americans drain their blood with “mechanical vampires”, also known as dialysis machines.
� Kidney and bladder cancer attacks over 90,000 Americans.
There is nothing more debilitating and horrifying than kidney and bladder disease. Just imagine having your veins punctured and hooked up through plastic tubes to a machine that drains every drop of blood out of your body, because your kidneys are too degenerated to filter it themselves. You feel horrible and weak, because your blood is critically overloaded with toxic waste and poison. If you don’t have it drained out, you will die. This is like a recurring vampire nightmare that keeps playing over and over again, but you can’t wake up because…you are awake!
“The doctor of the future will give no medicine, but instead will interest their patients in the care of the human frame through lifestyle, diet, and in the cause and prevention of disease.”
— Thomas Edison 1847-1931
209
Kidney And Bladder Disease: The Preventable Epidemic
FACT
Over 40,000,000 Americans have kidney and bladder infection, impairment and disease.
SOLUTION: It’s very simple. Effective powerful herbal formulae and natural healing programs can stop kidney and bladder disease right in its tracks—chronic kidney disease often starts with a kidney or bladder infection, and because many are asymptomatic, many people don’t even know they have one. This is why my routine 5-Day KIDNEY Detox with Kidney/Bladder FLUSH Drink was a standard yearly protocol for ALL of my patients in my clinic. Also, every patient who came to see me with a kidney and bladder infection, healed it using herbs. EVERY ONE OF THEM, NO EXCEPTIONS, 100%. For over 20 years in the clinic, I saw kidney and bladder herbs destroy every type of infection in the urinary tract.
In fact, I still have audio tapes from my clinic answering machine with patients exclaiming their shock and surprise that my herbal formulae “did what no medical doctor or antibiotic could do,” which was cure their chronic kidney and bladder infections.
These same herbs I discuss in this book are so powerful that they are now listed as diuretics and urinary antiseptics in the Merck Manual, a leading medical chemistry book published by a drug manufacturer.
FACT
INCONTINENCE, the new American epidemic, attacks over 25,000,000 adults.
SOLUTION: I had a female patient named Joan, who was about 50 when she came to see me. Her life had been devastated, literally ruined by over 20 years of incontinence. This poor woman had no life— her husband divorced her, she had no social life, lived in adult diapers and rushed home every day after work to hide in her apartment, covered with urine. She hadn’t had a date or made love in 15 years.
210
Kidney And Bladder Disease: The Preventable Epidemic
Kimberly-Clark reports sales of their Depends™ Adult Diapers have skyrocketed, increasing 85% in just the last few years.

The medical doctors said that there was nothing that could be done. What they should have told Joan was that there was nothing that THEY knew of that could be done. After just a few months of simple lifestyle changes and my Kidney and Bladder Programs, her incontinence was subsiding and she started going out, dating and even taking ballroom dancing lessons. I didn’t see her for a few months, and then all of a sudden, I got a postcard through my clinic mail slot from her. She was in Europe CLIMBING THE MATTERHORN WITH HER NEW HUSBAND!!! So much for incurable!
If you’re one of the 25,000,000 Americans living with the shame and embarrassment of incontinence, you don’t have to suffer and miss out on life! It’s time to DO SOMETHING ABOUT IT! Remember, everyone DIES, but not everyone really LIVES!
FACT
KIDNEY AND BLADDER CANCER attacks over 90,000 people every year.
SOLUTION: Undetected and untreated kidney and bladder infections are most often the beginning of organ scarring, degeneration and cellular breakdown. Eventually you get kidney failure, and all too often… cancer, which eats you alive from your urinary tract out. This is so unnecessary, because it is so easy to prevent. Not only because kidney and bladder infections are 100% curable, but also because it is a common medical fact that if you make sure that you drink only two quarts of liquid a day (water, fresh juice and herb tea), you REDUCE your risk of developing kidney and bladder cancer by 50%. That’s right, you heard it right, drinking more water PREVENTS kidney and bladder cancer! The reason for this is very simple. There are many
211
Kidney And Bladder Disease: The Preventable Epidemic
potentially carcinogenic (cancer-causing) toxic chemicals and waste materials found in urine. If you drink less liquid, your urine is more concentrated and also flows less frequently. This longer exposure time of concentrated urine against the delicate inner tissues of your bladder increases irritation, infection and eventually cancer. Drinking more liquid, especially water, juice and herb tea, dilutes these poisons in your urine. And, it also creates more urine flow, which in turn reduces the exposure time these potentially carcinogenic chemicals have in your bladder. In other studies, just one glass of high quality cranberry juice was found to reduce bladder infections by 80%.
Sure, as usual, modern medicine is ignorant of simple healthy living and lifestyle changes that can prevent or heal kidney and bladder disease. Medical doctors and hospitals can make a lot more money treating urinary disease with a dialysis machine at a cost of about $75,000 a year per person, on average. Remember, the old medical credo, the hippocratic oath, a patient healed is money lost. So, friends…
Don’t be the next victim. Protect yourself by preventing kidney and bladder disease. In this case, just a few more ounces of water is worth a pound of cure. However, if you already suffer from ANY kidney or bladder infection or disease start NOW on my 5-Day KIDNEY Detox outlined in Chapter 24 (see page 239) of this book.
212
STOP! STOP! STOP!

Don’t
be one of the hundreds of thousands undergoing Kidney Dialysis Treatment!
THE URINARY SYSTEM SIMPLIFIED

Adrenal Glands
KIDNEYS
Renal Artery
Renal Vein
Vena Cava
Abdominal Aorta
Ureters
Liver & Gallbladder
Urethra
BLADDER
214
CHAPTER 22
ANATOMY AND PHYSIOLOGY OF THE KIDNEYS AND BLADDER
Your body has a BLUEPRINT, a SCHEMATIC, of what perfect health is and is constantly trying to achieve this goal for YOU!
At last, a basic understanding of your kidneys, bladder and urinary system that your medical doctor wouldn’t tell you about. And, even if medical doctors did talk to their patients and explain things, you would need a dictionary in Greek, Latin, late Latin, French, ancient Anglo-Saxon, Old English, numerous other languages and scientific terminology to decipher all their secret code words.
I have broken down all of their 10-dollar words, so you can understand the basics of what your kidneys and urinary bladder look like, where they are, what they do and how they do it, at least as far as we know.

So don’t be scared, take a deep breath, and in 10 minutes you’ll know all you’ll need to know about peeing, and then some!
Very simply put, your urinary system is comprised of two kidneys, one bladder and a series of tubes. The kidneys look similar to kidney beans in shape and also have a similar purple-brown color. They each weigh about five ounces and are about the same size as the palm of your
215
Anatomy And Physiology Of The Kidneys and Bladder
hand, not including your fingers or thumb. You have one on each side of your spine.
Normal Kidney

Renal (Kidney) Pyramids (Each pyramid contains 50,000 to 125,000 nephrons)
Renal Artery
Renal Vein
Ureter
The top of each kidney is at about the 12th thoracic vertebra, the bottom being at about the 3rd lumbar vertebra (from your mid to lower back). They are almost completely covered by your lowest back ribs.
The inner side (spinal side) of each kidney has an indentation (the smaller curve of the kidney shape), which is called the hilus or hilum. This is where the renal artery, renal vein and ureter—which take blood in and out, and take urine out—connect and go into your kidneys. The renal artery (“renalis” is Latin for kidney) brings blood to the kidney to be filtered and cleaned. The renal vein returns clean blood to your body. The waste liquid, urine, leaves the kidney via the ureter. Both the ureters from each kidney connect to the bladder. As with all metabolic processes of the human body, this process of blood filtering and urine formation is also very intricate, detailed, complex and similar to when I talked about the liver.

In other words, this is beyond mankind’s comprehension. Knowing that, I will simplify this
216
Pathologist View Of Renal Pyramids
Anatomy And Physiology Of The Kidneys and Bladder process, so you will have a basic understanding of what the kidneys do and how they do it.
Each kidney is divided into between 8 and 18 wedge-shaped chambers, called renal pyramids. Each of these pyramids contains the many parts of the kidney required to filter the blood. The outside of each renal pyramid is called the renal cortex (“cortex” is Latin for rind or outer edge), and the inside closest to the hilus or smaller curve of the kidney is called the renal medulla (“medulla” is Latin for inner or center).
KIDNEY NEPHRON
Proximal Convoluted Tubule
Renal Cortex (Outer Kidney)
Renal Medulla (Inner Kidney)
Glomerulus
Bowman’s Capsule
The renal artery branches off inside the kidney to form numerous smaller arteries, which enter the outer portion of the kidney, the renal cortex. A very small renal artery branch eventually enters one of the many nephrons (“nephros” is Greek for kidney).
Distal Convoluted Tubule
Capillaries

Loop Of Henle
Collecting Tubule
The nephrons are the individual small filtering units in your kidney, and it is believed that each kidney contains approximately 1,000,000 of these nephrons.
Inside each nephron is a renal corpuscle and a tubule. The renal corpuscle is made up of a capillary network called a glomerulus, enclosed in a Bowman’s capsule. The renal tubule extends from the Bowman’s capsule, via the proximal convoluted tubule, the loop of Henle, the distal convoluted tubule and the collecting tubule all of which are surrounded and wrapped by peritubular capillaries.
217
Anatomy And Physiology Of The Kidneys and Bladder
NOTE: Capillaries, from the Latin “capillaris” meaning hairlike, are the smallest of the blood vessels/tubes, averaging 0.008mm in diameter. They connect the very ends of the smallest arteries (arterioles) to the beginnings of the smallest veins (venules).
Eventually, the filtered blood waste (urine) enters into collecting tubules and then on to the papillary ducts, which are in the renal medulla (or the inner or center portion of the kidney). These papillary ducts eventually empty into the ureter, through which the urine leaves the kidney.
I know that for those of you who just want to do my Kidney/ Bladder Flush Drink and 5-Day KIDNEY Detox, this information is not only an anatomical overload, but downright unappetizing—hang in there with me for a few more minutes, and it will begin to make some sense.
It is the kidneys’ job to filter blood plasma, return good blood to the body and create urine to carry waste out of the body. Your blood plasma is the liquid that your blood cells (including your red blood cells) swim around in.
NORMAL BLOOD

While many know that most cars have water-cooled engines, the human kidney is a waterrun waste removal system. Much of the water that you consume is necessary to clean the blood and flush waste material out of the body, via the kidneys. The kidneys also regulate the water, electrolyte and acid/alkaline balance of the blood and, indirectly, all body fluids.
218
Blood Plasma
Blood Cells
How It All Works
Blood enters your kidneys in the inner indented section (hilus) closest to the spine, via the renal artery. Inside of your kidney, this artery divides down into many other smaller arteries that enter one of the pyramid-shaped separate kidney chambers (renal pyramid) and branch down into even smaller arteries in the renal cortex. One of these small arteries enters a very small microscopic sac (nephron), which is an individual filtering unit. As blood passes inside the nephron into the renal corpuscle, through the glomerulus and Bowman’s capsule, water, dissolved substances and small bits are filtered out of the blood. But, big things like blood cells and large proteins are retained in the capillaries and blood. As the water and dissolved substances that were filtered out of the blood (which is now called glomerular filtrate or pre-pee), pass through the renal tubules, the proximal convoluted tubule, the loop of Henle, the distal convoluted tubule and the collecting tubule, it moves into the other area of the kidney called the renal medulla. Here, the urine goes into the papillary ducts and eventually leaves the kidneys through the ureter.
Useful materials such as water, glucose, amino acids, vitamins and minerals are reabsorbed into the blood, via the small capillaries. This reabsorbing is monitored and limited by your body. The reabsorbing of nutrients is stopped if you have too much of a nutrient already, and the reabsorbing of water is regulated by hormones.
The kidneys not only filter the blood, but they also regulate the physical properties and composition of the blood by monitoring the acid-alkaline balance. What is left in the remaining liquid, now urine, is about 95% water and 5% dissolved substances. The dissolved substances are minerals (especially sodium), nitrogenous waste products like urea, uric acid, creatine, creatinine, ammonia, chlorides, calcium, magnesium, phosphorous and many other substances like blood, pus, bacteria and parasites (all depending on the disease or health level of the person).
219 Anatomy And Physiology Of The Kidneys and Bladder
Anatomy And Physiology Of The Kidneys and Bladder
The urine leaves each kidney, via the ureter and both right and left kidney ureters connecting to the bladder separately, on the corresponding side. Bladder is a general term from the AngloSaxon “blaedre”, meaning a sac or receptacle for a secretion, like the gallbladder. The urinary bladder then, of course, is the muscular receptacle for urine—without it, your urine would just constantly run out of your body. The bladder is in the lower front of your pelvic cavity. In women, it is in front of the vagina, and in men in front of the rectum.
The bladder has a normal storage capacity of about a quart or more. When the bladder fills, it stretches, which initiates nerve impulses to the spinal cord. When you want to urinate, returning motor nerve impulses simultaneously cause contraction of the bladder and relaxation of the bladder sphincter muscle. This process can be stopped temporarily by the voluntary contraction of the external urethral sphincter muscle.
At the very bottom of the bladder is the urethra, a tube that the urine passes through to leave the body. On a man, this tube passes through the center of the prostate gland and then out through the center of the penis and out the end. It is also used for the passage of semen. This is why when a man has a swollen prostate (due to sexual function or disease), it squeezes off the urethra making voiding urine very difficult. In a woman, the urethra leaves the bladder, and the orifice where the urine is voided is in the vestibule between the vagina and the clitoris.
OK, enough is enough. Knowing a few of the details can not only help you understand your illness if you have kidney disease, but also will help you to understand when I explain my kidney and bladder cleansing, detoxification and healing programs.
220
Diagnosis Of Urinary System Disease
The “Amount” Of Urine
Normally, a person should urinate about four to six times a day. This amount can vary greatly, depending on the amount of liquids you consume, how much you weigh and how much you are exercising, breathing, sweating, etc. The average person eliminates between one and two quarts of urine a day. Any change in the amount of urine excreted can be a sign that something is wrong with the urinary system.
The “Look and Smell” Of The Urine
Since recorded history, people have noticed that another sign of urinary system disease is a change in color, transparency, and smell of the urine—so, examining urine was something all doctors did thousands of years before modern medicine. I have studied with many traditional doctors who examined urine with just their eyes and nose and diagnosed many diseases and metabolic imbalances, better than many modern urologists with their high tech laboratories. Even modern medical texts contain pages of descriptions of urine colors and smells to help doctors diagnose urinary illness. Just a few of the colors in medical text are blue, black, bile-colored, colorless, lime green, milky, orange-red, pale, red and reddish, and the odors listed are endless, from fishy and new-mown hay to over-ripe apples.
So again, any changes in urine quantity, color, transparency, odor, specific gravity, dilution ability and acidity can be a warning sign that your body is out of balance and your kidneys are unhappy and starting to get damaged.
If you are interested in further study of disease diagnosis from changes in the urine, read “Ancient Healing Wisdom Blows Away Modern Technology” on page 236, or consult your local medical university bookstore.
221 Anatomy And Physiology Of The Kidneys and Bladder

“All diseases and imbalances that cause the destruction of the kidneys can be TOTALLY REVERSED. GETTING WELL IS EASY... STOP doing what is making you sick. START doing what will heal your BODY.”
— Dr. Richard Schulze

THE PROBLEM: KIDNEY AND BLADDER DISEASE
In the past 10 years, the number of Americans with kidney failure has doubled to more than 400,000 now being treated at a cost of $25 BILLION annually.
Diseases That Cause Urinary System Breakdown And Illness

Toxemia
Most damage to the kidneys and their ability to filter and clean your blood is caused by toxemia (excessively dirty blood), which is the result of a degenerative lifestyle.
If your blood has too much toxic waste in it, it is very hard on your kidneys. This can be caused by being constipated, having pounds of old fecal matter in your bowel and reabsorbing the poisons back into your blood (known as auto-intoxication). Your food program may also be too high in junk food, which is laden with toxic and poisonous chemicals from preservatives and insecticides. With a high level of poisons and toxins in your bloodstream, from your retained waste and your food program, your kidneys don’t stand a chance and can’t handle the filtering job. They are just plain overloaded. It is like expecting your oil filter in your car to do its job, when you haven’t changed your oil in 100,000 miles and it is filled with impurities.
223
CHAPTER
23
The Problem: Kidney And Bladder Disease
Your oil filter (kidney) is just going to fail and your oil (blood) is just going to stay dirty, until your engine (body) quits.
All of this toxic waste build-up in your kidneys is a leading cause of kidney and bladder cancer.
If this is you, make sure that along with my 5-Day KIDNEY
Detox (see Chapter 24), you also need to do my 5-Day BOWEL
Detox (see Chapter 7) and start a healthy food program.
Hyper-Cholesterolemia & Hypertension
Your liver and gallbladder may be congested, overloaded and plugged, because your food program is too high in animal foods. This causes hyper-cholesterolemia (high cholesterol levels), which in turn causes hypertension (high blood pressure). High blood pressure causes almost half of all kidney disease.
Your kidneys have a much harder time filtering out thick, fatty blood, than filtering out thinner blood. This is just basic physics. Try pouring water through a coffee filter. It will run through the filter very quickly. Now try pouring in and filtering ice cream or cheese. Not very easy, is it? Saturated fat from animal foods makes your blood very thick, increasing your cholesterol level and making it very difficult for your kidneys to filter your blood. In fact, it will clog the tiny filtering capillaries and nephrons in your kidneys, rendering them incapable of filtering anything.
This fatty blood is also much harder for your heart to pump around your body, so your heart has to increase its pumping force (your blood pressure). Again, this is basic physics. If you are pumping water through a pipe 100 feet long and now you want to pump cheese instead, it will take more pressure to pump a thicker mass. This causes high blood pressure and higher pressure ruptures and hemorrhages the very tiny capillaries and microscopic parts of your kidneys’ blood filtering system, scarring and eventually killing them.
224
If this is you, make sure that along with my 5-Day KIDNEY
Detox you also do my 5-Day LIVER Detox (see Chapter 17) and begin a healthy, vegetarian food program.
Diabetes
High blood sugar or diabetes causes most of the other half of kidney disease, that high blood pressure doesn’t. There are many known ways in which high blood sugar hurts the kidneys and many additional theories. Again, the micro-filtration systems of the kidneys are very fragile to blood viscosity, pressure, toxic waste and severe blood imbalances, like diabetes. Diabetics have excessive urination, hence the name diabetes (from the Greek meaning passing through). These comprise just some of the reasons being a diabetic can cause the rupture, breakdown, eventual scarring and lesions on the small, delicate, kidney filtering micro parts and render them at first incapacitated, and eventually, incompetent and dead.
DEATH ROW DIALYSIS

Kidney dialysis is really a death sentence, like a ticking time bomb. After five years on dialysis, only about 1/4 of the people are left alive. After 10 years, less than 8% are still living. On dialysis, you actually die sooner than the average person rotting to death with malignant cancer. Whether you know it or not, your doctor is just waiting for someone else to die, so they can cut a kidney out and sew it into you. On average, this “cadaver kidney” and you will be dead in nine years.
225
Problem: Kidney And Bladder Disease
The
The Problem: Kidney And Bladder Disease
NORMAL KIDNEY
Renal Papilla
Calyces
Medulla
Cortex

DISEASED KIDNEYS

Renal
Artery
Renal
Vein
Renal
Pelvis
Ureter

226
POLYCYSTIC KIDNEY
KIDNEY CANCER
The Problem: Kidney And Bladder Disease
In my clinic, I treated hundreds of diabetics, all of whom, if they were willing to go far enough, got their diabetes under control and off of any insulin with a healthy food program, exercise and routine cleansing and detoxification programs.
The Bottom Line On Any Kidney, Bladder Or Urinary System Disease
I have seen a lot of strange things in my life, especially in my clinic. But, I’ve never seen a kidney walk into my office, lie down on my examination table and say, “Doc, I don’t feel so good.”
Early in my practice, I realized that there is a real person in my office and that the true problem is probably NOT where the pain is, and true healing is getting to the cause of disease. Medical doctors have a bad habit of looking at where the pain is or where the final breakdown occurs. So, with kidney disease, the medical doctor reacts by looking at the kidneys (seeing that they are failing, inflamed or falling apart), then suggests kidney medications and dialysis and eventually puts you on a kidney transplant list. This is as stupid as if you put cola, coffee or cow’s milk in the gas tank of your car, and then blame the engine when it quits running. Sure, the engine doesn’t work, and may be damaged, but the cause of the problem is NOT the engine. The engine can run again just by flushing and cleaning it out and putting some proper fuel in the tank. Any grease monkey kid knows this. Maybe we should make all medical doctors take a year of basic auto repair, before they start their pre-med curriculum.
Even if the medical doctor realizes that your kidneys are selfdestructing because of your high blood pressure or fatty blood, most doctors think this is just the normal disease process of the American lifestyle and that you are incapable of any modification. This may include taking on of some radical, extremist health program like eating less meat, drinking a little juice and walking. Consequently, medical doctors rarely suggest any changes in your lifestyle. They try to HEAL your kidneys or any failing organ, without your help! This buys time, but it never heals.
227
The Problem: Kidney And Bladder Disease
DISEASES OF THE KIDNEY

LARGE RENAL CYST

UNTREATED POLYCYSTIC KIDNEY AND AFTER DIALYSIS

A Picture Is Worth A 1000 Words
The only reason your kidneys are failing is because the blood that they are trying to filter is more like a toxic sludge. If you clean up your lifestyle, improve your food program and flush out your elimination organs (especially your bowel, your liver, gallbladder, and of course, your kidneys) your kidneys and body will heal themselves.
228
KIDNEY TUMOR
DIFFERENT KIDNEY STONES
“Jackstones”
“Mulberries”

Kidney Stones
“Gravel”
“When I was a kid, I remember hearing my dad screaming in pain in the toilet, then coming out in about 15 minutes, totally soaked in sweat. I later discovered that he had passed a kidney stone. For those of you that have never passed a stone, you don’t want to know the pain and torture of it all. Although I have never personally passed one, I had many patients that did, some right in the bathroom of my clinic. Most described it as a pain so severe, that it took their breath away. Some dropped right to the floor, crying and screaming. There is no running away from it and it feels like you are peeing a combination of sharp broken glass and boiling acid. From the amount of blood in some of my patients’ urine, it looked like they were bleeding to death. Not a pleasant experience at all.”
Because the kidneys try to filter acids and minerals out of your blood, but get overloaded as I stated earlier, you can get a build-up of mineral gravel, stones, acid crystals and mineral plaque inside your kidneys. This sediment can build up over years and turn into rocks, but it can also literally turn your kidneys into petrified rock. It can take over your entire kidney structure and eventually become fossilized.
The vast majority of all kidney stones are made up of calcium. Isn’t it interesting, that we always seem to be trying to get more calcium into our diets?
In many people’s attempts to get more calcium into their bodies, ironically, they actually lose more instead. This often happens
229 The Problem: Kidney And Bladder Disease
The Problem: Kidney And Bladder Disease
TYPES OF KIDNEY STONES



when women, worried about osteoporosis, start drinking more milk and eating more dairy products.
Animal food is very high in calcium, but also very high in protein. When you consume it, as part of the digestive process of any high-protein food, you often end up peeing out more calcium, because your body attempts to utilize all this protein. All this calcium pouring out of your blood and flooding through your kidneys actually overloads your kidneys with calcium. And remember, over 70% of all kidney stones are calcium rocks!
So, what you want to do is not only get more calcium into your mouth, but also get calcium that will stay in your blood and eventually get into your bones, not getting urinated away. This is why low-protein, but highcalcium foods, are much better choices and we can retain the calcium in our blood.
Carrots, citrus and greens are much better choices than high-protein milk and dairy products. Ounce for ounce, organic carrot juice made at home in your own juicer has as much, if not more, calcium than
230
15% of all stones are magnesium, ammonium and phosphate stones.
15% of all stones are uric acid stones.
70% of all stones are calcium stones.
cow’s milk—and, you don’t pee all the calcium into the toilet. Plus, it tastes better. If you are not used to the taste of carrot juice, then mix it with a little, (or a lot), of apple at first, until you get used to it. This is also a great way to get the kids drinking carrot juice—combine 90% fresh organic apple and 10% fresh organic carrot. Any kid will love that.
NOTE: This same calcium plaque that causes kidney stones also builds up in coronary arteries and cerebral arteries, along with cholesterol, causing heart attacks and strokes, and is caused by a diet high in animal foods.
DISEASED KIDNEY

The latest fad high-protein diets (like Atkins and the Zone), can take people’s weight off, but can also turn your kidneys to stone. Most medical books suggest the first place to look when a patient has kidney stones is the diet—and, if they are on a highprotein diet, get them off it, immediately. Over the years, the tabloids have been full of reports about Hollywood stars having to be hospitalized for hurting their kidneys with these high-protein weight loss diets.
Other stones are formed from uric acid and actually form uric acid crystals in the kidneys. Again, this build-up is often caused by a diet high in animal foods (which contain tons of uric acid), along with processed foods, junk foods, etc.
Most medical texts state that alkalinization of the urine through diet can dissolve uric acid crystals and stones. In my clinic, I would use both the alkalinization of the urine through a raw food and juice program, my 5-Day KIDNEY Detox and foods and herbs that dissolve urinary stones and gravel. Use K-B Formula and K-B Tea to dissolve all types of stones, uric acid, calcium... EVERY TYPE OF STONE!
231
The Problem: Kidney And Bladder Disease
Staghorn Stone
Kidney Stones

Remember, the alkalinization of the urine and blood has nothing to do with the pH (acid or alkaline) level of a particular food, but how the food reacts to your body’s metabolism. In other words, acidic foods with a low pH like citrus and apple cider vinegar actually have a very strong alkalizing effect on your urine and blood. Generally, foods that have an alkalizing effect on your body fluids are fruits, vegetables, sprouts, raw foods and juices. Foods that have an acidifying effect are animal foods, processed foods, sugar and junk food—you know, the bad stuff.
So, getting on a good raw food and juice program can dissolve stones, rocks, crystals and any kind of sediment in your kidneys.
If You Don’t Want Rocks And Gravel In Your Kidneys, Stop Eating Rocks And Gravel
Since calcium and uric acid are what most kidney stones are made of, just by stopping eating animal foods you can halt the formation of stones. Refraining from eating stones, gravel and dirt is also very helpful.

Since most mineral supplements are made from rocks, gravel, stones, pulverized oyster shells, old animal bones and even metal, eliminating this junk mineral supplementation can also prevent the formation of kidney stones. I would put all of my patients that either had kidney stones or a family history of them on my SuperFood Plus. The minerals in SuperFood Plus will give you a nutrient blast, but will not contribute to the formation of stones. In fact, SuperFood Plus will alkalinize your blood, which will actually help you to dissolve stones.
232
The Problem: Kidney And Bladder Disease
Cystic Stones
Uric Acid Stones
Uric acid crystals in the kidneys are easy to dissolve, quickly. Small calcium gravel and plaque is easier and faster to dissolve than one large stone. Regardless of the size of your crystal and rock collection, if you have or even suspect any type of sediment, gravel or stone in your kidneys or bladder, or have been diagnosed by a doctor as having them, it is time to get to work.
As a minimum, do my 5-Day KIDNEY Detox (see page 239), which includes the Kidney/Bladder Flush Drink and all of the Kidney/Bladder Herbal Formulae.
If the problem still persists, I suggest doing my 5-Day KIDNEY Detox for an additional week. You can also do my Kidney Stone Dissolving Routine (see page 243) that I used in my clinic to literally dissolve thousands of kidney stones.
Apples: The Dissolver Of Calcium And Uric Acid Stones A Dr. Schulze Demonstration
Fill a canning jar about three-quarters of the way up with apple cider vinegar (acetic acid) or use white vinegar, which is clearer and makes it easier to see. Now, I never advise consuming white vinegar—this is only for this experiment. Place a chicken egg into the solution. I know this is gross and if you’re a vegan, borrow an egg from a neighbor—a picture can be worth a thousand words. Within a few days, the vinegar will dissolve all of the eggshell, which is made of calcium, but it will not harm or dissolve the thin membrane that holds the egg together. In this same way, phytochemicals in raw apple juice and apple cider vinegar can dissolve calcium stones in your kidneys, but never harm nor irritate the delicate membranes.
233
The Problem: Kidney And Bladder Disease
DISEASES OF THE BLADDER





Bladder Cancer
These are large cancerous tumors found inside the bladder. There are over 60,000 new cases of bladder cancer diagnosed every year!
Incontinence
From fecal impaction pressing against the bladder to prescription and over-thecounter drugs, such as antihistamines, antidepressants and heart & blood pressure medications, the causes of urinary incontinence are endless!
Bladder Stone
Bladder stones are usually the result of another urologic problem, such as urinary tract infection or an enlarged prostate. Approximately 95% of all bladder stones occur in men.
Cancerous Tumor
This is a cancerous tumor on the external wall of the bladder.
234
The Problem: Kidney And Bladder Disease
Bladder Infections: The Statistics
One of the most common types of all infections in men and women are bladder infections. They are sometimes referred to as cystitis (“kystis” is the Greek word for bladder and “itis” for inflammation).
� Women are 50 times more likely to get bladder infections than men.
� 95% of bladder infections are caused by bacteria entering the opening of the urethra and literally travelling up the urethral opening into the bladder.
� About 80% of these bacterial infections are caused by the gram-negative Escherichia coli bacteria (e.coli) and the rest usually by other well-known bacteria.
In my clinic, I saw two major reasons for bladder infections (especially in women) and both were based on sexual activity. Most common was when one of my single female patients had not been sexually active for a time, then met Mr. Right and had a weekend fling, making love just about all weekend long. During sexual intercourse, lots of generally benign bacteria that are very common to the male and female body (like e.coli), are spread around the vaginal and urethral openings. Just urinating will flush these bacteria out of the urethra and prevent a bacterial infection. But sometimes, couples fall asleep after intercourse and sleep all night, which gives the bacteria time to work their way up into the bladder. No matter how unromantic this sounds, GET UP AND PEE soon after intercourse. This will reduce your chances of getting a bladder infection to almost nothing.
The other most common causes of bladder infections are antibiotics, spermicides (used for diaphragms and on condoms) and any other medication that is proven to imbalance your vaginal bacterial flora and permit the overgrowth of e.coli bacteria. In any case, everyone (men, women, sexually active or celibate,
235 The Problem: Kidney And Bladder Disease
The Problem: Kidney And Bladder Disease
with cystitis or bladder infections and even infections of the urethra or ureter) is treated exactly the same, as kidney infections, by following my 5-Day KIDNEY Detox in Chapter 24. My program worked 100% of the time in healing any kind of bladder infection.
Ancient Healing Wisdom Blows Away Modern Technology
Many years ago while working in a clinic in Asia, I was told of a rural doctor that had an almost perfect success rate at diagnosing urinary tract diseases and many other illnesses from studying his patients’ urine. I traveled to visit his clinic, which to my surprise was not much more than a mud hut. He would ask the patient to urinate into a cup. After the patient gave him a urine sample, he would walk out the back door of the hut, come back through the door in a few minutes, and have his diagnosis (which according to what I observed, was incredibly accurate).
When I asked him if I could observe his laboratory tests and evaluations, he invited me through the back door of his hut to a small table and chair out back. The first thing he would do was look at the urine in the clear glass with the sun behind it and study the color. Next, he would take a long, deep sniff (similar to a wine taster deeply inhaling a fine Chardonnay) and would then often mumble something. He would then proceed to pour some of the patient’s urine on an ant hill, taking the leftover to the table. He first divided it into two bowls, and then proceeded to drop various herb powders and grains into the urine. In a few minutes, he went back and checked the ant hill and then the urine on the table in the bowls. Then, without hesitation, walked back into the hut and gave his incredibly accurate diagnosis. After a few days, I figured some of his genius out.
First, he checked the color and transparency of the urine, which can tell you everything from liver disease and kidney inflammation to poisoning. Then he smelled the urine, which can give you 100 more clues. The human eyes and nose are still much
236
The Problem: Kidney And Bladder Disease
more sensitive than any laboratory equipment ever developed, although many doctors don’t like to admit it. The rate at which his ants were attracted or repelled by the urine told him many things, including the amount of sugar in the urine. Diabetes is the #1 cause of kidney disease, so he needed to rule that out. Dropping herb powders in the bowls of urine samples told him many things from specific gravity to dilution ability (both tests for kidney and pancreatic disease). He also could tell the acidity of the urine (by which certain herbal flowers changed color), which can tell you about everything from infections to low-grade fevers. All I can say is a few days with this man taught me more than a year in a hospital lab, especially in using my favorite diagnostic protocols of simplicity and common sense.
First of all, no one but God really understands the kidneys, the bladder and the urinary tract. All the systems of the human body are way too complex for us to even begin to understand.
But on a basic level, I can get you to understand them enough to figure out and see what’s going on, to make a good common sense decision and once you use your common sense, you’ll see that...
Real healing, true healing, is all about YOU healing YOURSELF.
237
...ALL

TAKES IS 5 DAYS!
IT

THE SOLUTION: DR. SCHULZE’S 5-DAY KIDNEY DETOX
I created my 5-Day Detox Programs as an entry level cleanse for all my patients. This program is an EASY cleanse that anyone can do.
My 5-Day KIDNEY Detox, which includes my Kidney/Bladder Flush Drink and my Kidney/Bladder Herbal Formulae, have many healing benefits to your urinary system.
The citrus juices in the kidney flush not only supply you with needed electrolytes, but also alkalize your blood, which is proven to dissolve uric acid crystals and even kidney stones. They also help flush out mucous and are diuretic, making you urinate more.
Just by consuming all this liquid, you are literally flushing the kidneys out. Just by urinating more, you can remove infections and stones in the kidneys and bladder. This is very important, especially first thing in the morning, since your kidneys have been sleeping and near dormant all night long. In the morning, you most likely have a higher bacteria count and higher level of sediment in your kidneys, than any other time.
This flush is based on a wonderful old drink by Stanley Burroughs (known as the Master Cleanser) that was successful in helping thousands of people heal themselves of many different diseases.
The citrus juices contain citric acid, but apple cider vinegar contains acetic acid and can be used as a replacement if you cannot get good quality fresh citrus fruit. The apple cider vinegar
239
CHAPTER 24
The Solution: Dr. Schulze’s 5-Day KIDNEY Detox
must be raw, organic, and unfiltered (like Bragg’s or Spectrum). It will have the same action.
The herbs in my K-B Formula and my K-B Tea have three major actions—diuretic, disinfectant and dissolving. Herbs such as Uva Ursi Leaves, Juniper Berries, Corn Silk, Horsetail Herb, Parsley Root, Carrot Tops and others in the formula have been used for centuries as diuretics (herbs that make you urinate more). Even today, this action is listed in medical and chemistry books for most of these herbs. Some of these herbs, like Juniper Berries and Uva Ursi Leaves, contain phytochemicals like volatile oils that are also powerfully disinfectant and destroy bacteria that lives in your kidneys and bladder, healing kidney and bladder infections. Herbs like Hydrangea Root and Gravel Root are famous for their ability to dissolve kidney stones. So, the Kidney/Bladder herbs make you urinate more, disinfect the kidneys and bladder and dissolve and flush out any sediment, before it turns into rocks. And if you already have rocks, it starts breaking them down and dissolving them.
How To Do Dr. Schulze’s 5-Day KIDNEY Detox
YES, I designed my 5-Day KIDNEY Detox to be done during the week, at work or during your regular weekly routine. Look, nobody wants to do a cleanse or detox on the weekend, and usually if you are silly enough to plan it that way, the phone rings, friends or relatives call, and the next thing you know you’ve blown it. With weekend fun, friends and parties, eating is a big part of it all. During the week, you are all very busy at work. You can do this program at work and you will hardly even notice that you’ve done it—IT WILL FLY BY. You might even set an example for a few of your co-workers, who would be nicer people with their kidneys and bladders cleaned out.
240
The Solution: Dr. Schulze’s 5-Day KIDNEY Detox
5-DAY DETOX DAILY ROUTINE:
DO THESE 8 STEPS EVERY DAY!
STEP 1: Upon arising, drink 8 oz. of distilled or purified water.
STEP 2: Prepare and drink the Kidney/Bladder Flush Drink. (See How to Make Dr. Schulze’s Kidney/Bladder Flush Drink on page 242.)
STEP 3: 15–20 minutes after drinking your Kidney/Bladder Flush Drink, drink two cups of K-B Tea. (See Dr. Schulze’s K-B Tea directions on page 252.) Put 2 droppersful of my K-B Formula in each cup of tea (consume total of 4 droppersful) or have the tonic separately in 1-oz. of water.
STEP 4: Finally, take 3 droppersful of my Detox Formula. This formula is my strongest tasting, so you can put it in a little grape juice if you wish.
STEP 5: One hour later, drink your SuperFood Plus Morning Nutritional Drink.
SuperFood Plus Morning Nutritional Drink Directions:
In a blender, mix 8 ounces of organic fresh fruit juice, 8 ounces of pure water, 1/2 cup of fresh organic fruit and 2 tablespoons of SuperFood Plus.
STEP 6: Repeat the same dosage of the K-B Tea and K-B Formula two more times during the day.
STEP 7: Repeat the same dosage of my Detox Formula four more times during the day, consuming a total of 3 droppersful, five times a day.
STEP 8: Continue with the Food and Juice Program as outlined on pages 246 and 247.
241
The Solution: Dr. Schulze’s 5-Day KIDNEY Detox
HOW TO MAKE DR. SCHULZE’S 2- MINUTE KIDNEY/BLADDER FLUSH DRINK
#1: Put these ingredients in a blender:
� 16-32 oz. of distilled or purified water
� Juice of 1 lemon and 1 lime
� A pinch of Dr. Schulze’s Cayenne Powder or 5–20 drops of Dr. Schulze’s Famous Cayenne Tincture

� Optional: A small amount of maple syrup to taste
#2: Blend on high speed for 10–15 seconds.
#3: Consume the drink.
� NOTE: It only takes me 60 seconds to make my Kidney/ Bladder Flush Drink in the morning. Drink the flush down in 2–3 minutes. Don’t sip it.
#4: After drinking your flush drink:
� 15–20 minutes after drinking your Kidney/Bladder Flush, drink 2 cups of previously prepared K-B Tea (see directions on page 252). Put 2 droppersful of my K-B Formula in each cup of tea (consume a total of 4 droppersful) or have the tonic separately in 1 oz. of water.

242
Kidney Stone Dissolving Routine
This routine takes two days and can be repeated. Take a stainless steel pot and fill it with 3 quarts (96 oz.) of fresh-squeezed organic apple juice. Use strong apples that have a lot of organic malic acid, ones that make you pucker (not some tasteless, politically correct, delicious apples that have little or no nutritional or medicinal benefit at all). Add 20-oz. of fresh-squeezed organic citrus juice, lemon and lime half and half is best. Then, add 10-oz. of organic, raw, unfiltered apple cider vinegar. Add one entire bottle of my K-B Formula and two entire packages of my K-B Tea. Let this mixture steep in a warm place for a whole day, stirring every couple of hours for a minute or two. If you have a real serious stone problem, add a few additional ounces of Hydrangea Root and a few more ounces of Gravel Root to this brew.
To make this formula stronger, mix all the ingredients in a blender. This will break down and smash all the herbs.
Let this sit for 24 hours and then strain through a stainless steel strainer or squeeze through a clean, cotton t-shirt. The strained formula must now be kept in the refrigerator, until it is all consumed.
The next day after it has brewed, drink 4-oz. an hour of the liquid. You can even drink an ounce every 15 minutes. Considering that you sleep eight hours and are up for 16, if you drink 4-oz. every hour that you are awake you will consume a total of 64-oz. each day; this means this brew will last you almost two days.
You will also be drinking some distilled water, up to 64-oz. a day. Only distilled water (the emptiest water) is allowed. Distilled water is so empty that it is like a vacuum. It is the universal solvent, especially for unwanted mineral deposits. Just by drinking distilled water on a regular basis you dissolve stones and prevent new ones from forming—but, when added to this routine, you’ll have a real winner.
243
5-Day KIDNEY Detox
The Solution: Dr. Schulze’s
The Solution: Dr. Schulze’s 5-Day KIDNEY Detox
DR. SCHULZE’S KIDNEY STONE
DISSOLVING FORMULA INGREDIENTS
Mix in a 1-gallon jug:
� 96-oz. Organic, Fresh-Squeezed Apple Juice
� 10-oz. Organic, Fresh-Squeezed Lemon Juice
� 10-oz. Organic, Fresh-Squeezed Lime Juice
� 10-oz. Organic, Raw, Unfiltered Apple Cider Vinegar
� One 2-oz. bottle of Dr. Schulze’s K-B Formula
� Two 4-oz. bags of Dr. Schulze’s K-B Tea

244
The Solution: Dr. Schulze’s
Patient Case History
I had literally hundreds of patients who came to my clinic with kidney stones, and all of them were able to dissolve them.
I had a man in his early thirties come to see me from UCLA Hospital, where they X-rayed him and found 19 large kidney stones. One doctor suggested kidney surgery and the other suggested the sound wave blaster that breaks up the stones. And, hopefully the stones wouldn’t get stuck on the way out, OUCH!!!
Instead, he had heard about my clinic from a friend of a friend who I helped dissolve their kidney stones—so, he came to me. I put him on my kidney stone dissolving routine, and then we did it a second time for good measure. Against my advice, he returned to the hospital about two weeks later for another X-ray—they discovered that his stones were gone, VOILA!
Remember, when dissolving any type of stone, (kidney, gallbladder or whatever) 100 small stones will dissolve faster than one large stone—just like a bag of ice cubes will melt faster than a big block of ice. So the program can be repeated as often as needed, until all the gravel or the Rock of Gibraltar... is gone.
245
5-Day KIDNEY Detox
The
THE 5-DAY DETOX FOOD
You can eat or drink anything during your 5-Day Detox, but to achieve maximum results, I suggest the following raw food and juice flush program.
Fresh fruit or vegetable juice is the best way to get your vitamins, minerals and other essential nutrients. They are also very important for cleansing and detoxification.
Day 1 & 5 (Raw Food)
BREAKFAST: If you’re hungry before lunchtime, you may have fruit, diluted fruit juice and fruit smoothies. Stop all fruit and fruit juice at least one hour before lunch. It is best not to mix fruits and vegetables, while on this program.
LUNCH: For lunch, you can have fresh raw vegetable juices, raw vegetables (alone or in salads), sprouts, potassium broth and herb teas. You may use dressings for your salads and vegetables, if you like—use olive oil, avocado, raw apple cider vinegar, lemon juice, garlic, onions and any herbs and spices.
AFTERNOON SNACKS: Raw vegetables, raw vegetable salads, diluted vegetable juices, sprouts, potassium broth and herb teas. All vegetable foods and juices must be stopped by 6pm.
DINNER: Diluted fruit juices, fruit, fruit smoothies, fruit salads and herb teas.
Days 2, 3 & 4 (Juice Flush)
Now, we begin the 3-day fast. Consume at least one gallon (128 ounces) of liquid a day. That’s eight 16-ounce servings a day. If you get hungry, DRINK MORE LIQUID!!!
MORNINGS: Start with water, your morning flush, herbal teas/tonics and your morning SuperFood Plus drink.
246
Detox
Solution: Dr. Schulze’s 5-Day KIDNEY
The Solution: Dr. Schulze’s 5-Day KIDNEY Detox
AND JUICE PROGRAM
MID-MORNINGS: Diluted fruit juices, herb teas and water until noon.
AFTERNOONS: Diluted vegetable juices, potassium broth, herb teas and water until evening.
EVENINGS: Diluted fruit juice, herb teas and water in the evening.
Day 5 (Raw Food)
Day #5 is the day you will be breaking your fast. Your food program will be the same as Day #1. Breaking your fast is a very important part of this program. Chew your food slowly, mixing each mouthful with plenty of saliva. Eat until you are satisfied, not full. You can always eat more later, if you are still hungry. Chew everything to a liquid pulp.
POTASSIUM BROTH RECIPE
This is a great-tasting addition to any 5-Day Detox program. It will flush your system of toxins, acid and mucous while giving you concentrated amounts of minerals.
Fill a large pot with:
� 25% Potato Peels
� 25% Chopped Whole Beets and Carrots
� 25% White Onions and Garlic
� 25% Dark Greens
Add hot peppers to taste. Add enough distilled water to just cover vegetables and simmer on very low temperature for 1–4 hours. Strain and drink only the broth. Make enough for two days, and refrigerate the leftover broth. Use only organic vegetables! We do not want to consume any toxic, immune suppressive insecticides, pesticides or inorganic chemical fertilizers while we are on a detoxification program.
My broth will flush you out and build you up. Start it now!
247
FOOD

“In 5 days, you’ll feel HEALTHIER, FEEL BETTER and have MORE ENERGY than you’ve had in YEARS!”
— Dr. Richard Schulze
CHAPTER 25
DR. SCHULZE DESCRIBES HIS HERBAL FORMULAE
Flush, cleanse and detoxify your kidneys and bladder and promote healing.
K-B Formula

� Fights urinary tract infections
� Diuretic and disinfectant for the kidneys and bladder
� Prevents kidney stones
� Combats incontinence
Botanical Ingredients:
Uva Ursi Leaf, Juniper Berry, Horsetail Herb, Burdock Root, Corn Silk, Parsley Root
This tonic is both diuretic (increases the flow of urine) and disinfectant (destroys urinary tract infections) to the kidneys,
249
bladder and urinary system. Although this action has been known and reported since the beginning of recorded herbal medicine, modern medicine has finally filled its medical books documenting this powerful medicinal action.
Whenever I used these formulae in my clinic, they cured every patient with a urinary tract infection, even after antibiotics had failed. It worked 100% of the time. This formula works best if used along with the K-B Tea and the Kidney/Bladder Flush Drink.
Metabolic Action And Botanical Chemistry

Uva Ursi Leaf contains powerful phytochemicals, such as volatile oils, arbutin, quercetin and malic and gallic acids. Arbutin is highly antibacterial and destroys bacteria and fungus that infect the urinary system such as E. coli, candida albicans, staphylococcus, etc. One of the ways Arbutin does this is by releasing aglycone hydroquinone and other phytochemicals into the urine. Quercetin is a capillary protectant, protecting the literally trillions of capillaries existing as part of the delicate kidney-filtering system. Malic and gallic acids (the same as found in apples and apple cider vinegar) have long been used for kidney and bladder infections.
All of the other herbs in this formula contain phytochemicals that are either diuretic, anti-microbial or anti-inflammatory to the entire urinary system.
250
Dr. Schulze Describes His Herbal Formulae
Uva Ursi Leaf
K-B Tea

� Fights urinary tract infections
� Diuretic and disinfectant for the kidneys and bladder
� Helps dissolve kidney stones
� Soothes the urinary tract
Botanical Ingredients:
Juniper Berry, Corn Silk, Uva Ursi Leaf, Parsley Root, Horsetail Herb, Goldenrod Herb, Hydrangea Root, Gravel Root, Marshmallow Root, Orange Peel, Peppermint Leaf
A mild-tasting, but powerfully effective tea. It is both diuretic and antiseptic to the entire urinary tract. It soothes urinary tract inflammation and also dissolves kidney stones and renal gravel.
This formula has all the actions of the K-B Formula (though slightly milder), and also contains additional herbs for reducing inflammation in the urinary tract and for dissolving kidney stones and renal calculi.
251 Dr. Schulze Describes His Herbal Formulae
Metabolic Action and Botanical Chemistry
The herbs in this formula have the identical action as the K-B Formula plus the addition of Hydrangea Root and Gravel Root, which are used specifically for dissolving kidney stones and renal calculi.
Juniper Berries are by far my favorite kidney and bladder herb. I used them in every clinical Kidney/Bladder Formula that I ever made. I found them to be the diuretic herb that always worked and a urinary disinfectant that worked even on the most stubborn cases. I believe this is due to their wonderful essential and volatile oils. They worked miracles in my clinic, but are not officially recognized for any of the above uses, but, Uva Ursi is.
How To Make K-B Tea
Directions to start the tea:
Put 6 tablespoons of this tea into 60-oz. of distilled water. Be sure to use only stainless steel or glass cookware. Let the tea sit in the water overnight. In the morning, heat it to a boil, reduce heat, and let simmer for one minute. Strain the herbs; do not discard them.
Let the tea cool a bit, but use it hot. This will give you enough tea to drink two cups, three times during the day. If you are planning to drink the tea for more than one day, put the used herbs back into the pot, adding three tablespoons of fresh herbs and 60-oz. of distilled water. Let sit overnight and repeat the whole process. Keep adding new herbs to the old ones for three days. Then, discard all herbs and start over.
252 Dr. Schulze Describes His Herbal Formulae
Detox Formula

� The most powerful DETOX formula available anywhere
� Cleans accumulated toxins and poisons out of the body’s blood and lymphatic system
� Promotes healthy skin and complexion
Botanical Ingredients:
Red Clover Blossom, Mojave Chaparral Herb & Resin, Oregon Grape Root, Burdock Root, Yellow Dock Root, Poke Root, Goldenseal Root, Fresh Garlic Bulb, Lobelia Herb Seed, Habanero Pepper
Some of the botanicals in this “politically incorrect” herbal formula have been vigorously attacked by our federal government and medical groups for the past century, and especially within the past 10 years. These “gifts from God” have created everything from Senate hearings, witch hunts, raids by government agencies and vicious AMA attacks to having American herbalists and naturopathic physicians thrown in jail, and even exiled from the country. What are they so afraid of? I’d say that speaks for itself. Some of these herbs have been illegal to use, like Chaparral, which was outlawed for almost five years. Suppliers stopped selling it and herbalists sucked-up politically. Instead, I harvested my own in the California deserts and continued to use it. After all, in my clinic, potent healing ability dictated
253
Describes His Herbal Formulae
Dr. Schulze
which herbs I put in my formulations and used with my patients, NOT politics. How could I look a patient in the eye who was suffering and tell them that I know what helps, but legally I can’t sell it to you? Because I continued to use this herb during its prohibition, this became just one of the reasons my clinic was shut down. Other botanicals in this formula, like Lobelia Seed, Poke Root, and even Red Clover Blossoms, are highly discouraged by medical doctors. Consequently, many herbalists (myself included) have been arrested and incarcerated for even discussing the benefits of these types of herbs, because of their association with treating cancer and chronic disease. Having said all of this, I must tell you that the herbs in this formula are classic and traditional blood and lymph-cleansing tonics and the ones that I used successfully for many years in my clinic. Every patient in my clinic consumed one entire bottle of this formula when doing one of my 5-Day Detox Programs.
This formula is based on the famous Hoxey Formula, Dr. John Ray Christopher’s Red Clover Combination (both herbalists were arrested on numerous occasions for these formulations) and many similar powerful alternative (blood cleansing) formulae from around the world. These herbs are used in herbal medical clinics worldwide for scrubbing the accumulated toxins and poisons out of the body’s blood, fat and cells, and also heralded for their efficacy.
Metabolic Action And Botanical Chemistry
The following is common knowledge from highly respected and accepted medical text. According to pharmacology manuals, Chaparral contains nordihydroguaiaretic acid. According to the Merck Manual, one of the most respected medical chemical books in the world, the acid from Chaparral is listed as an antioxidant with a therapeutic category as an antineoplastic. According to Taber’s Cyclopedic Medical Dictionary, an antineoplastic is “an agent that prevents the development, growth and proliferation of malignant cells.”
254
Describes
Dr. Schulze
His Herbal Formulae
255
Dr. Schulze Describes His Herbal Formulae

“Your body has the ability to completely HEAL ITSELF of ANY disease… All it needs is your assistance.”
— Dr. Richard Schulze
Final Thoughts
FINAL THOUGHTS ON KIDNEY DETOXING
Remember, the people who don’t get well using Natural Healing, don’t get well, because they didn’t do enough... not because they did too much.
When building a house, you need lots of different tools. To start, you need large powerful bulldozers to grade the site level and dig the trenches for the foundation. Then, you need concrete mixers, sledge hammers, big heavy framing hammers, table saws and hand-held power tools to build the frame of the house. Finally, for the finish work you need more delicate tools like small screwdrivers, pliers, small finish hammers, sandpaper and paint brushes.
In my clinic, I created numerous natural healing and herbal tools, some small tools, some medium tools and some real BIG and STRONG tools. In my clinic, I learned the importance of picking the right tool for the job and of having a variety of tools. I needed my big powerful Natural Healing routines and herbal medicine tools for the big jobs (like my Incurables Program), to help my patients heal their serious and life-threatening diseases. I also needed an assortment of finishing and maintenance tools (like my 5-Day Detoxes and SuperFood Plus) to help my patients build healthy and strong bodies and to keep them healthy for years to come.
Since my clinic is closed and I’m not there to personally guide you along on your healing journey, when in doubt, do my programs more intensely, and for a longer period of time.
257
CHAPTER 26

“The main function of your body is to constantly heal and repair itself... REPAIR YOU!”
— Dr. Richard Schulze
Frequently Asked Questions
FREQUENTLY ASKED QUESTIONS
The following are the most commonly asked questions and concerns about kidney cleansing.
The color of my urine used to be bright yellow. Now it’s sort of a yellowish-orange. Is that normal, or does it mean something’s wrong?
If your urine has changed to a yellowish-orange, the first thing I would ask is if you’re taking SuperFood Plus. SuperFoodPlus has three to four to five times the B-Vitamins you need for the whole day. One of the things that is a component of B-Vitamins is they have a yellowish-orange color—and, when you take SuperFood Plus, it doesn’t matter, your urine will turn yellowishorange. So, it may be that you’re just a SuperFood-a-Month customer, and you’re noticing that your urine is getting darker. Another one of the components of SuperFood Plus is beets, and if you sit down and eat a nice plate of raw beets one evening (grated raw beets), you’ll notice that the next time you urinate, it’ll be red. You’ll think you’re bleeding from your kidneys. It’s just the Beta-Carotene. SuperFood Plus is one of the highest sources known of Beta-Carotene (which is a coloring) and also of B-Vitamins. And both of those things will make your urine change from yellow to orange (if not fluorescent), when you’re urinating. So if you’re a SuperFood-a-Month member, “No worries,” as my friends in Australia would say. If you’re not a SuperFood-a-Month member, you need to be. Because any time your body changes, it’s something you want to notice. Everything that changes in you as you grow and age is either changing for
259
27
CHAPTER
the better or for the worse. If you’re doing nothing and you’re just getting older, it’s changing for the worse. You’re starting to rot or break down, your body isn’t working as well. On the other hand, if you notice a change that looks very similar, but it’s because you’re drinking lots of carrot juice and exercising and loving yourself— well, then that’s a positive change.
People used to always ask me in my clinic, how do I know if it’s a healing crisis or a disease manifestation happening to me? Because, the symptoms can look the same. They could be vomiting green bile and having parasites coming out of their ears. There’s only one way to know. You have to ask yourself, what did I do last night? What did I do last week? Did I party-hardy? Did I go to a bachelor party? Did I drink a keg of beer, eat a box of frozen pizza, eat all this garbage food, stay up all night and do this for weeks? Have I been partying? Or did I just buy a juicer, and have I been juicing every fruit and vegetable I can get my hands on? Have I been exercising and taking long walks every day, doing deep breathing and loving myself? The symptoms can look identical. Whether it’s a disease or a healing, is based on what you’ve been doing. And, that should help you with the change in the color of your urine.
What is the normal amount of urine one should eliminate every day?
Normally, a person should urinate about four to six times a day.
This amount can vary greatly depending on the amount of liquids you consume, how much you weigh, how much you are exercising, breathing, sweating, etc. The average person eliminates between one and two quarts of urine a day. Any change in the amount of urine excreted can be a sign that something is wrong with the Urinary System.
260 Frequently Asked Questions
I suffer from chronic bladder infections. A friend told me that bladder infections can be caused by holding your bladder for too long and can also lead to more serious problems. Is this true?
First, no one should ever hold their bladder. I’m not saying that your bladder infection is from holding your urine too long—but, no one should hold their elimination ever for any reason, whether that’s bowel elimination, bladder, or urine elimination, whether that’s gas from the rear end or the front end, sneezing, or anything... Never, ever, ever, ever, ever suppress your body’s elimination. In fact, a fundamental of the Dr. Schulze program of how to heal yourself of anything is stimulating and increasing the amount of elimination that comes out of your body. The worst thing anybody can do is to suppress their elimination, that includes suppressing your urine. Holding on to your urine can certainly stretch your bladder and cause scarring infection.
The flow of urine is one of the simplest, natural immune functions of your body to keep your urinary tract, kidneys and bladder from getting infections. If you want to guarantee a fast infection of the kidneys and bladder, all you have to do is stop someone’s urine flow. Naturally flowing urine moving out of the body washes bacteria, parasites and all types of harmful micro-organisms out of your kidneys and bladder, before they have a chance to develop and grow into anything that can hurt you. So your elimination system (which flushes your body continuously) is one of the primary functions of your immune system that keeps you from getting diseased. Also, you have to realize that all infections (especially chronic ones like this person is talking about) cause heat and inflammation. And, heat and inflammation cause scarring. So, any chronic infection of the kidneys and bladder will cause scarring. So, I’m agreeing with this person.
The best way to get rid of any kidney or bladder infection (whether it’s acute or chronic) is to increase your flow of urine (which is what a diuretic does) and destroy the bacteria—that’s what the Kidney/
261 Frequently Asked Questions
Bladder formulas do. Just Juniper Berry alone has volatile oils that destroy bacteria in the urinary tract, and at the same time this wonderful plant causes you to urinate more. It’s a diuretic. Uva Ursi (my second favorite herb in both the formulas) is not only a diuretic (which increases the amount you urinate, so it’s going to flush that bacteria out sooner), but it also has essential oils that kill bacteria in your urinary tract. And, it’s famous for doing that. So, the two main functions of the herbs in these formulas is to help you urinate more frequently and to destroy the bacteria that lives in your kidneys and bladder.
I should also point out here that the number one cause of bladder infections is e.coli bacteria, and e.coli bacteria, of course, is the bacteria that is from our intestinal tract. So, two things that I always told my patients about, primarily my ladies... this may sound overly simple, but you would be surprised at the amount of women in my clinic that after they peed wiped from back to front after they eliminated. You can’t do that without getting e.coli bacteria from your rectum around your vagina and your urethra. So, you don’t ever wipe from back to front. I know for some of you that are laughing right now that sounds like common sense—but again, I used to have to instruct many of my ladies on how to wipe, after they had eliminated.
Secondly, for men and women, a very important way that people could eliminate the vast majority of kidney and bladder infections is to urinate after sex. During sexual activity, it is very common for e.coli bacteria around the genitals to get into the opening of the urethra, whether it’s a woman or a man. And bacteria move, and right up that urethra into your bladder. A great way to get rid of e.coli bacteria after sexual intercourse is to just urinate. And, all I can say is that those who urinate after sex rarely, if ever, get a bladder or kidney infection, due to e.coli bacteria.
If I could say one more thing, garlic is our sulfur plant. It contains over eighty known sulfur compounds. Remember that it was the drug of choice for doctors for urinary tract infections— nowadays, they use synthetic sulfur. I say, how about just using
262 Frequently Asked Questions
God’s sulfur, which is definitely garlic. And I suggest three raw cloves a day eaten at different times, breakfast, lunch and dinner, for anyone that has a kidney or bladder infection to augment my 5-Day KIDNEY Detox.
I have had chronic kidney infections my whole life. Can your program really help?
In the three decades that my clinic was open, I literally treated thousands and thousands of patients for kidney infections. For some, it was their first infection—for many other people, they had experienced chronic kidney infections their whole life and had finally made it into my clinic doors. In either case, acute or chronic, people should know that my 5-Day KIDNEY Detox, which includes my K-B Formula, K-B Tea and Detox Formula, along with my Kidney/Bladder Flush Drink, always worked 100% of the time. Whether it was a person’s first kidney infection or their hundredth kidney infection, it always worked! I had patients with kidney infections that were so raging, that no drugs that a team of medical doctors had prescribed worked at all.
I remember the first time a particular patient of mine followed my 5-Day KIDNEY Detox. In their own words (which they left on the answering machine in my clinic), “My kidney and bladder infection that no doctor and no drug could heal was completely healed after just doing your five-day program.” Kidney infections are not so difficult to get rid of.
For years, medical doctors used sulfur drugs until, they realized that the sulfur drugs were destroying other parts of your body and ruining your health. Today, they prescribe synthetic sulfur drugs, which just hurt you in a different way, as they’re trying to deal with your kidney infection. Herbs are the safest and most powerful way to heal any infection of the urinary tract. They work in a number of ways, but mostly by killing the bacteria and increasing your flow of urine (which naturally just reduces the bacterial or infection count in your urinary tract). So, to keep this simple and to the point, anybody reading this who’s got a kidney
263 Frequently Asked Questions
infection gets the Dr. Schulze guarantee that if they follow my 5-Day KIDNEY Detox (along with my Kidney/Bladder Flush Drink), their kidney infection will be gone. I’ve never had an exception to this rule in all the years that I saw patients with kidney infections in my clinic.
Recently I have been having a terrible time holding my bladder. I understand this happens with old age but I refuse to start wearing diapers. Is there anything I can do about it, or is it too late?
My first thought is, don’t accept old age. Yes, there is something that you can do about it. It’s called getting healthy. Some people call it reversing the aging process. Get on all of my programs. I often say to people, start with SuperFood Plus, end up with Air Detox, and do everything in between. Obviously, you would do the Kidney/Bladder Flush, the whole 5-Day KIDNEY Detox with the kidney and bladder herbs and my Detox Formula.
You may have an infection. Often, infections cause people to urinate more frequently and not be able to hold their bladder. This will make sure that if you have an infection, you will get rid of it. And, create a healthy lifestyle, just like the people need to in the previous question, that have infections. Create a healthy lifestyle, and you will reverse the aging process—your bladder will get stronger and you will disinfect your urinary tract. One of the reasons people have a hard time holding their bladder is because of the amount of toxins that come out in the urine. People go, “Well, where do all these toxins come from?” Well, I can tell you. They come from you. They’re going into your mouth, from your hand and your arm. They’re what you’re eating and drinking, especially drinking drinks like sodas, habitual coffee use and alcoholic beverages.
Some people out there who read this know that after a night of partying, you wake up in the morning and you urinate and it burns like you’re pissing fire. And, it’s because of all the toxins that are in your urine at this point.
264 Frequently Asked Questions
So, by creating a healthy lifestyle, your urine will be less toxic, your bladder will be less irritated and you will find that you won’t need to start buying diapers.
I have a kidney stone lodged way down in my urethra. Will your kidney flush dissolve it?
Yes. My 5-Day KIDNEY Detox, which includes my Kidney/ Bladder Formula, Kidney/Bladder Tea, and with my Detox Formula, along with my Kidney/Bladder Flush Drink and also my Kidney Stone Dissolving Program will dissolve any stone, whether it’s in your kidneys, bladder or stuck in your urethra. And, if it’s really stuck in your urethra, I know that no pain in life seems to come close to the pain of a kidney stone stuck in your urethra. So, don’t be afraid to use my Nerve Formula, which will reduce the pain and keep you relaxed. That will keep your urethra and body from continually having spasms, when the stone is in there. But, you need to do my kidney stone dissolving routine repeatedly, until you have no stones in your kidneys, urethra or anywhere. And, get to work.
What do hyper-cholestemia (high cholesterol) and hypertension (high blood pressure) have to do with kidney disease?
Your kidneys and bladder may be congested, overloaded and plugged, because your food program is too high in animal foods. This causes hyper-cholesterolemia (high cholesterol levels), which in turn causes hypertension (high blood pressure). High blood pressure causes almost half of all kidney disease.
Your kidneys have a much harder time filtering out thick, fatty blood, than filtering out thinner blood. This is just basic physics. Try pouring water through a coffee filter. Now try pouring it and filtering ice cream or cheese. Not very easy, is it? Saturated fat from animal foods makes your blood very thick, increasing your cholesterol level, and therefore making it very difficult for your kidneys to filter your blood. In fact, it will clog the tiny
265 Frequently Asked Questions
filtering capillaries and nephrons in your kidneys, rendering them incapable of filtering anything.
This fatty blood is also much harder for your heart to pump around your body, so your heart has to increase its pumping force (your blood pressure). Again, this is basic physics. If you are pumping water through a pipe 100 feet long and now you want to pump cheese instead, it will take more pressure to pump a thicker mass. This causes high blood pressure and higher pressure ruptures and hemorrhages the tiny capillaries and microscopic parts of your kidney’s filtering system, scarring them and eventually killing you.
What is diabetes, and HOW does it affect the kidneys?
High blood sugar, diabetes, causes almost the other half of kidney disease that high blood pressure doesn’t. There are many known ways in which high sugar hurts the kidneys, and many additional theories. Again, the microfiltration systems of the kidneys are very fragile to blood viscosity, pressure, toxic waste and severe blood imbalances, like diabetes. Diabetics have excessive urination, hence the name diabetes (from the Greek meaning passing through). These comprise just some of the reasons being a diabetic can rupture, break down and scar your delicate kidney filtering microparts and render them, at first, incapacitated, and eventually incompetent and dead.
In my clinic, I treated hundreds of diabetics, all of whom, if they were willing to go far enough, got their diabetes under control and off of any insulin with a healthy food program, exercise and routine cleansing and detoxification programs.
If you’re a diabetic and you’ve managed to stay off insulin, then now is the time to try my Incurables Program. But understand that my program should be a constant celebration, make sure that you love every little bit about it. Everything you do, you should do with a smile on your face. Celebrate every breath and every thing you put in your mouth. Savor the herbal tonics, like they’re the finest French wines.
266 Frequently Asked Questions
Will diabetes begin to damage your kidneys? Of course, it will. Diabetes will destroy your kidneys—medical doctors will tell you that in the long run your kidneys would be better off, if you took insulin. No, in the short run, they’d be better off. Because if you take insulin, in the short run, your kidneys might be slightly relieved, because your blood sugar is regulated. But in the long run, the first thing you’re going to do is kill your pancreas— because the minute your pancreas detects that you’re taking insulin, it will quit making insulin for you, forever. So now, you’re addicted to insulin. And in the long run, anybody who is diabetic and on insulin knows that eventually they’re kidneys get destroyed anyway. So your kidneys are going to be destroyed following the medical protocol, no matter what you do.
My suggestion would be to get off your ass and create a lifestyle that is so damn healthy that your pancreas starts working again, and you get rid of your diabetes. Not struggling, managing or trying to cope with it, but really healing yourself. Thousands of people have healed themselves of diabetes with my programs. Yes, Type 1 and Type 2. I saw hundreds of them in my clinic. I see them at my natural-healing seminars. They’re on my videos. So, stop struggling and suffering—get to celebrating and healing yourself.
Can I really get off dialysis, even though my second kidney has given out? Is there any way I can recover?
If you’re wondering if, after your kidneys have failed, whether you’ll be able to wake them back up... absolutely. I have seen every organ, especially ones that doctors declare are dead, come back alive with natural healing and herbal treatment. I’ve had numerous patients that were on dialysis because of kidney failure—by changing their lifestyle and their food program, along with putting them on herbal programs and natural healing routines, we got the kidneys working again. It’s not over. That’s all I can tell you—it’s not over.
I’m always impressed when people don’t get it, when their first kidney quits. You think that would be the wake-up call, but
267 Frequently Asked Questions
for many, it isn’t. If you let the second one quit, then you’re on dialysis—this means you have your blood drained entirely out of your body two or three times a week, have it filtered, and chemicals dumped into it. If this is you, then the first thing I want to tell you is that any function that your body turns off, you can turn right around and turn it back on. If a kidney stops working, you can get it to work again. If two kidneys stop working, then you can get them both to start working again. At every natural healing seminar that I can remember, someone has told me that they got off dialysis and got their kidneys working again. So, many people have been told by medical doctors that, well, their bone marrow that was once red and alive is now yellow and fatty, and they can’t build new immune cells. Hogwash. Well, I’m sorry, but this infection, there’s nothing we can do about it. Hogwash. I’m sorry, your arteries are so clogged, the only thing that will help is to do a coronary bypass surgery. Hogwash. I had so many patients that were told by chief oncologists at the best hospitals that they’d be dead in two weeks, because their third bout with cancer was taking them out—and, they’re still alive today. Anything is possible. Tomorrow is what you do and believe today. And, that means also getting off of your dialysis.
Never give up on yourself. Never give up on a failed organ. Create your greatest healing environment, and your body will heal itself by turning these organs back on. I always say STOP doing what you did that made you sick, and START doing what will heal you. In this case, stop doing what you did to make your kidneys stop working and start doing what’s going to turn your kidneys on again, and get them working, healed and strong.
What should I do to prepare for my program?
The best way to do it is to prepare for about two to four weeks before doing the cleanse. And the minimum, you should be doing for those two to four weeks is my Intestinal Formula #1 and Intestinal Formula #2 to get your bowel clean and working efficiently. And, of course, the second thing would be getting on a good food program.
268 Frequently Asked Questions
While you’re preparing for your cleanse, start leaving out the foods that you know aren’t helping you—start introducing more of the fresh fruits, vegetables, sprouts, legumes and grains that you know are going to heal you and build your body.
After you get on a good food program, start exercising, increase your exercise routine, try some new types of exercise and remember to work on that emotional program a little bit. Start loving yourself more and do some positive affirmations. If you do that for the first two to four weeks, then when you begin your cleanse, you’ll get 10 times more out of your cleanse and your detoxification, than if you don’t get healthier first.
Can you modify the Kidney/Bladder cleanse?
Well, I never really expected anybody to follow exactly what I said, anywhere. You would have to be a robot to follow it. All I want you to do is do your best. Of course, the times can be modified. They can be modified to your lifestyle and your workplace, because you’re probably doing the cleanse at your workplace. What I would like you to think about is, by the end of the day, I would like you to have consumed all the foods, juices, herbs and herbal formulas that I suggested. And, space them out as much as possible.
Do you have to follow my program down to the minute or the hour? No, you don’t. And, you’d probably have a very hard time doing that. In fact, any patient that follows my programs to a tee, I worry about them. They may be a little bit neurotic. Sure, modify it to where it works with your life.
The bottom line is I want you to do it. You’re never going to get well if you look at my 5-Day Detox Program and study it, but figure I can’t ever do it perfectly, so you won’t do it at all. Do your best. That’s all I’m asking of any of you is, do your best at doing the program.
269 Frequently Asked Questions
Which should I do first, the Liver/Gallbladder or the Kidney/Bladder flush?
There’s a couple of ways to make this decision. The first has to do with your history. Have you had any problems with your liver and gallbladder? Have you had any gallbladder congestion? Do you have high cholesterol? Any history of hepatitis, or any family history of any liver or gallbladder problems? If you fall in that category, then yes, go ahead and start my 5-Day Detox Program for your Liver/Gallbladder.
On the other hand, if you’ve had kidney stones, kidney or bladder infections, frequent urination or any family or personal history of kidney or bladder problems, then you would choose with your first 5-Day Detox Program to do the Kidney/Bladder Program.
If you haven’t had any problems at all and have no family history of problems with either the liver and gallbladder or the kidney and bladder, then there’s a very simple way to decide. If your eyes are light brown or brown, then I would suggest that you do the Liver/Gallbladder Flush for the first cleanse. And if you have blue eyes, then you should start with the Kidney Flush during your first 5-Day Detox Program. And if you have green eyes, you can go either way. And then on your next seasonal cleanse, do the other program. Now, if you have problems with either one, you can do that flush for the first two or three seasonal cleanses, but at least once a year try the other flush and the other herbs. So if you do the Liver/Gallbladder Flush Drink and the Liver/Gallbladder herbs for spring, summer, and fall cleanses, then in the winter do a Kidney/Bladder Flush and herbs. You should at least do the other cleanse one time a year.
270 Frequently Asked Questions
What kind of supplies do I need to get for the cleansing?
KIDNEY FLUSH INGREDIENTS:
� 16 to 32-oz. of distilled or purified water
� Juice of 1 lemon and 1 lime
� A pinch of Dr. Schulze’s Cayenne Powder or 5-20 drops of Dr. Schulze’s Famous Cayenne Tincture
� Optional: A small amount of maple syrup to taste
� Blend on high speed for 10-15 seconds
� Consume this drink
HERBAL FORMULAE:
� 1 bottle of my K-B Formula
� 1 bag of my K-B Tea
� 1 bottle of my Detox Formula
� Dr. Schulze’s Cayenne Powder or Cayenne Tincture
TOOLS:
� Blender (any)
� 1 water glass (at least 20-oz.)
� 1 manual citrus juicer
� 1 tablespoon
271 Frequently Asked Questions
Is Juice Flushing mandatory?
Personally, if you want to get well, juice flushing is mandatory. My 5-Day Detox is two days of raw foods and three days of juice flushing. If you do it Monday through Friday, Monday and Friday are raw foods and Tuesday, Wednesday, and Thursday are juice flushing.
When you go back into the last century, you look at any of the great natural healers and you’ll see that juice flushing was a foundation of the programs they used to get well. I don’t care who you study and who you look at. All my great teachers, like Paavo Airola, Dr. Bernard Jensen and Dr. John Christopher, used juice flushing as one of their primary healing tools. We should really call it juice flushing, because what you are doing is introducing a gallon a day or more of herb teas, distilled water, and fresh juices through your body that not only give you super nutrition but also flush out unwanted acids and salts and old minerals and toxic accumulations and chemicals.
This is probably the greatest part of a Natural Healing cleansing and detoxification routine. So do not skip your juice flushing. I have seen it create miracle after miracle in the clinic. Juice flushing is what you want to be doing.
However, having said that, you do not have to do the whole program. You know, some mornings I wake up (don’t hesitate to try this) and I feel like I could use a Liver Flush, I feel a little sluggish. Or I feel like I could use a Kidney/Bladder Flush. So I make a Liver Flush Drink or a Kidney Flush Drink and I have it in the morning. And then, I just go about the rest of my day. Maybe have a SuperFood Plus drink a few hours later, and then a few hours after that I might have some lunch and then some dinner.
So the point is, never hesitate to just wake up in the morning and do a flush drink, whether it’s the Liver/Gallbladder or the Kidney/Bladder. You don’t have to do the whole program. I
272 Frequently Asked Questions
would rather see you modify the program all the way down to doing one flush drink, than not doing anything at all.
Now, certainly it’s optimum to add in the juice flushing. Some people ask this question because they have diabetes and they’re afraid to do juice flushing. Let me tell you, I have had so many diabetics, both type one and type two, do my juice flushing program. You have nothing to worry about. Just use your good smarts and your common sense, and you can do it, too. Because the program is much more powerful, both the Liver/Gallbladder and the Kidney/Bladder, if you do it with the whole 5-Day Detox, which includes my 5-Day Food Program.
273 Frequently Asked Questions
274
Dr. Schulze’s “Detoxification: A Clinical Doctor/Patient Manual” is a two volume series…
Detoxification: Volume One
Answers all questions regarding Detoxification and includes Dr. Schulze’s Three Clinical Food Programs!
Detoxification: Volume Two
Describes in detail Dr. Schulze’s 24-Hour Bowel
Detox, along with his 5-Day BOWEL Detox Program, 5-Day LIVER Detox Program and his 5-Day KIDNEY Detox Program!

For a FREE Catalog call NATURAL HEALING PUBLICATIONS at 1-877-TEACH-ME (832-2463) © Copyright 2011 Natural Healing Publications Printed in the USA on 100% chlorine and bleach-free recycled paper, with minimum 30% post-consumer waste (Really Recycled Waste) using soy-based ink. INSIDE THIS BOOK: 24-Hour BOWEL Detox 5-Day BOWEL Detox 5-Day LIVER Detox 5-Day KIDNEY Detox How to DO each of Dr. Schulze’s POWERFUL Detox Programs! DR. RICHARD SCHULZE One of the foremost authorities on Natural Healing and Herbal Medicine in the world.